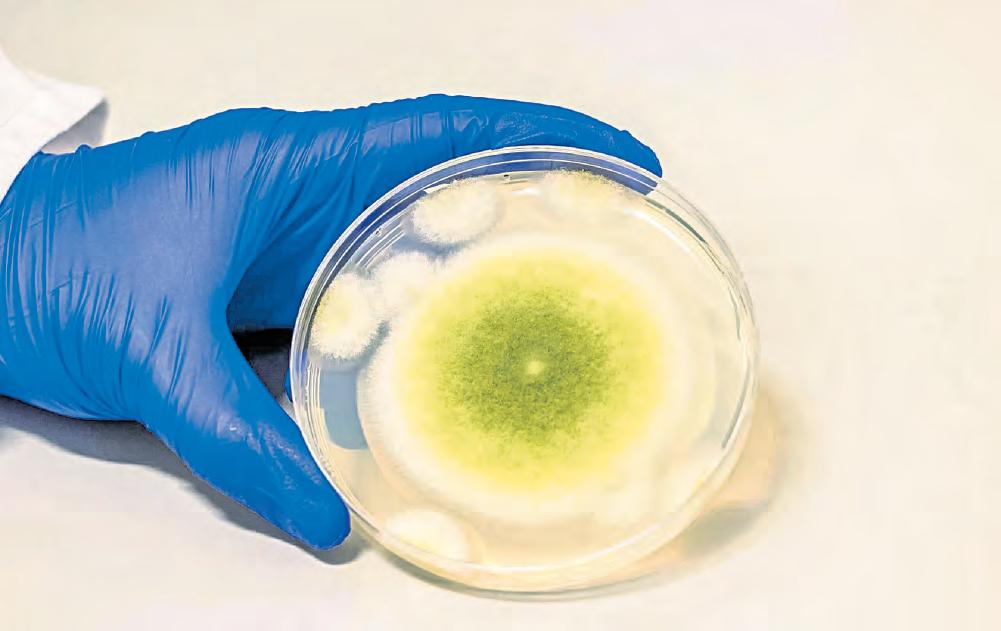

DIRECTORA GENERAL: CARMEN LIRA SAADE
DIRECTOR FUNDADOR: CARLOS PAYÁN VELVER
JUEVES 26 DE JUNIO DE 2025 // CIUDAD DE MÉXICO // AÑO 41 // NÚMERO 14709 // Precio 10 pesos
![]()
DIRECTORA GENERAL: CARMEN LIRA SAADE
DIRECTOR FUNDADOR: CARLOS PAYÁN VELVER
JUEVES 26 DE JUNIO DE 2025 // CIUDAD DE MÉXICO // AÑO 41 // NÚMERO 14709 // Precio 10 pesos
l La fiscal Pam Bondi acusa que la mitad de nuestro país “está gobernado por cárteles”
l El Tesoro prohíbe transacciones con CIBanco, Intercam y la casa de bolsa Vector
DORA VILLANUEVA, JULIO GUTIÉRREZ Y REDACCIÓN / P 3, 17 Y 19
l Argumenta que facilitan operaciones con recursos del narco por un monto de 46 mdd
Luz verde del Senado a las reformas para fortalecer el combate al lavado de dinero
● Eliminan toda referencia al financiamiento al terrorismo y envían el dictamen a San Lázaro
G. SALDIERNA Y A. BECERRIL / P 4
Con apoyo del PAN, diputados aprueban nueva ley del sistema de seguridad pública
● De PRI y MC, los únicos votos en contra; da entrada la Permanente a iniciativa para crear jueces sin rostro
F. CAMACHO, E. MÉNDEZ, A. BECERRIL Y G. SALDIERNA / P 3 Y 4



s El Departamento del Tesoro (al centro su titular) presentó como evidencia del lavado de dinero los sobornos al ex secretario de Seguridad Pública, mientras Hacienda rechaza haber recibido pruebas de nexos criminales. A su vez, las tres instituciones negaron las acusaciones (a la derecha Alfonso Romo, propietario de Vector). Fotos La Jornada y Afp
Líder de la OTAN se refiere a Trump como papito; ratifican destinar 5% del PIB a defensa
● Mark Rutte elogia al magnate por exabrupto del martes tras ataques entre Israel e Irán
● Luego de la negativa de España a elevar gasto militar, el republicano amenaza con aranceles
u El secretario general de la organización y el mandatario de EU aparecen al centro de la foto oficial de la cita en La Haya. Foto Afp

Directora General
Carmen Lira Saade
Director Fundador
Carlos Payán Velver
Gerente General
Rosalva Aguilar González
Asistente de la Dirección
Guillermina Álvarez
COORDINACIONES
Información General
Rosa Elvira Vargas
Redacción
Fabiola Santos Morales
Opinión
Luis Hernández Navarro
Arte y Diseño
Francisco García Noriega
Tecnología y Comunicaciones
Lizandro Rodríguez Bárcena
Publicidad
Javier Loza Hernández
JEFATURAS
Economía
Roberto González Amador
Mundo
Marcela Aldama
Capital Miguel Ángel Velázquez
Cultura
Pablo Espinosa
El Correo Ilustrado
Socorro Valadez Morales
Año 41, número 14709, 26 de junio de 2025, La Jornada es una publicación diaria editada por DEMOS, Desarrollo de Medios, S.A. de C.V. con domicilio en Avenida Cuauhtémoc 1236, Colonia Santa Cruz Atoyac, Alcaldía Benito Juárez, C.P. 03310, Ciudad de México. Teléfonos 55 9183 0300 y 55 9183 0400. Página electrónica del periódico: http://www.jornada. com.mx y dirección electrónica: comentarios@jornada.com.mx. Editor Responsable María del Carmen Lira Saade, Directora General. Certificado de Reserva de Derechos al Uso Exclusivo del Título No. 04-1984-000000000571-101; ISSN 0188-2392, ambos otorgados por el Instituto Nacional del Derecho de Autor. Certificado de Licitud de Título número 2387 y Certificado de Licitud de Contenido número 1616, otorgados por la Comisión Calificadora de Publicaciones y Revistas Ilustradas de la Secretaría de Gobernación. Impresión: Imprenta de Medios, S.A. de C.V. con domicilio en Avenida Cuitláhuac 3353, colonia Ampliación Cosmopolita, Alcaldía Azcapotzalco, C.P. 02670, Ciudad de México, teléfonos 55 5355 6702 y 55 5355 7794, Fax: 55 5355 8573. Distribución: en el interior de la República y el extranjero por Distribuidora y Comercializadora de Medios, S.A. de C.V. CENTRAL DE SUSCRIPCIONES, con domicilio en Avenida Cuitláhuac 3353, colonia Ampliación Cosmopolita, Alcaldía Azcapotzalco, C.P. 02670, Ciudad de México, teléfonos 55 5541 7701 y 55 5541 7002. Distribuido en la Ciudad de México por la Unión de Expendedores y Voceadores de los Periódicos de México, A.C., con domicilio en calle Guerrero número 50, Colonia Guerrero, Alcaldía Cuauhtémoc, C.P. 06350, Ciudad de México, Teléfonos; 55 5591 1400 y 55 5535 1361. Este número se terminó de imprimir el 26 de junio de 2025, con un tiraje promedio de 146,429 ejemplares.
Las opiniones expresadas por los autores no necesariamente reflejan la postura de Demos, Desarrollo de Medios, S.A. de C.V. ni del editor responsable de la publicación.
Queda estrictamente prohibida la reproducción total o parcial de los contenidos e imágenes de esta publicación por cualquier medio, sin previa autorización expresa de DEMOS, Desarrollo de Medios, S.A. de C.V.
El Departamento del Tesoro de Estados Unidos anunció que emitió acciones contra CIBanco, Intercam (bancos comerciales) y Vector (casa de bolsa), instituciones financieras mexicanas clasificadas como “una preocupación principal en materia de lavado de dinero en relación con el tráfico ilícito de opioides, debido a su patrón de larga data de asociaciones, transacciones y prestación de servicios financieros que facilitan el tráfico ilícito de opioides por parte de cárteles con sede en México”. Según el titular de ese organismo, Scott Bessent, se trata de facilitadores que favorecen el envenenamiento de innumerables estadunidenses al mover dinero para los cárteles, lo que los convierte en piezas claves en la cadena de suministro de fentanilo.
En respuesta a tales señalamientos, la Secretaría de Hacienda y Crédito Público (SHCP) reportó que su Unidad de Inteligencia Financiera (UIF) fue informada de las acusaciones por su análoga estadunidense, pero no recibió ninguna prueba que le permita actuar contra las empresas acusadas. De acuerdo con un comunicado de la autoridad hacendaria, de contar con información contundente que pruebe actividades ilícitas de estas tres instituciones se actuará con todo el peso de la ley; sin embargo, a la fecha no cuenta con datos en este sentido.
Además de la ausencia de pruebas, en el lance del Tesoro resaltan los irrisorios montos de las operaciones denunciadas: a CIBanco lo acusa de procesar 2.1 millones de dólares en pagos a empresas chinas que enviaron precursores químicos a México entre 2021 y 2024, así como de blanquear 10 millones de dólares en nombre de un miembro del cártel del Golfo; a Intercam de transferir (también entre 2021 y 2024) 1.5 millones de dólares a

Salvador Allende: la paz de un pueblo es su dignidad
El presidente chileno, Salvador Allende, nació hace 117 años. En la actualidad se siente su presencia. Es símbolo afectivo y efectivo de las luchas por la responsabilidad social del Estado, por la democracia, el socialismo, la autodeterminación de los pueblos del Sur global y la paz mundial. Su trágica muerte hace 52 años marcó las vidas de todo un pueblo en su intento por frenar en Chile
“una empresa con sede en China asociada con un individuo que enviaba precursores químicos de China a México con fines ilícitos”, además de reuniones directas entre sus ejecutivos y miembros del cártel Jalisco Nueva Generación para discutir esquemas de lavado de dinero; mientras a Vector le achaca el blanqueo de 2 millones de dólares del cártel de Sinaloa entre 2013 y 2021 y el pago de más de un millón de dólares entre 2018 y 2023 a empresas con sede en China conocidas por haber enviado precursores químicos con fines ilícitos. En suma, si todas las acusaciones son ciertas, se trataría de menos de 17 millones de dólares lavados o procesados en más de una década. Para dimensionar el carácter casi cómico de esta cifra en el gran esquema del crimen organizado trasnacional, basta con decir que el propio Tesoro estima que 300 mil millones de dólares son lavados cada año en Estados Unidos. Los 17 millones de dólares ilícitos detectados en las instituciones financieras mexicanas representan 0.0056 de dicha cifra. De acuerdo con un centro de investigación privado, sólo en 22 inversiones en bienes raíces efectuadas entre 2004 y 2024 se lavaron 2 mil 600 millones de dólares. Más que los números, aturde la impunidad absoluta con que se “limpia” el dinero sucio en ese país: en 2010, Wells Fargo llegó a un acuerdo con fiscales federales tras admitir que, antes de haberla adquirido, su filial Wachovia procesó casi 380 mil millones de dólares sin vigilar el origen de los recursos como lo obliga la ley.
Sus directivos reconocieron que conocían el riesgo de servir como intermediario de los cárteles mexicanos, pero decidieron permanecer en el negocio. Nadie fue judicializado y el banco sólo tuvo que pagar una multa de 160 millones de dólares, 0.042 del dinero po-
las instituciones neoliberales y dar curso al desarrollo sostenible en el seno de una renovada, tensa e intensa guerra fría, agudizada hoy en el mundo.
Su Yo acuso ante la Asamblea General de Naciones Unidas en 1972 es trágicamente vigente para toda nuestra América en el contexto de la entonces campaña de la ITT y la actuación de la CIA: “denuncio que mi país es víctima de una grave agresión: un ataque siempre oblicuo, subterráneo, sinuoso, pero no por eso menos lesivo.” Anticolonialista, se vio forzado a romper las amarras con el Fondo Monetario Internacional dada la grave asfixia que éste montaba en Chile. Son “fuerzas que operan en la penumbra, sin bandera, con armas poderosas apostadas en los más variados lugares de influencia”, denunciaba antes del golpe militar que lo derrocara finalmente, con el conocido costo de miles de desaparecidos, quemados, degollados y la violación sistemática de derechos humanos durante 17 años. Elegido con el sólido Programa de la Unidad Popular (UP) y sus 40 medidas (similares en lo grueso a las 100 medidas de la Cuarta Transformación de Morena en México), su trágico asesinato se convirtió en laboratorio para el capitalismo neoliberal, globalizado y unipolar. Bajo la UP, el Esta-
tencialmente ilícito que ayudó a mover. Todos estos números conducen a una serie de conclusiones ineludibles. Más allá de si las instituciones financieras mexicanas denunciadas son culpables o no, es evidente que las acciones contra ellas tienen poco o nada que ver con el combate al tráfico de fentanilo y al lavado de dinero, y que se inscriben en la campaña permanente de golpeteo político que los gobernantes y los medios estadunidenses mantienen contra México, así como en la retórica que busca trasladar a otros países la culpa de todos los problemas generados por la configuración particularmente salvaje del capitalismo estadunidense. Se presenta, además, la creación de una cortina de humo para encubrir la complicidad del gobierno estadunidense con las grandes corporaciones y los dueños de grandes capitales que se benefician con el dinero del crimen organizado –conducta facilitada por Bessent y su jefe, el presidente Donald Trump, mediante el desmantelamiento sistemático de las regulaciones que podrían prevenir el lavado–. En este contexto, el jefe del Tesoro incurre en esquizofrenia o hipocresía al hablar de una “sólida relación intergubernamental entre Estados Unidos y México, cuyos sellos distintivos incluyen la estrecha colaboración y el intercambio oportuno de información”. Si la Casa Blanca realmente desea un vínculo basado en la cooperación en el combate al tráfico de estupefacientes, debe hacer su parte en detener el masivo blanqueo de capitales que tiene lugar dentro de sus fronteras, tomarse en serio el papel de sus empresas de armamento como auténticas facilitadoras de la actividad delictiva y, ante todo, cesar la campaña de difamación y golpeteo político contra México que sus funcionarios replican, ya sea de manera coordinada o como producto no planeado de una xenofobia compartida.
do jugaba un rol social, regulador y fiscalizador en la economía. Se planteaban jubilaciones justas, previsión para todos, el “medio litro de leche” para todos los niños, consultorios materno-infantiles en las poblaciones, medicina gratuita en los hospitales, derecho a becas en la enseñanza básica, media y universitaria. Carta completa en: https://bit.ly/45AIYky Kemy Oyarzún, premio Amanda Labarca, Universidad de Chile
Día Internacional en Apoyo a las Victimas de la Tortura
El 12 de diciembre de 1997 la ONU declaró al 26 de junio Día Internacional en Apoyo a las Victimas de la Tortura. Esta declaración deja en claro una necesidad planetaria por tipificar ciertas faltas intolerables a los derechos humanos.
Para que una sociedad en general pueda desarrollarse de manera íntegra, deberían existir mínimos legales que trasciendan constituciones o autoridades nacionales. Es decir, hay situaciones que no son aceptables aunque vengan expedidas por autoridades locales. Para poder tener un contrapeso ante aquellos gobiernos que
confunden soberanía con tiranía nacional o internacional, hay que llegar a consensos y acuerdos como el que se celebra este día. La tortura en ningún escenario es un método viable por parte de ningún agente, disidente o autoridad. Luis Enrique Aparicio López
Invitación
Festival en defensa de la Ciudad Deportiva Jornada por la defensa y recuperación de la Ciudad Deportiva Magdalena Mixiuhca. En ella habrá conferencias, exposición musical, radio bocina, lectura en voz alta y festival. ¡Apóyanos con tu presencia! La cita es a partir de hoy hasta el domingo desde las 7 de la mañana en la puerta 7a. Juan Jesús Estrella Chávez, vocero del Comité por la Defensa y Recuperación de la Ciudad Deportiva Magdalena Mixiuhca
A NUESTROS LECTORES
Les rogamos que los comentarios y aclaraciones que envíen para su publicación en El Correo Ilustrado no excedan de 1,000 caracteres (con espacios) o de 14 líneas. Favor de dirigirlos a: Av. Cuauhtémoc 1236, col. Santa Cruz Atoyac, CP 03310, Benito Juárez. e-mail: svaladez@jornada.com.mx Teléfonos: 55-9183-0300 ext. 4456 y 55-9183-0315
Los textos deben incluir la dirección y teléfono del firmante, así como una copia de identificación oficial (credencial de elector o pasaporte)
ACUSA AL CÁRTEL DE SINALOA DE CAUSARLES “ESTRAGOS”
Interrogada en el Senado, Pam Bondi menciona al país junto con Irán y China // El demócrata Jack Reed reprocha que aún dejan que armas estadunidenses lleguen al narco
DE LA REDACCIÓN
La fiscal general de Estados Unidos, Pam Bondi, calificó ayer a México de “adversario extranjero”, durante una audiencia ante el Comité de Apropiaciones del Senado sobre el presupuesto 2026.
“No nos dejaremos intimidar y mantendremos a Estados Unidos seguro. No sólo de Irán, sino de Rusia, China y México. De cualquier adversario extranjero que esté tratando de matarnos físicamente, o por sobredosis a nuestros hijos, con drogas”, afirmó al responder al republicano Lindsey Graham, quien preguntó si estaba en condiciones de decir “al régimen iraní” que Washington no se dejará intimidar y hará “lo que sea mejor para Israel y para nuestra propia seguridad”. Además, Graham preguntó si México está ayudando con el problema
de las drogas. Tras la interpelación, que Bondi intentó evadir, e incluso le propuso que el tema fuera tratado en privado, el senador insistió: “ellos (los mexicanos) deben saber que la mitad de su país está gobernado por los cárteles. Nunca vamos a estar seguros aquí hasta que hagamos que México cambie su estrategia”. La fiscal acusó entonces al cártel de Sinaloa de haber “causado estragos en nuestro país”, frente a lo cual Graham reaccionó: “¡suficiente de esa mierda!” El fentanilo “continúa entrando”, añadió Bondi. “Iremos tras ellos con o sin la ayuda de México, porque yo no sé las respuestas correctas para un vecino que permite estas ilegalidades, que mata a más jóvenes que cualquier otro método; más y más personas fallecen por envenenamiento de fentanilo que viene de México. Eso necesita terminar rápidamente”, advirtió el republicano.
En este contexto, el legislador demócrata Jack Reed intervino y planteó otro asunto clave: “¿qué estamos haciendo para evitar que armas americanas lleguen a México para suministrar a los cárteles?”
“Eso es un tema que necesita apoyo de ambas partes: México y Estados Unidos”, fue la respuesta de la fiscal, pero Reed insistió. “¿Qué está haciendo Estados Unidos, de su lado, para enfrentar el problema?”
Bondi afirmó que están “arrestando a personas que tienen armas ilegalmente en nuestro país. No las enviamos a México de regreso con armas. Los mandamos a prisión”. Reed interpeló nuevamente a la fiscal: “no, ustedes están permitiendo que las armas sean compradas en Estados Unidos y llevadas al otro lado de la frontera; la mayoría de estos grupos criminales se convirtió en organizaciones militares porque

están usando arsenal y tecnología estadunidenses”. La funcionaria aseguró que esa “fue una política durante los cuatro años anteriores, en la administración de Joe Biden”. No conforme con la respuesta, el legislador demócrata la interrumpió: “no, ¿qué están haciendo para detener el flujo de armas a México?”
Bondi aseguró que las fronteras estadunidenses “están cerradas”, que por ellas no salen ni entran armas.
FERNANDO CAMACHO
Y ENRIQUE MÉNDEZ
Con el propósito de establecer la obligatoriedad de la coordinación en materia de seguridad por parte de los tres órdenes de gobierno, así como profesionalizar a las fuerzas policiacas de todo el país, la Cámara de Diputados avaló anoche la expedición de una nueva Ley General del Sistema Nacional de Seguridad Pública.
La norma se avaló en lo particular con 423 votos en favor, de Morena y aliados, pero también del PAN, que adelantó su apoyo al proyecto con el propósito de que el gobierno no tenga “pretextos” para no dar resultados contra la delincuencia. En contra sólo se registraron 63 sufragios, de las bancadas de PRI y MC, partido que antes había avalado la ley en lo general.
La discusión de este punto, que se extendió más de 10 horas, estuvo marcada desde el inicio por la controversia, ya que los opositores denunciaron que el bloque mayoritario cometió un albazo legislativo al enviar ayer mismo en la madrugada una reserva que –aseguraron– cambia sustancialmente el dictamen aprobado en comisiones en marzo.
El coordinador del PRI, Rubén Moreira, denunció que las obser-
vaciones se enviaron en forma de una “adenda” de casi 500 páginas, sin cumplir el proceso legislativo adecuado y con la firma de sólo seis de los 18 integrantes de la junta directiva de la Comisión de Seguridad Ciudadana.
Este “desaseo”, sostuvo, no permitía que los diputados –ni siquiera
los del bloque mayoritario– leyeran el texto a profundidad.
▲ “El fentanilo continúa entrando”, dijo ayer la fiscal Pam Bondi durante una audiencia en el Senado. Foto Afp
“Arrestamos a miembros del cártel de Sinaloa, de la MS-13 de El Salvador, del Tren de Aragua (de Venezuela); confiscamos 14 mil 600 armas desde que Donald Trump es presidente; eso es un incremento de 33 por ciento respecto a la anterior administración”, defendió la fiscal.
En defensa del dictamen, Morena y aliados explicaron que la ley votada obliga a la Federación, estados y municipios a coordinarse en materia de seguridad, fija planes de acreditación y certificación para todas las corporaciones de este ramo, y permite que la Auditoría Superior de la Federación revise cómo se utilizan los fondos federales en dichas tareas.
NO HAY CESE EL FUEGO ● MAGÚ
En sentido contrario, el priísta Emilio Suárez Licona alertó que la propuesta “desmantela el federalismo en materia de seguridad pública para sustituirlo por un centralismo

competencial y presupuestal”, pues como advirtió su correligionario Alejandro Domínguez, se faculta al Consejo Nacional de Seguridad Pública a suspender las aportaciones federales a estados y municipios si considera que no han cumplido con los acuerdos en la materia. César Damián Retes (PAN) dijo que, aunque su partido daba un voto de confianza para avalar el proyecto, “con esta reforma no hay lugar para pretextos, improvisaciones o para culpar al pasado. Si después de esta enmienda no dan resultados, una de dos: son incompetentes o están coludidos con la delincuencia organizada”.
Casi al final de la sesión –en la cual 74 oradores expusieron más de 400 reservas, ninguna de las cuales fue aceptada–, el debate se volvió ríspido, luego de que el priísta Carlos Gutiérrez Mancilla se trenzara de nuevo en una serie de acusaciones mutuas de comportamiento violento con la petista Karina Rojo Pimentel.
Es para prevenir delitos, no para espiar: Morena // Autoriza escuchas y revisión hasta de registros médicos
ENRIQUE MÉNDEZ Y FERNANDO CAMACHO
En una sesión caracterizada por la confrontación entre bancadas, la Cámara de Diputados aprobó anoche en lo general una nueva ley de inteligencia, que regula las atribuciones de la Secretaría de Seguridad y Protección Ciudadana (SSPC), así como del Centro Nacional de Inteligencia (CNI), para obtener y procesar información de todo tipo de archivos, públicos y privados, con el fin de prevenir delitos, sobre todo de alto impacto.
La ley se aprobó con 368 votos de Morena, PT, PVEM y MC, y 101 en contra de PRI y PAN. El pleno comenzó a discutirla en lo particular al cierre de esta edición.
El marco legal amplía las facultades del titular de la SSPC, Omar García Harfuch, como explicó la bancada de Morena. “Le damos un marco jurídico para prevenir y combatir este tipo de delitos”, indicó Sandra Anaya desde la tribuna. El alcance de la norma fue rebatido a lo largo del día por la oposición, que criticó los fines de la obtención de datos de empresas, ciudadanos y –según el PRI– hasta de estudiantes universitarios. “Esta ley no protege, sino que espía”, sostuvo la priísta Fuensanta Guadalupe Guerrero; en contraste, la morenista Maribel
ANDREA BECERRIL Y GEORGINA SALDIERNA
La Comisión Permanente dio entrada ayer a dos iniciativas de la presidenta Claudia Sheinbaum, reglamentarias de la reforma judicial, a fin de agilizar la impartición de justicia, abatir el rezago en juzgados, tribunales y la Suprema Corte, y crear el equivalente a la figura de jueces sin rostro, ya que se resguardará la identidad de los juzgadores que lleven procesos relacionados con la delincuencia organizada. En el primer proyecto, la mandataria propone modificaciones al Código Nacional de Procedimientos Penales y a la Ley Federal contra la Delincuencia Organizada, con miras a que jueces, magistrados y ministros surgidos de la reciente elección y los subsecuentes respondan de
Solache señaló que el desaparecido Centro de Investigación y Seguridad Nacional “sí nos tenía espiados”. Así, las atribuciones de seguimiento e intervención telefónica, y de supervisión incluso de registros médicos, fueron el eje de la discusión, que comenzó a las 8:30 de la noche y se alargaba hacia la madrugada.
“No se trata de espiar a nadie, sino de prevenir, no improvisar. La inteligencia es la clave estratégica de no represión, porque un país sin inteligencia estratégica está ciego ante el crimen organizado”, argumentó Alberto Maldonado (Morena).
Ricardo Monreal Ávila, coordinador de la mayoría legislativa, comprometió que los productos de inteligencia obtenidos por la secretaría y el CNI no constituyen un retroceso histórico desde la izquierda en el poder, que durante décadas denunció el espionaje de Estado contra los opositores.
“No se retornará a estructuras de espionaje del pasado” ni a figuras como las de Miguel Nazar Haro o Fernando Gutiérrez Barrios, sostuvo.
“No se va a retornar a eso, que quedó sepultado en regímenes pasados, y no se va a repetir o a reincidir en figuras de esa magnitud”, apuntó.
Como parte de la nueva ley, el titular de la SSPC podrá requerir a las instituciones de seguridad y a todas las dependencias del Estado, así como a entes privados, en su

caso, interconexión o envío de información en materia de seguridad pública contenida en registros vehiculares y de placas, datos biométricos y telefónicos, registros públicos inmobiliarios y de personas morales y catastros, datos fiscales, telefónicos, de armas de fuego, de comercio, de inmuebles, de empresas de seguridad privada y de padrones de detenidos y sentenciados, así como de “todos aquellos de donde pueda extraer indicios, datos y pruebas para las investigaciones”.
La ley, que partió de una adenda de 116 páginas y sustituyó de hecho el dictamen original aprobado en marzo por las comisiones, incluye la
formalización de informantes para el CNI y obliga a todas las autoridades del Estado y a particulares a vincularse y colaborar con los órganos del Sistema Nacional de Seguridad, y entregar información de distintas fuentes de información.
Además de las anteriores, de las que podrá disponer el titular de Seguridad, tendrá acceso a “registros financieros, bancarios, de transporte, salud, telecomunicaciones, comerciales y todos aquellos de donde se puedan extraer datos, indicios y pruebas para la generación de productos que ayuden a la prevención, investigación y persecución de los delitos”.
manera eficaz, bajo los principios de honestidad, austeridad, honradez, legalidad, imparcialidad, transparencia, disciplina y profesionalismo. La exposición de motivos señala que se dotará a los juzgadores de un marco jurídico que permita la aplicación de la ley con perspectiva de derechos humanos y se procurarán las medidas necesarias para su protección, que comprenden preservar la identidad de quienes lleven juicios relacionados con delitos establecidos en la Ley Federal contra la Delincuencia Organizada. Para ello, la iniciativa contempla incluir en esta ley un capítulo denominado “De la protección de las personas”, y la adhesión de los artículos 22 bis y 22 ter en el Código
Nacional de Procedimientos Penales, en los que se definen los mecanismos y criterios objetivos para solicitar medidas de resguardo. Dicha medidas deberán ser requeridas por el nuevo órgano de administración judicial del Poder Judicial de la Federación, el que decidirá si deben ponerse en marcha, con base en criterios definidos, que son la capacidad real del grupo delictivo para causar daño al juzgador, existencia de amenazas y agresiones anteriores, entre otros.
La protección de la identidad y otras disposiciones de resguardo deberán ser sometidas a revisión periódica y oficiosa por ese órgano de administración mediante la unidad especializada que establezca al
GEORGINA SALDIERNA Y ANDREA BECERRIL
El Senado aprobó ayer reformas a la Ley Federal para la Prevención e Identificación de Operaciones con Recursos de Procedencia Ilícita y al Código Penal Federal que fortalecen los mecanismos para evitar este delito. El dictamen se avaló con 74 votos en favor, de Morena y aliados; 13 en contra, de PRI y algunos panistas, y 19 abstenciones, de MC y otros integrantes del PAN, como el coordinador, Ricardo Anaya. La mesa directiva anunció que el documento se turnará a la Cámara de Diputados para su análisis y votación.
La enmienda pasó con cambios de última hora para eliminar toda referencia al financiamiento del terrorismo, ya que ese delito ya está tipificado en el Código Penal Federal y México es parte de instrumentos internacionales que prevén su combate. Elimina terrorismo
efecto, de tal forma que no se prolongue la medida. La iniciativa da entrada a los dos órganos que sustituirán al Consejo de la Judicatura Federal: el Tribunal de Disciplina Fiscal y el Órgano de Administración Judicial, y con base en el principio de justicia pronta y expedita se erige un plazo común en las actuaciones procedimentales.
La importancia de modificar los plazos, que se definió en la reforma judicial, “lleva a introducir cambios sustanciales dentro del procedimiento penal y limita la discrecionalidad de los juzgadores”, a fin de evitar el detrimento de los derechos humanos de víctimas, imputados y sentenciados.
La morenista Lucia Trasviña fue la encargada de presentar la reserva mediante la que se hicieron las modificaciones. Explicó que se elimina del dictamen la figura citada porque es innecesaria y redundante y podría llevar a una antinomia jurídica. Durante el debate, el panista Francisco Ramírez Acuña sacó a relucir el caso de las tres instituciones financieras acusadas por el Departamento del Tesoro de lavado de dinero, al criticar la eficacia de la Unidad de Inteligencia Financiera (UIF). ¿La UIF y la Comisión Nacional Bancaria y de Valores (CNBV) desconocían circunstancias? ¿Les faltaba información? ¿Se hicieron ojo de hormiga? ¿Qué paso?, preguntó. Guadalupe Chavira (Morena) reviró que tanto la Secretaría de Hacienda como la UIF y la CNBV han informado sobre una investigación al respecto. En términos generales, la oposición se manifestó en favor de combatir las operaciones con recursos de procedencia ilícita, pero “esta causa legítima se está usando como Caballo de Troya para imponer vigilancias sin control y sospechas sin pruebas”. Guadalupe Murguía y Ramírez Acuña se quejaron de que la definición de persona políticamente expuesta es ambigua y da pie a que cualquier ciudadano relacionado con ella pueda ser sujeto de sospecha. Morena consideró falsos tales planteamientos. Javier Corral, presidente de la Comisión de Justicia y promotor del cambio, recordó que la Ley para la Prevención e Identificación de Operaciones con Recursos de Procedencia Ilícita no es una norma penal ni de persecución de delitos, sino que tiene una naturaleza preventiva y administrativa.
“LOS MIGRANTES NO SON CRIMINALES”
La Presidenta calificó de injusta la detención de Narciso
Barranco // Reiteró su desacuerdo con las redadas
ALMA E. MUÑOZ Y ALONSO URRUTIA
La presidenta Claudia Sheinbaum Pardo declaró que es una injusticia la violenta detención de Narciso Barranco, realizada por agentes del Servicio de Inmigración y Control de Aduanas (ICE, por sus siglas en inglés), un mexicano con 31 años viviendo en Estados Unidos y padre de tres elementos de las fuerzas armadas de ese país.
“Es injusto, una injusticia; las y los mexicanos que viven en Estados Unidos, los migrantes, son personas que se fueron a ese país por necesidad y que han hecho su vida allá… no son criminales”, puntualizó.
Reiteró que no está de acuerdo con las redadas y “vamos a seguir defendiendo a nuestros hermanos y hermanas allá con los consulados”.
En su conferencia de prensa, manifestó que de manera diplomática, “hemos dicho que tienen que ser reconocidos… Al mismo tiempo que son mexicanos son estadunidenses, aunque no tengan el papel de la nacionalidad, porque han aportado a Estados Unidos toda su vida”.
Sheinbaum declaró que el consulado de Los Ángeles “entró de inmediato en contacto” con el mexicano arrestado el sábado mientras trabajaba a las afueras de una cafetería en Santa Ana, California. “Los millones y millones de mexicanos no son delincuentes, son héroes y heroínas, y (haremos) todo lo que esté en nuestras manos para ayudarlos”.
Asimismo, reconoció al actor Diego Luna por el monólogo que hizo en un programa de televisión en el país vecino “donde dice justamente esto: millones de mexicanos y mexicanas han dado su vida para que Estados Unidos y la ciudad de Los Ángeles sean lo que son”.
Sin datos sobre vigilancia de CJNG a agentes de la DEA
La Presidenta también indicó que su gobierno no tiene información de que miembros del cártel Jalisco Nueva Generación (CJNG) vigilaron a agentes de la Administración para el Control de la Drogas (DEA, por sus siglas en inglés) durante el juicio de Rubén Oseguera González, El Menchito, en 2024, como lo reveló el agente especial Matthew Allen. “Lo que nosotros hemos estado planteando desde que llegamos, y previamente (lo hizo) el presidente (Andrés Manuel) López Obrador, es que la presencia de la delincuencia organizada no sólo es en México, y la mayor parte del dinero que se recauda es en Estados Unidos por la venta ilegal de droga”.
Precisó que con el gobierno de Donald Trump hay trabajo conjunto en el combate a la delincuencia organizada, “cada uno en su territorio y compartiendo información”, con respeto a nuestras soberanías.
Pero es evidente, insistió, que en Estados Unidos hay delincuencia organizada, “y cómo se vincula en México es parte de las investigaciones que se hacen”.
La embajada de Estados Unidos en México alertó sobre supuestos contenidos en redes sociales en los que se publicitan túneles clandestinos para el paso irregular de migrantes hacia su territorio. “¡Es una trampa!”, enfatizó la sede diplomática. En su cuenta oficial en la plataforma X, la representación de Washington en nuestro país calificó que se trata de videos “falsos”, orquestados por bandas de traficantes de personas –ligados al crimen organizado– que buscan engañar y lucrar con las personas, sin importar los riesgos que pueden enfrentar. Desde hace varios meses, bandas de traficantes de personas han posteado en redes sociales –sobre todo en TikTok– este tipo de videos. Algunas cobran hasta 10 mil dólares el cruce. En la publicación también se advirtió que toda persona que trate de cruzar de manera irregular será arrestada.
Emir Olivares y Arturo Sánchez
La Suprema Corte de Justicia de la Nación (SCJN) recortó de 30 a 18 los asuntos que discutirá en la recta final de la actual integración del pleno. Entre los temas retirados están la prisión preventiva oficiosa, el arraigo y las impugnaciones a la Ley Minera y la Ley General de Comunicación Social, asuntos que quedarían en manos de los nueve nuevos ministros, que entrarán en funciones el 1º de septiembre. Aunque los asuntos podrían ser reincorporados a la agenda, al pleno actual, encabezado por la ministra presidenta Norma Piña Hernández, sólo le restan cinco
sesiones, la última programada para el 12 de agosto. Entre los proyectos que salieron está el de la ministra Margarita Ríos Farjat, que desde hace un año busca resolver si los jueces deben aplicar de manera automática la prisión preventiva oficiosa o si pueden valorar su procedencia según el mandato constitucional. Otro pendiente es el proyecto del ministro Jorge Mario Pardo Rebolledo, en el que la Corte deberá definir cómo deben actuar los jueces federales para cumplir con la sentencia de la Corte Interamericana de Derechos Humanos en el caso García Rodríguez y otro contra México, particularmente sobre el “control de convenciona-

El Pentágono creará dos nuevas zonas militares a lo largo de la frontera con México, aseguraron ayer dos funcionarios estadunidenses, en lo que será una medida que permite a las tropas detener temporalmente a “migrantes o intrusos”.
lidad” frente al arraigo y la prisión preventiva automática. También quedó fuera el proyecto del ministro Alfredo Gutiérrez Ortiz Mena sobre la acción de inconstitucionalidad contra la reforma de 2022 a la Ley Minera que declaró al litio como mineral estratégico y reservado al Estado. Relacionado con éste, el ministro Alberto Pérez Dayán tiene listo otro, que analiza reformas ambientales y mineras de 2023. Finalmente, también quedaría en el archivo el proyecto del ministro Juan Luis González Alcántara Carrancá sobre la solicitud de declaratoria general de inconstitucionalidad de la Ley General de Comunicación Social de 2018.
Se creará una nueva “Zona de Defensa Nacional” que abarcará unos 402 kilómetros del río Grande en Texas y será administrada como parte de la Base Conjunta de San Antonio, según la fuerza aérea.
Los funcionarios aseguraron que
La primera abarcará unos 402 kilómetros del río Grande en Texas
la otra zona militar se administrará como parte de la estación aérea del cuerpo de marines en Yuma, Arizona. El Pentágono ya ha creado dos zonas militares, pero sólo cuatro personas han sido detenidas temporalmente en ellas, agregaron. Las zonas están destinadas a permitir que el gobierno federal use tropas para detener a los migrantes sin invocar la Ley de Insurrección de 1807 que faculta a un presidente a desplegar al ejército para reprimir eventos como el desorden civil. Como medidas legales disuasorias para los que cruzan la frontera, las zonas han tenido resultados dispares. Los jueces federales en Nuevo México y Texas desestimaron los cargos de allanamiento contra docenas de inmigrantes sorprendidos en las zonas, alegando que no sabían que estaban en una zona militar restringida. Sin embargo, unos 120 migrantes se declararon culpables de cruce irregular en la primera zona de Texas en mayo y los fiscales federales obtuvieron sus dos primeras condenas en la zona de Nuevo México el pasado 18 de junio, según las fiscalías de ambos estados. Alrededor de 11 mil 900 efectivos están actualmente en la frontera.
Denuncia el Departamento del Tesoro a dos bancos y una casa de bolsa // Presuntamente lavan dinero; hacen negocios con China // Los panistas de Querétaro
ENRIQUE GALVÁN OCHOA
DOS BANCOS Y una casa de bolsa mexicanos –CIBanco, Intercam y Vector– que realizan negocios con empresas chinas, fueron denunciadas por el Departamento del Tesoro de Estados Unidos, presuntamente porque “han desempeñado conjuntamente un papel clave y prolongado en el lavado de millones de dólares en nombre de los cárteles con sede en México y en la facilitación de pagos para la adquisición de precursores químicos necesarios para la producción de fentanilo”. El jefe de la dependencia es el multimillonario Scott Bessent, nombrado por el presidente Donald Trump y confirmado por el Senado en enero de 2025. En su biografía aparece el dato de que antes trabajó para George Soros. La casa de bolsa Vector está ligada al empresario regiomontano Alfonso Romo, quien fue jefe de la oficina de la Presidencia de López Obrador entre el 1º de diciembre de 2018 y el 2 de diciembre de 2020. Como quiera que se vea, el incidente abre otro campo de batalla en las tensas relaciones con el gobierno de Trump.
La conexión china
NO TOMÓ POR sorpresa el anuncio del Tesoro al secretario de Hacienda, Edgar Amador Zamora; ya tenía conocimiento de la investigación. En un comunicado, dijo que solicitaron pruebas al Departamento del Tesoro del vínculo de las instituciones con actividades ilícitas que pudieran ser corroboradas por la Unidad de Inteligencia Financiera y la Comisión Nacional Bancaria. “La única información proporcionada por el Departamento del Tesoro que puede verificarse por parte de México, contiene datos de algunas transferencias electrónicas realizadas a través de las citadas instituciones financieras con empresas chinas legalmente constituidas. La UIF encontró transacciones realizadas a dichas empresas chinas por más de 300 empresas mexicanas a través de 10 instituciones financieras nacionales. Esto es así porque México tiene miles de operaciones ordinarias con empresas legalmente constituidas de China, pues existe un comercio anual de 139 mil millones de dólares”.
POR SEPARADO, LOS bancos y la casa de bolsa señaladas por el Departamento del Tesoro rechazaron las acusaciones. CIBanco aseguró a través de un comunicado que “no mantiene relación con actividades ajenas a la legalidad y reitera el cumplimiento de todos los lineamientos establecidos por las autoridades competentes”. Dijo: “los recursos de nuestros clientes se encuentran protegidos conforme a la Ley de Protección al Ahorro Bancario y las operaciones del banco continúan con total normalidad”. La casa de bolsa Vector sostuvo que las operaciones corresponden a transacciones ordinarias con empresas legalmente constituidas. Subrayó que las inversiones de sus clientes están totalmente respaldadas y manifestó su disposición a colaborar con las autoridades de ambos países a fin de aclarar cualquier duda. Intercam negó tajantemente “la vinculación de esta institución con cualquier práctica ilícita, particularmente lavado de dinero, y reiteró su compromiso con la transparencia y la legalidad”.
Díselo a Claudia
Asunto: la pensión de 16 mil pesos
PREGUNTA PARA LA doctora Claudia Sheinbaun Pardo: ¿Usted cree de verdad que 16 mil pesos es una pensión digna para un pensionado que tiene que pagar renta, gas, luz, teléfono, medicamentos y diversión? ¿Usted podría vivir con esta pensión mensual? Porque los servicios del Issste están muy mal, si no tiene la cita programada hay que formarse tempranísimo para alcanzar ficha, y de especialidades, ya ni le digo, llevo cinco meses esperando el pase a ortopedia.
María del Carmen Ubaldo Galindo Twiteratti
LOS PANISTAS EN #Querétaro quieren el dinero para el #proyectoBatan por adelantado. Funcione o no funcione el agua (de) drenaje para consumo humano, eso no importa, quieren el dinero primero, y luego investigan si funciona. Alejandra F. de Erruzca @AleFerruzcal
Facebook, TikTok, Twitter, Instagram: galvanochoa; Correo: galvanochoa@gmail.com

ALMA E. MUÑOZ Y ALONSO URRUTIA
Tras precisar que su reforma electoral no eliminará la autonomía del Instituto Nacional Electoral (INE), la presidenta Claudia Sheinbaum Pardo indicó que no se presentará en septiembre, y que un grupo de trabajo dentro del gobierno hará la propuesta para ponerla a discusión. No quiso decir cuándo la daría a conocer, pero acotó que no será para las elecciones intermedias de 2027, aunque reiteró que deben eliminarse las listas de plurinominales.
“Esta idea de que estuviste seis años fuera de México y luego regresaste a ser el número uno de la plurinominal, o sea, ¿cómo?”, cuestionó en referencia a casos como el del panista Ricardo Anaya.
Afirmó que “el INE sigue como organismo autónomo y tiene que seguir así, pero es mucho recurso el que destina el pueblo de México para elecciones. Queremos que siga habiendo elecciones limpias, democráticas. Es falso, falso, falso que seamos un gobierno autoritario, que estamos buscando el autoritarismo. Solito se cae el argumento”. La mandataria dijo que es muy importante eliminar las listas de plurinominales y privilegiar el trabajo en territorio para ganar el voto.
“He puesto el ejemplo de que la Ciudad de México, y también otros estados, tienen un esquema de reconocimiento de las minorías en donde el segundo lugar accede al espacio que le corresponde al partido político, lo mismo tiene el Senado de la República, pero el problema son las listas de plurinominales.”
La “virtud” de eso, agregó, es que “todos van a territorio a hacer campaña. Y esa es “una consideración que estamos tomando para que las listas plurinominales se eliminen”. Presentaremos la propuesta, se haría una discusión abierta “y a partir de ahí habrá reformas”, agregó. –¿No habrá resistencia por parte de los aliados (de Morena), el Partido Verde y el Partido del Trabajo?
–No lo creo, porque todos estamos de acuerdo en que hay que ir a territorio a presentarse con la ciudadanía.
–¿La reforma electoral sería para septiembre?
–No, apenas inicia el grupo de trabajo y se presentará también para su discusión.
Indicó que “a lo mejor” la reforma se presenta el próximo año, pero “no tenemos fecha… Lo que sí es que inicia un grupo de trabajo dentro del gobierno para hacer la propuesta, y a partir de ahí ya se presentaría, se daría su tiempo para discusión y su aprobación”.
Garantizan acceso a Internet con nueva Ley de Telecomunicaciones
ALMA E. MUÑOZ Y ALONSO URRUTIA
La nueva Ley en Materia de Telecomunicaciones y Radiodifusión garantizará el acceso a Internet para todos los mexicanos, cuando actualmente al menos 16 millones no lo tienen, y dará uso justo e inclusivo del espectro a comunidades indígenas y afromexicanas, afirmó el titular de la Agencia de Transformación Digital y Telecomunicaciones, José Antonio Peña Merino. Resaltó que la norma prohíbe transmitir propaganda extranjera en medios electrónicos y precisó que nunca fue una ley para la censura; pero, para evitar confusiones, “el artículo 109 que hablaba de apagar plataformas, que era un tema estrictamente fiscal, referido a un artículo de la Ley del IVA”, se eliminó. Entre los principales cambios que tuvo la nueva norma tras los

conversatorios en el Senado, Peña Merino subrayó que se fortalece la cobertura pública y social para el acceso a Internet, pero “sin dejar de robustecer un sector competitivo que sea atractivo a la inversión, al despliegue de infraestructura y al crecimiento de la cobertura privada por parte de operadores”. En la mañanera del pueblo, resaltó que con esta ley se crea la Comisión Reguladora de Telecomunicaciones, como un órgano desconcentrado dentro de la agencia a su cargo, pero con independencia técnica, operativa y de gestión. La presidenta Claudia Sheinbaum señaló que está a favor de los medios públicos y dijo que en este 2025 tuvieron una reducción presupuestal, porque ya no tuvieron los recursos especiales que el año pasado se les dieron para antenas. Ahora, agregó, hay presupuesto extraordinario para mejoramiento de su equipo.

FABIOLA MARTÍNEZ Y NÉSTOR JIMÉNEZ
Consejeros del Instituto Nacional Electoral (INE) defendieron la facultad de este órgano para excluir de la sumatoria de la elección judicial los votos de poco más de 800 casillas, equivalentes a 0.97 por ciento del total de mesas instaladas el primero de junio.
Argumentaron que dicha decisión fue parte del análisis previo a la emisión de la declaratoria de validez de los comicios y, además, que en esta elección extraordinaria no hubo recuento de votos.
El martes de esta semana, la presidenta de la República, Claudia Sheinbaum, sostuvo que el INE “se extralimitó” al decidir no incorporar esos votos a la sumatoria general, y aseveró que tal determinación correspondía al Tribunal Electoral del Poder Judicial de la Federación (TEPJF).
En ese contexto, la mandataria anunció que presentará una iniciativa de reforma electoral para reducir el gasto en el sector, y aseguró que hay un grupo de consejeros que vota en contra de la voluntad del pueblo.
Sufragios viciados, “tenemos pruebas”
La consejera Claudia Zavala señaló al respecto que el INE es responsable de verificar que todos los actos se realicen conforme a lo establecido por la ley y la Constitución. “Nosotros dejamos muy claro que era inviable tomar en cuenta esos
Consejeros argumentan “hechos graves” para no contabilizar 818 casillas
votos porque estaban viciados, y teníamos pruebas de ello”, afirmó.
El pasado 15 de junio, los 11 consejeros del INE votaron a favor de no incorporar 818 casillas en el cómputo nacional de la elección de ministros, magistrados y jueces federales, con lo que se invalidaron 3.7 millones de sufragios.
Si bien en la declaratoria de validez la votación fue dividida, en el punto relacionado con las irregularidades –y, por lo tanto, con el retiro de casillas de la sumatoria– el acuerdo fue unánime entre los 11 consejeros.
En el proyecto aprobado se indica que se registraron hechos graves, como boletas sin doblez (lo que sugiere que no fueron depositadas en las urnas, sino incorporadas posteriormente), casillas con más votos que personas inscritas, otras en las que supuestamente votó 100 por ciento del padrón, así como boletas marcadas con la misma caligrafía, entre otras irregularidades.
“Eso lo advirtió la autoridad, y como está viciado, lo tiene que retirar, porque el TEPJF no va a entrar a
EXCUSA INJERENCISTA ● JERGE

hacer esos estudios. El tribunal, en su caso, lo que tendrá que hacer es declarar la nulidad”, añadió Zavala. El consejero Uuc-kib Espadas subrayó que, a diferencia de las elecciones presidenciales o legislativas, en la elección judicial es el INE la instancia que valida en primera instancia el proceso.
El INE deberá defenderse
Janine Otálora, magistrada de la sala superior del TEPJF, indicó que la Constitución establece que le compete al INE realizar el cómputo final de votos a nivel nacional y declarar la validez de las elecciones judiciales.
Sobre los votos no sumados, puntualizó: “el tema llegará a la sala superior y, en su momento, veremos de qué manera se interpretará la ley. No quisiera adelantar un criterio”.
Añadió que, en caso de que la determinación del INE sea impugnada, “lo que va a pasar es que el Consejo General tendrá que rendir un informe y argumentar en de-
fensa propia por qué actuó como lo hizo”.
En diversos espacios, los consejeros recordaron que en esta elección extraordinaria no hubo recuento de votos en los consejos distritales, etapa que en otros comicios permite corregir errores o circunstancias irregulares en el cómputo. “Aquí no está prevista esa posibilidad”, explicó el consejero Arturo Castillo. Sobre las declaraciones de la Presidenta, subrayó que no fue una decisión de cinco personas, sino del conjunto del Consejo General. En cuanto a la supuesta existencia de un grupo de consejeros con tendencia en su votación, Castillo comentó: “no es mi caso. En política, a veces la memoria tiende a ser selectiva. Por ejemplo, se está olvidando cómo voté en la asignación de diputaciones de representación proporcional. Yo voto siempre de conformidad con mi convicción jurídica. En aquel momento voté a favor de esa asignación porque estoy convencido, hasta la fecha, de que eso es lo que ordenan la ley y la Constitución. Actué como árbitro.
El árbitro no es amigo ni enemigo de nadie”.
Omisiones de los comités de evaluación
Hasta anoche, el INE continuaba con la revisión de expedientes, y la secretaría ejecutiva alistaba un nuevo proyecto en el que se establecería, en su caso, quiénes serían los candidatos ganadores de la elección de magistrados de circuito y jueces de distrito que no cumplen con el promedio académico establecido en la Constitución para ser elegibles al cargo.
Esto ocurre 24 días después de la jornada electoral y luego de 16 del cierre de los cómputos en los consejos distritales. “Los comités de evaluación no hicieron su trabajo; no revisaron minuciosamente los requisitos de elegibilidad constitucional, entre ellos el más básico: la calificación de licenciatura y las materias de especialidad. Se está revisando todo”, agregó Castillo.
Avala el TEPJF la constitucionalidad del cómputo de sufragios del primero de junio
NÉSTOR JIMÉNEZ Y FABIOLA MARTÍNEZ
La sala superior del Tribunal Electoral del Poder Judicial de la Federación (TEPJF) ratificó la constitucionalidad del cómputo de las votaciones de la elección judicial, realizadas en los consejos distritales y no en las casillas electorales, como ocurrió por primera vez en la pasada jornada electoral. Esto al rechazar un recurso que solicitaba considerar dicha circunstancia como causal de nulidad. Al mismo tiempo, determinó que un ciudadano que no fue candidato carece de interés legítimo para impugnar alguno de los resultados de esta elección inédita. En sesión de la sala superior, los magistrados electorales declararon improcedentes más de un centenar de recursos de inconformidad contra la elección judicial. Entre los casos abordados durante la sesión de ayer, el Tribunal Electoral validó –con votación dividida– el criterio del Instituto Nacional Electoral (INE), que permitió que un candidato apareciera de manera sistemática en espacios radiofónicos, a pesar de que la normativa prohíbe la compra de tiempos con fines de propaganda.
Con ello, se consideró legal la candidatura de César Gutiérrez Priego, hijo del ex general Jesús Gutiérrez Rebollo, quien aspiraba a convertirse en ministro de la Suprema Corte de Justicia de la Nación (SCJN), aunque no obtuvo los votos suficientes para acceder al máximo tribunal del país.
Respecto de la constitucionalidad del lugar en que se realizaron los cómputos de la elección judicial del domingo primero de junio, se debatió una queja relacionada con la elección de magistradas y magistrados del Tribunal de Disciplina Judicial en Durango. En ella se argumentó que “fue ilegal que el escrutinio se realizara en el consejo distrital y no por los funcionarios
El tribunal declara improcedentes más de 100 recursos
de casilla en el lugar donde éstas fueron instaladas”. El magistrado Reyes Rodríguez Mondragón, quien presentó el proyecto, propuso que, para atender la impugnación, se debían “abrir las puertas de acceso a la justicia” a toda la ciudadanía, en su papel de “protagonista” del proceso. Sin embargo, la magistrada Janine Otálora se pronunció en contra al señalar que no existía una afectación real y directa al ciudadano promovente. No obstante, distinguió este caso de otros, como las consultas populares o las candidaturas independientes, en los que, sostuvo, cualquier ciudadano sí tiene legitimación e interés jurídico para impugnar. Sobre la queja contra la candidatura de Gutiérrez Priego, los magistrados emitieron una votación dividida: dos a favor y dos en contra de adoptar la resolución del INE, que había desestimado que su presencia constante en espacios radiofónicos como colaborador constituyera una indebida adquisición de tiempos. Fue el voto de la presidenta del Tribunal Electoral, Mónica Soto, el que inclinó la balanza para desechar la impugnación, al considerar que ese tipo de exposición en medios no justificaba la anulación de la candidatura.
LA JORNADA
Romo, factor contaminante en la 4T // Conflicto de intereses // EU, Vector y cárteles // Con plurinominales o sin ellas
JULIO HERNÁNDEZ LÓPEZ
ALFONSO ROMO GARZA nunca debió ser jefe de la Oficina de la Presidencia. Él mismo lo dijo en mayo de 2018 a Azucena Uresti, en Milenio Televisión: “Mira: él (Andrés Manuel López Obrador) me ha estado proponiendo como jefe de gabinete, como coordinador del gabinete, como todo. Yo, la verdad, y lo digo con mucho respeto, no voy a hacer nada en lo que tenga yo conflicto de intereses”.
AGREGABA: “YO LE decía el otro día a Andrés Manuel, de broma: ‘Ya no digas que voy a ser jefe de gabinete, porque no voy a ser’. Por que... ¿te acuerdas del caso del Toallagate? Imagínate tú, yo con los negocios que tengo, mañana mi grupo financiero hace una colocación de papel de Pemex... ¡No! Me van a crucifi... ¡Si Anaya me está crucificando por algo que no dijo Andrés Manuel! Tú imagínate. Entonces, yo tengo que ser muy cuidadoso por la reputación que le debo a mis negocios, a mi familia, al mismo país, al mismo gobierno. Sería... habría mucha suspicacia. Entonces, yo prefiero ayudarle de otra forma que no tenga conflicto” (el tema fue abordado en esta columna en julio de 2019: 4T y (evidentes) conflictos de intereses https://goo.su/fwCSaBw).
SIN EMBARGO, LÓPEZ Obrador, en acto masivo en la Macroplaza de Monterrey, anunció que Romo ocuparía el cargo de jefe de la oficina presidencial. No tuvo ahí gran poder político, pues el tabasqueño en varias ocasiones hizo justamente lo contrario de aquello que había enviado a negociar a Romo, quien, por otra parte, pudo seguir haciendo negocios en el marco previamente anunciado del conflicto de intereses. Finalmente dejó el cargo, pero no la productiva relación con el presidente de la República.
AHORA, EL FACTOR Romo, financista apoyador de campañas (lo mismo de Fox o Salinas que de López Obrador), derechista colindante con lo ultra, ganancioso en sus empresas y abusivo en varias por su cercanía con el poder político, se entera del señalamiento de una agencia gubernamental de Estados Unidos de
que, además de otras dos firmas, se sanciona a Vector, fundada por Romo, principal accionista, bajo acusación de haber servido a cárteles como el de Sinaloa y el del Golfo.
ELIMINAR EL FACTOR de las candidaturas plurinominales podría tener un valor táctico para Palacio Nacional, en la medida en que le permitiera zafarse de las presiones y celadas de los grupos dominantes de Morena que desde ahora, y marcadamente, se mueven en función de sus intereses subgrupales.
POR ELLO MISMO, como sucedió con la pretensión de cerrar jurídicamente el paso a los proyectos de continuidades familiares en cargos importantes (los Salgado en Guerrero, los Monreal en Zacatecas, los Gallardo en San Luis Potosí, por dar ejemplos), la iniciativa contra lo plurinominal legislativo puede toparse con reticencias y torpedeos internos, como la prohibición de la relección, que en el Congreso fue pospuesta hasta finales del sexenio claudista aunque, en compensación, Morena la incorporó como resolutivo sin obligatoriedad jurídica, ni siquiera plasmado en sus estatutos.
OTRO ELEMENTO INTERESANTE de la batalla contra los pluris radica en la obligación de que los futuros representantes populares se ganen sus asientos en la brega directa, en las calles y plazas, de frente a los electores (en el “territorio”, se dice ahora por moda de aspiración épica). En realidad, la vía plurinominal o de representación popular fue establecida en tiempos de la aplanadora priísta para dar espacios acotados a la oposición, que sólo excepcionalmente lograba ganar cargos por mayoría. Otro objetivo era que los cuadros partidistas, especializados en materias a discutir y promover en las cámaras, pudieran estar en éstas sin competir directamente, pues sus perfiles eran técnicos, más que políticos.
PERO, FUERA DE esas consideraciones, la persistencia o eliminación de esa vía de representación proporcional no afectaría sustancialmente los mecanismos de postulación, campañas y elección de diputados y senadores, pues sus fallas, graves, no provienen del factor plurinominal, sino de una estructura mayor, cuasimafiosa. ¡Hasta mañana!
APROBADA, LEY DEL SISTEMA DE SEGURIDAD PÚBLICA

Sigue
la mesa” posible pena de muerte contra Caro Quintero
DAVID BROOKS Y JIM CASON CORRESPONSALES NUEVA YORK Y WASHINGTON
Rafael Caro Quintero compareció en la tercera audiencia de procedimiento de su proceso judicial, ante el juez federal Frederic Block, en la que se abordó el avance en la preparación de evidencia del caso, incluidas las grabaciones del interrogatorio y tortura del agente estadunidense Enrique Kiki Camarena. En esta audiencia, parte del proceso que eventualmente culminará en un juicio, se abordó el tema pendiente de si los fiscales buscarán aplicar la pena de muerte como castigo máximo si el acusado es declarado culpable, pero la fiscal asistente Saritha Komatireddy informó que aún no se ha determinado ese asunto, aunque “sigue sobre la mesa”. Entre otras pruebas, la fiscalía informó que cuenta con unas 30 intervenciones de comunicaciones del acusado y múltiples entrevistas con socios y evidencia de varios asesinatos ligados a Caro Quintero. También se continuó discutiendo las condiciones del prisionero y su equipo de defensa en una sala del tribunal federal del distrito del este en Nueva York con sede en Brooklyn. La abogada de oficio de Caro Quintero, Elizabeth Macedonio, indicó al juez que este caso es sumamente complejo, sobre todo porque los cargos más serios son en torno a hechos que ocurrieron hace 40 años. El acusado, en uniforme de reo café claro, escuchó atentamente sin mostrar ninguna reacción. Su sobrino Ismael Quintero Arellano también está incluido en este juicio y estuvo presente. Caro Quintero enfrenta cargos por encabezar una conspiración criminal, que incluye el delito de conspiración de asesinato por el secuestro,
Niegan cambio de penal a La Tuta; se quejó de falta de atención médica
tortura y homicidio de Kiki Camarena, agente de la Administración para el Control de Drogas (DEA), en 1985. Ese delito está en el centro del caso, en el cual fiscales y la DEA enfatizan que nadie puede evadir la justicia estadunidense al cometer crímenes como ése contra uno de sus agentes. Eso explica la insistencia de enjuiciar a un narcotraficante que desde hace tiempo dejó de ser una figura relevante en el crimen organizado.
La razón principal
Los fiscales y la agencia antinarcóticos han subrayado esto como la razón principal para enjuiciar al acusado, así como otros cargos de conspiración para la distribución internacional de narcóticos y el uso de armas de fuego en torno al narcotráfico. Si es declarado culpable, enfrenta una sentencia de cadena perpetua y posiblemente la pena capital. En su primera audiencia a fines de febrero, fue recibido con la presencia de unos 100 agentes de la DEA y otras agencias federales. A esta audiencia llegaron seis. Caro Quintero fue presentado ante este tribunal por primera vez el 28 de febrero, un día después de que él y otros 28 mexicanos fueron entregados a las autoridades estadunidenses y que, según documentos y comunicados oficiales estadunidenses, fueron “expulsados”, no “extraditados” de México. El caso de Caro Quintero está en el mismo tribunal federal donde fueron juzgados Joaquín El Chapo Guzmán y Genaro García Luna, y donde Ismael El Mayo Zambada está en espera de un posible juicio. Por ahora permanecerá encarcelado en el mismo centro de detención en Brooklyn donde residen El Mayo y varios reos estadunidenses de alto perfil. Su próxima audiencia fue programada para el 18 de septiembre.
y ortopédica, ya que desde el 11 de marzo de este año se le retiró el medicamento y empezó con secuelas de la parálisis facial que sufrió en octubre de 2024 en el Altiplano.
▲ Tras más de 10 horas de discusión, los diputados avalaron anoche la expedición de una nueva Ley
del Sistema Nacional
Pública, que establece la
obligatoriedad de la coordinación en materia de seguridad de los tres órdenes de gobierno y busca profesionalizar a las fuerzas policiacas de todo el país. Foto Cristina Rodríguez
Un juez de distrito rechazó la demanda de amparo que promovió Servando Gómez Martínez, La Tuta, ex líder de La familia michoacana y Los caballeros templarios, quien solicitó la protección de la justicia para que lo regresen al penal de máxima seguridad del Altiplano, en el estado de México, pues se quejó de falta de atención médica en la prisión federal de Michoacán donde está recluido. En diciembre del año pasado fue trasladado al Centro Federal de Readaptación Social Número 17, ubicado en el municipio de Buenavista Tomatlán, Michoacán. En su demanda, que presentó a Juan Pablo Cortés Torres, juez primero de distrito en materia penal en Toluca, pidió apoyo “urgente” para que le brinden auxilio en medicina siquiátrica, general
“Esto obra en mi expediente clínico, por lo que no se me debe retirar el medicamento ni la atención siquiátrica, ya que sufro de estrés postraumático, trastorno explosivo impulsivo y requiero de mi medicación adecuada. Y solicito que si el centro no cuenta con los médicos me sea permitido que yo compre mi medicamento, ya que puede repercutir en mi salud y causarme daños severos. También solicito la audiencia con el director para que él, siendo la mayor autoridad de este centro, haga algo al respecto y en dado caso de no poder, que me traslade al Altiplano. Gracias”. Ante la negativa, La Tuta interpuso una queja ante un tribunal colegiado, el cual declaró infundado el recurso. César Arellano García
La instancia agrega que estarían implicados funcionarios // Busca llevar el tema a la Asamblea General
JESSICA XANTOMILA Y JARED LAURELES
El Comité de la Organización de Naciones Unidas contra la Desaparición Forzada (CDF) envió al Estado mexicano una solicitud para que proporcione información sobre los indicios que ha recibido respecto a que en el país esta práctica se lleva a cabo de forma generalizada o sistemática. A raíz de esta información, el organismo analizará la posibilidad de llevar el tema ante la Asamblea General de la ONU.
En el documento se establece que México deberá entregar la información antes del 18 de septiembre próximo, ya que el CDF la examinará durante su 29 periodo de sesiones, que se celebrará del 22 de septiembre al 4 de octubre de 2025, con el fin de tomar una determinación.
La gravedad de las desapariciones en México llevó al comité a invocar, en abril pasado, el artículo 34 de la Convención Internacional sobre la materia. Este artículo estipula que, si el CDF recibe información que, a su juicio, contiene “indicios bien fundados” de que la desaparición forzada se practica de forma generalizada o sistemática en el territorio de un Estado parte, podrá presentar la cuestión “con carácter de urgente” ante la Asamblea General. El comité reconoció las medidas adoptadas recientemente por México para hacer frente a las desapariciones, incluidas las forzadas, como el decreto presidencial del 18 de marzo de 2025 “por el que se fortalece el proceso de búsqueda”; el proyecto de reforma de la Ley General en la materia –actualmente en discusión–; así como los planes para mejorar los registros forenses. Sin embargo, el comité subrayó que ha recibido información “creí-
ble” de diversas fuentes –la más reciente, procedente de la Federación Internacional por los Derechos Humanos (FIDH), en febrero y abril de 2025–, con datos recabados también por Idheas Litigio Estratégico en Derechos Humanos. Esta información sugiere que el fenómeno “es lo suficientemente grave” como para justificar la invocación del artículo 34 de la convención. La FIDH presentó “casos documentados que parecen reflejar la comisión de desapariciones forzadas de manera sistemática y generalizada, tanto en el pasado como en el presente”. En particular hizo referencia a la situación en Coahuila, entre 2009 y 2016; en Nayarit, entre septiembre de 2011 y septiembre de 2017, y en Veracruz, entre 2010 y 2017. En cuanto a hechos más recientes, el CDF destacó que la información disponible revela 28 mil 880 desapariciones reportadas entre el primero de enero de 2023 y el 22 de abril de 2025. Asimismo, indicó que la situación en Coahuila, Jalisco, Nayarit y Veracruz “parece indicar que las desapariciones se han cometido de manera sistemática, con patrones específicos que involucrarían directamente a algunos funcionarios estatales, o que se llevarían a cabo con su autorización, apoyo o aquiescencia”.
Los datos recibidos, añadió el Comité, indican que “la naturaleza organizada de las desapariciones forzadas parece evidenciarse mediante los recientes hallazgos de fosas comunes; la práctica sistemática de desapariciones en un contexto de disputa territorial entre cárteles de la droga, con un modus operandi similar, que incluye distintos niveles de implicación, tolerancia o falta de intervención por parte de las autoridades”, así como la persistencia de la impunidad y el encubrimiento.
La 4T no promueve ni tolera ese delito, subraya
EMIR OLIVARES Y ARTURO SÁNCHEZ
El gobierno de México rechazó que existan desapariciones forzadas sistemáticas y generalizadas por parte del Estado en territorio nacional. “Cualquier señalamiento o insinuación en ese sentido es inaceptable”, respondieron las secretarías de Relaciones Exteriores (SRE) y de Gobernación (SG) a la solicitud que el Comité de la Organización de las Naciones Unidas contra la Desaparición Forzada (CED) hizo al Estado mexicano. En un comunicado conjunto, ambas dependencias del gobierno federal informaron que el comité solicitó información relativa al tema, la cual es parte del proceso iniciado en abril de este año bajo el artículo 34 de la convención internacional en la materia.
“En la solicitud se realizan al-
gunos señalamientos que, a juicio de México, carecen de sustento”, subrayaron Relaciones Exteriores y Gobernación.
“México reitera su rechazo a que en nuestro país haya desapariciones forzadas sistemáticas y generalizadas por parte del Estado y cualquier señalamiento o insinuación en ese sentido es inaceptable.”
Señalaron que las autoridades del país trabajan con colectivos y familiares de desaparecidos en el marco de nuevas iniciativas de ley para atender integralmente este delito.
“Es importante reiterar que el gobierno mexicano está comprometido con el combate al delito de desaparición de personas y que, en los gobiernos de la Cuarta Transformación no se promueve ni se tolera la desaparición forzada. El servidor público que incurra en este delito, sin excepción, será investigado y en su caso, será sancionado conforme a la ley”, remarca-
ron las dependencias a nombre de la administración de la presidenta Claudia Sheinbaum Pardo.
Garantizaron que las instituciones del Estado mexicano “continuarán cooperando con los mecanismos internacionales de protección de los derechos humanos y darán respuesta a esta solicitud, en los tiempos requeridos”. El pasado 4 de abril –tras años de miles de desapariciones forzadas cometidas sobre todo en pasadas administraciones federales y por particulares—, el CED activó por primera vez un protocolo contra México.
Ese día, al finalizar el 28 periodo de sesiones del CED, el presidente del organismo, Olivier de Frouville, señaló que “el comité recibió información fundamentada que indica que la desaparición forzada se lleva a cabo de manera general o sistemática en el territorio que es jurisdicción de México”.

▲ Las autoridades mexicanas declararon que están comprometidos con el combate al delito de sustracción de personas. En la imagen, la
denominada glorieta de los desaparecidos, en Paseo de la Reforma, Ciudad de México. Foto Marco Peláez
ALONSO URRUTIA
Y ALMA MUÑOZ
La presidenta Claudia Sheinbaum sostuvo que continúa revisándose la base de datos del Registro Nacional de Personas Desaparecidas, porque se han detectado inconsistencias en el origen de la información. “Las cifras de desaparecidos provienen de diversas fuentes de información. En algunos casos es de una plataforma en la que las personas suben direc-
tamente la información, en otras lo hace la Comisión Nacional de Búsqueda” o algunas fiscalías. La mandataria aseguró que es necesario sistematizar esta situación, por eso se incluye en la iniciativa enviada al Congreso sobre desaparición de personas. Subrayó que uno de los aspectos más relevantes que contiene es la obligatoriedad que impone a las fiscalías General de la República y estatales de levantar una carpeta de investigación en cuanto se presente una denuncia so-
bre desaparición, pues actualmente no están obligadas a ello. Hay otra información, que tiene que ver con personas que lamentablemente fallecieron, pero no están identificadas adecuadamente. Por eso es importante que en la base de datos se cuente con toda la información de la persona desaparecidas. Eso es parte de lo que viene en las nuevas Leyes de Búsqueda y de Población para mejorar la prevención y la atención al problema de los desaparecidos en México.
A pregunta expresa sobre una eventual reforma para reordenar las fiscalías, la Presidenta aseveró que en primera instancia se quiere concluir con las adecuaciones legales a la reforma constitucional del Poder Judicial. Por ello, sería hasta 2026 cuando se podrían analizar las modificaciones al marco legal que regula la operación de la fiscalías, pero adelantó que no se estaría pensando en eliminar la autonomía que actualmente tienen.
En Guerrero, exigen esclarecer casos
CHILPANCINGO, GRO. Colectivos de desaparecidos en Guerrero, durante la etapa de la guerra sucia (1969-1979), anunciaron una jornada de lucha en la Ciudad de México “por la justicia, el esclarecimiento de los hechos y la reparación integral de los daños a los familiares de los afectados, como lo establece la Ley General de Víctimas”.
Sergio Ocampo, corresponsal

FIRMADO POR MÉXICO EN 2023
Es un instrumento que regula el acceso a recursos de los océanos: Murat
GEORGINA SALDIERNA Y ANDREA BECERRIL
En su tercera sesión extraordinaria, el Senado aprobó ayer por unanimidad ratificar el Acuerdo Marco de la Convención de Naciones Unidas sobre el Derecho del Mar, relativo a la “conservación y el uso sostenible de la diversidad biológica marina de las zonas situadas fuera de la jurisdicción nacional”.
El presidente de la Comisión de Relaciones Exteriores de esa Cámara, Alejandro Murat Hinojosa, resaltó que ese acuerdo, que fue adoptado en Nueva York el 19 de junio de 2023 y firmado por México en septiembre del mismo año, es un logro multilateral de los más importantes en décadas recientes, ya que dota al mar de un marco jurídico claro, vinculante y orientado a la equidad.
Murat explicó que los océanos cubren más de 360 millones de kiló-

metros cuadrados, equivalentes a 72 por ciento de la superficie terrestre, que son “cuna de la vida, reguladores del clima global, fuente de alimento, transporte, comercio y gene-
ración del conocimiento científico”.
Hizo notar que el océano sustenta una economía que rebasa 1.5 de billones de dólares anuales en sectores como la pesca, turismo,
Además de Juan Antonio Ferrer y Roberto Canseco, se aprobaron los nombramientos de 10 cónsules
ANDREA BECERRIL, GEORGINA SALDIERNA Y ARTURO SÁNCHEZ
En medio de un escándalo provocado por panistas, la Comisión Permanente ratificó ayer los nombramientos presidenciales de Juan Antonio Ferrer como representante de México ante la Organización de Naciones Unidas para la Educación, la Ciencia y la Cultura (Unesco), y de Roberto Canseco Ramírez como embajador ante Jamaica, así como de 10 cónsules en Estados Unidos, Canadá y Brasil.
Los nuevos diplomáticos rindieron protesta, en medio de los gritos de una legisladora de Acción Nacional que megáfono en mano se subió hasta la presidencia de ese órgano del Congreso para tratar de impedir que recibieran la constancia de su nombramiento.
Desde el inicio de la discusión de los dictámenes, los blanquiazules enfocaron baterías en contra de Ferrer, cuestionaron su gestión como titular del desaparecido Instituto para el Bienestar (Insabi) y criticaron que entre los cónsules propuestos sólo hay cuatro de carrera y los demás son militantes de Morena y del PRI.
El senador del PVEM Jorge
Carlos Ramírez Marín refutó los señalamientos y recordó a los opositores que todos los gobiernos han nombrado a políticos como embajadores o cónsules y han hecho un gran papel.
Sin embargo, la senadora Lilly Téllez, que desde su intervención inicial se lanzó contra Ferrer, a quién llenó de insultos, luego de la votación que ratificó los nombramientos presidenciales sacó su megáfono y no dejó de gritar “corrupto, corrupto, ya vas a correr”.
La diputada del PT Lilia Aguilar le respondía con la frase “que pague Salinas, que pague Salinas” en referencia al dueño de TV Azteca, que adeuda una suma millonaria en impuestos y es cercano a la panista.
El presidente de la mesa directiva de la Permanente, Gerardo Fernández Noroña, tuvo que alzar la voz al máximo para nombrar a cada uno de los diplomáticos y tomarles la protesta, sin que Téllez dejara de gritonear y de hacer ruido.
Ya no pudo seguir sonando la sirena del altavoz en el recinto porque Lilia Aguilar le cortó con tijeras los cables del aparato y la panista, perpleja, debió bajar de tribuna, donde ya estaban otras legisladoras de la 4T, como Yeidkol Polevnsky, para hacerle frente.
Los nuevos embajadores, así como Rafael Laveaga Rendón, Carlos Iriarte Mercado, Luis Rodríguez Bucio, Marcos Augusto Bucio Mújica, Marco Antonio Mena, Neftalí Zaid Pérez, Donají Alba Arroyo, Claudia Velasco Osorio, Iván Roberto Sierra Medel y Julián Adem Díaz de León recogieron sus constancias como cónsules en Atlanta, Georgia; Boston, Massachusets; Dallas, Texas; Nueva York; San Francisco y San José, California; Raleigh, Carolina del Norte (todos de Estados Unidos), así como Sao Paulo (Brasil), Toronto y Vancouver (Canadá), respectivamente, recogieron sus constancias y se tomaron la foto, luego del mal momento.
“No se pierda el próximo episodio del show bellaco, aquí en el mismo canal”, comentó irónico Fernández Noroña.
Por otra parte, la Secretaría de Relaciones Exteriores (SRE) informó ayer que además de estos 10 cónsules ayer ratificados, se aprobó el nombramiento de nuevos titulares en siete consulados de carrera, los cuales no requieren ratificación del Senado. Se trata de Inés Maxaira Baltazar (Santa Ana), Alejandra Bologna (Saint Paul), Irma Pimentel (Fresno), Salvador Percastre (San Bernardino), Evelyn Vera (Calgary),
A su vez, Maki Ortiz, del PVEM, advirtió que es urgente una acción coordinada entre las naciones para alcanzar a proteger al menos 30 por ciento de los océanos en 2030.
Autorizan a marinos ir a tomar un curso en Florida
Morena, PT y Partido Verde coincidieron en la importancia de defender los recursos marinos. Foto Germán Canseco
biotecnología y energía. Sin embargo, alertó, enfrenta amenazas mayores como la pérdida de biodiversidad, acidificación de los mares, contaminación plástica, sobrepesca y minería en aguas profundas, sin regulación clara ni mecanismos.
Con ese instrumento internacional, agregó Murat Hinojosa, se busca regular el acceso a los recursos genéticos marinos, permite la creación de áreas marinas protegidas con base en criterios científicos y exige evaluaciones de impacto ambiental antes de realizar actividades en altamar.
Al respecto, la senadora del PT Yeidckol Polevnsky resaltó que los mares no tienen bandera ni partido, son patrimonio común de la humanidad y conservarlos es prioridad.
Durante la sesión y también por unanimidad, el Senado autorizó la solicitud de la presidenta Claudia Sheinbaum para la salida de 30 elementos de la Armada de México que participarán en el curso táctico básico Perfiles de Misión Completa e Integración Aérea, a realizarse en Blanding, Florida, Estados Unidos, del 13 al 26 de julio.
La propuesta de la jefa del Ejecutiva federal llegó ayer mismo a la Comisión Permanente, la que aprobó que se incorporara a la agenda del periodo extraordinario, dado que es facultad exclusiva del Senado autorizar la salida de tropas. Por otra parte, en comisiones, el Senado aprobó ayer dos minutas que se votarán hoy en el pleno: la que faculta al Instituto Nacional de Estadística, Geografía e Informática (Inegi) a asumir las funciones del Consejo Nacional de Evaluación de la Política de Desarrollo Social (Coneval), uno de los organismos autónomos eliminados por la reforma constitucional de diciembre del año pasado.
Asimismo, avaló la minuta con la legislación reglamentaria del sistema ferroviario nacional.

Alberto Fierro (Estambul) y Rodrigo Mendivil como jefe de la sección consular en la embajada de México en Washington.
Reunión ministerial entre México y Guatemala
México y Guatemala celebraron ayer una reunión ministerial del Grupo de Alto Nivel de Seguridad, en seguimiento a las instrucciones de la presidenta, Claudia Sheinbaum, y su homólogo guatemalteco, Bernardo Arévalo, informó la Secretaría de Relaciones Exteriores en su cuenta de la plataforma X. La delegación mexicana fue encabezada por el canciller Juan Ramón de la Fuente y estuvo conformada por altos funcionarios del gobierno federal, entre ellos el jefe de la Oficina de la Presidencia, Lázaro Cárdenas Batel; el director del Centro Nacional de Inteligencia, Francisco Almazán; el comisionado del Instituto Nacional de Migración,
Sergio Salomón; la subsecretaria para América Latina y el Caribe, Raquel Serur; el general Román Villalvazo Barrios, en representación de la Secretaría de la Defensa Nacional, y el vicealmirante Juan Carlos Vera Salinas, por a Secretaría de Marina. Por parte del gobierno guatemalteco participaron los ministros de Gobernación y de Relaciones Exteriores, así como el secretario de Seguridad Estratégica, entre otros funcionarios.
Durante la reunión, ambas delegaciones reafirmaron su compromiso de trabajar de manera coordinada en materia de seguridad, con pleno respeto a la soberanía de los estados y al derecho internacional. Con información de la Redacción
ÁNGELES CRUZ MARTÍNEZ
La violencia en el país, en los hogares y contra las mujeres está directamente relacionada con el consumo de bebidas alcohólicas, lo que representa un desafío por la normalización de su ingesta, incluso en menores de edad y por la alta disponibilidad en actividades deportivas, supermercados y tiendas de proximidad, advirtieron especialistas.
La Red de Acción sobre el Alcohol (RASA) presentó los resultados del estudio La relación del alcohol y la violencia en México. Iptsisam Nuyud Yassine, consultora en adicciones, subrayó que en 45 por ciento de homicidios dolosos perpetrados en 2023, el agresor estaba bajo los efectos del alcohol, y de acuerdo con el Instituto Nacional de Ciencias Penales, en los estados con mayor consumo de alcohol per cápita hay 30 por ciento más homicidios.
Refirió otras investigaciones, según las cuales 60 por ciento de quienes mueren por peleas callejeras habían ingerido alcohol, mientras 25 por ciento de los feminicidios son cometidos por individuos embriagados.
Además, el consumo nocivo se ha extendido entre las adolescentes, quienes, según estadísticas oficiales, reportan beber a la par que los hombres, sin saber que tienen mayor riesgo de desarrollar dependencia. En los varones pueden pasar hasta 10 años para que esto ocurra y para las mujeres, entre cuatro y ocho años.
Falta ahondar en el problema
Todo esto contribuye a la generación de violencia en el país, lo que podría revertirse con leyes y reglamentos para el control del alcohol, señaló Alonso Robledo, integrante de RASA, quien subrayó que el au-
mento en los impuestos es la medida más efectiva. Profesionales adscritos a servicios de salud mental identificaron que la mayoría de mujeres que piden ayuda han sido víctimas de violencia sicológica, emocional, física, sexual, económica y de intentos de feminicidio. “El alcohol es feminicida”, afirmó el sicólogo Édgar Angulo Rosas. El consumo de bebidas embriagantes forma parte de la violencia estructural, y tradicionalmente se ha asociado con el machismo, pero poco se habla sobre si un hombre está alcoholizado cuando agrede a su pareja. Coinciden en que el consumo de alcohol y la violencia de género están estrechamente ligados. Entre los factores que inciden está la disponibilidad de bebidas, la alta publicidad y promoción de éstas, lo que se traduce en un riesgo 1.3 y 1.9 veces mayor de ingesta excesiva mensual y semanal, respectivamente.

Alerta ONU por alza significativa en el consumo de drogas sintéticas en México
SÁNCHEZ JIMÉNEZ Y EMIR OLIVARES
México enfrenta un aumento significativo en los problemas de salud asociados al consumo de drogas sintéticas, incluso mientras el mercado de fentanilo muestra señales de debilitamiento en América del Norte, según el Informe Mundial sobre las Drogas 2025 de la Oficina de Naciones Unidas contra la Droga y el Delito, que será presentado hoy, y que ubica al país como unos de los fabricantes de metanfetaminas a gran escala.
Señala que mientras Estados Unidos y Canadá reportaron en 2023 y 2024 indicios de un mercado de fentanilo en declive y una tendencia a la baja en la cifra de muertes por sobredosis, así como
caída en la pureza de la droga –que atribuye a una menor disponibilidad de precursores en México–, nuestro país ha visto “un aumento significativo debido al fentanilo en el número de personas en tratamiento y atención por trastornos del consumo de drogas entre 2018 y 2023”. Asimismo, datos del país “muestran un incremento en las admisiones a tratamiento por metanfetamina, especialmente de hombres”.
Agrega que aunque entre 2015 y 2023 se había visto un alza acelerada de las incautaciones de fentanilo, a partir de 2023 autoridades estadunidenses observaron una desaceleración en el crecimiento de los decomisos e incluso una estabilización, acompañada de baja en las muertes por sobredosis. Estos cambios reflejan una interrupción en la cadena de suministro del
“SE ANALIZARÁN VIOLACIONES”
ALMA E. MUÑOZ Y ALONSO URRUTIA
En el gobierno analizaremos las violaciones a leyes internacionales que provoca el lanzamiento de cohetes en la frontera con Estados Unidos, para presentar las demandas correspondientes, sostuvo la presidenta Claudia Sheinbaum Pardo. Al ser interrogada sobre las afectaciones ambientales que generó el impacto del cohete Starship de Space X en la costa tamaulipeca, tras despegar de la Starbase, en el sur de Texas, indicó que está por reunirse con el gabinete para analizar los impactos ambientales y de seguridad que representan esos lanzamientos. Estamos haciendo una revisión general de “qué leyes internaciona-
les están violando, y a partir de ahí iniciaremos un proceso porque, en efecto, sí hay contaminación”. Ambientalistas han hecho alertas –se le insistió– por las afectaciones a la fauna y el ecosistema marino por desechos, como fósforo blanco. Estamos revisando todo lo que tiene que ver con lanzamiento de cohetes que están muy cerca de nuestra frontera, los impactos que tienen en la zona y dentro del marco de las leyes internacionales, para hacer las demandas que sean necesarias, respondió. El noveno despegue de la nave Starship, el 27 de mayo pasado, dejó restos del propulsor de la nave en el litoral de Playa Bagdad, municipio de Matamoros, Tamaulipas, lo que generó millones de particulas de basura.
Sin definir, forma de entrega de insumos en hospitales; en Ixtapaluca falta hasta lo básico
ÁNGELES CRUZ MARTÍNEZ
▲ A la par que en el país crece el uso de estas sustancias, el mercado de fentanilo en toda América del Norte se debilita. Foto Ap
opioide sintético que, de acuerdo con el informe, “se ha atribuido a una menor accesibilidad de precursores en México, lo que refleja mayor conciencia entre los proveedores de productos químicos sobre el control internacional aplicado a estas sustancias”. La concentración de decomisos en Norteamérica –99 por ciento del total mundial– confirma el papel de México como punto de origen del tráfico hacia Estados Unidos entre 2022 y 2024, pues en ese periodo las incautaciones se originaron cuando la sustancia salía mayormente del país.
Las firmas de contratos entre las instituciones de salud y los proveedores de medicamentos y material de curación están en proceso, y para revertir las carencias que hay desde hace semanas ya se hacen entregas de insumos de manera directa en clínicas y hospitales. Aún se desconoce si éste será el mecanismo para el resto de las adquisiciones de 2025 y 2026 o cuál será el papel de Laboratorios de Biológicos y Reactivos de México (Birmex) y sus almacenes en Huehuetoca y Texcoco, estado de México.
“Hay un hermetismo total”, afirmaron miembros de la industria farmacéutica, mientras el desabasto se ha vuelto crítico en unidades como el Hospital Regional de Alta Especialidad de Ixtapaluca, donde faltan cerca de 100 tipos de productos que van desde paracetamol en solución inyectable, antibióticos y nutrición parenteral hasta una decena para tratamientos contra el cáncer.
El problema se ha acentuado desde hace semanas, comentaron trabajadores de ese hospital. El inventario, del cual tiene copia este medio, da cuenta de que están en una situación crítica: en cero, insumos como Losartán, solución Hartmann y Ketorolaco.
De las medicinas para el tratamiento de cáncer, carece de bleomicina, citarabina, dacarbazina, idarubicina, metotrexato, vinblas-
tina, busulfán, epirubicina y placlitaxel. También faltan insumos en los quirófanos, aseguraron los entrevistados.
Desde finales del sexenio pasado, la administración de esa unidad hospitalaria se transfirió a IMSSBienestar, organismo al que se solicitó información sobre el tema, pero no hubo respuesta. El hospital participó, con otras 25 instituciones de salud pública, en una compra consolidada de medicamentos, material de curación y auxiliares de diagnóstico que organizaron la Secretaría de Salud y Birmex para 2025 y 2026. De por sí el procedimiento estaba retrasado, comentaron ejecutivos del sector privado, pero cuando en abril la Secretaría Anticorrupción y Buen Gobierno anuló la licitación, el desabasto se agudizó, y “eso es lo que vemos en las unidades médicas”. Además, representantes de laboratorios y distribuidores de insumos señalaron que IMSS-Bienestar sigue sin pagar deudas por más de 15 mil millones de pesos que arrastra desde octubre pasado, lo “que pone en riesgo la cadena de suministro”, advirtieron. Sobre las entregas que ya se han empezado a hacer en centros de salud y hospitales, comentaron que la responsabilidad de esta tarea es de los fabricantes, titulares de los registros sanitarios que participaron en diferentes tipos de adquisiciones con las que se repuso la licitación que fue anulada.

▲ En la Ciudad de México, paseadores y perros se mantienen
Con la llegada de los libros de texto gratuitos, escuelas se convierten
El desafío es mantenerlos en buen estado pese a las malas condiciones de los planteles, señalan profesores
LAURA POY Y ALEXIA VILLASEÑOR
A fin de cumplir el mandato de la Secretaría de Educación Pública (SEP) de que todos los alumnos de prescolar, primaria y secundaria del país tengan sus libros de texto gratuitos (LTG) en el primer día de clases de cada ciclo escolar, la Comisión Nacional de Libros de Texto Gratuitos (Conaliteg) avanza en la distribución de más de 156 millones de ejemplares, que han comenzado a llegar a las escuelas para entregarlos a los estudiantes el próximo 1º de septiembre, cuando comienza el año lectivo 2025-2026. Directores y profesores de educación básica en la Ciudad de México informaron que el pasado 23 de junio comenzó la distribución a los planteles, por lo que la mayoría de las direcciones “prácticamente se han convertido en bodegas, ya que debemos resguardarlos hasta su en-
Reportan incidentes en primer día de elección del sindicato de GM
La consulta con la que más de 6 mil 500 trabajadores de la empresa GM en San Luis Potosí eligen a su nueva representación sindical tuvo el primer día algunas incidencias que serán analizadas una vez que finalice el proceso este viernes.
trega a los estudiantes en el primer día de clases del siguiente curso”.
En entrevista con La Jornada, señalaron que “ahora el desafío es que se mantengan en buen estado, pese a que tenemos malas condiciones en muchos de los espacios administrativos de las escuelas, incluyendo goteras”.
Entre decenas de cajas de cartón, el profesor Enrique Enríquez Ibarra, director de la escuela primaria Japón, destacó que una de las prioridades es “salvaguardar los LTG, a fin de que antes del regreso a clases se hagan los paquetes para cada alumno por grado escolar. Esperamos que no ocurra, como en otros años, que no siempre han llegado completos, y tenemos que esperar a que envíen los faltantes”.
Según datos de la Conaliteg, la tarea de distribución implica al menos 3 mil 649 viajes de tráileres de 25 toneladas en todo el país para llevar los LTG a siete zonas de distribución en los que se agrupan
Luis Rangel, asesor del Sindicato Independiente Nacional de Trabajadores y Trabajadoras de la Industria Automotriz (Sinttia), que compite contra el gremio patronal Carlos Leone, señaló que se prohibió ir a votar en ciertas áreas con el argumento de que no puede pararse la producción. Agregó que hay riesgo de duplicidad de votos, ya que se permitió sufragar a trabajadores en un sitio
ambiental pondrá límite
DANIEL GONZÁLEZ DELGADILLO
de gobierno, las comunidades locales, la sociedad civil y el sector privado, apuntó.
229 almacenes regionales. Sólo en la capital del país, donde se prevé entregar 8 millones 290 mil 382 ejemplares, se deben realizar 323 viajes para distribuirlos, pues cuenta con 136 centros de acopio, mientras a escala nacional hay 365 puntos de entrega.
Respecto a la capacidad de carga y transportación de los LTG, la Conaliteg señala que el tiempo de entrega de los materiales educativos, que incluyen texto en macrotipo y braille, pueden demorar de dos a siete días, dependiendo del destino. El punto de entrega más alejado, que se ubica en el municipio de San Quintín, Baja California, implica recorrer 2 mil 832 kilómetros.
La meta de distribución de los LTG para el ciclo escolar 20252026 es de 18.1 millones de ejemplates para prescolar. En primaria se entregarán 82.2 millones, además de 5 mil 982 ejemplares en braille y 39 mil 945 de macrotipo.
En secundaria se otorgarán 39.6 millones, así como 4 mil en formato braille y 27 mil 972 en macrotipo. En telesecundaria se consideran 14.6 millones de textos; mil 44 en braille y 8 mil 199 en macrotipo. Y para educación indígena se entregarán 2.1 millones de libros.
distinto al que les correspondía conforme al padrón en los ocho puntos de votación. Indicó que el personal del Centro Federal de Conciliación y Registro Laboral (autoridad responsable de organizar el proceso) les aseguró que eso no ocurriría. El proceso inició ayer a las 5 horas y concluyó a las 7 de la noche; se estima que participaron 2 mil trabajadores. Jared Laureles y Jessica Xantomila
Con el Programa Nacional de Restauración Ambiental, se busca poner límites a los usos desmedidos de los recursos naturales, además de ordenar las actividades industriales y extractivas, afirmó ayer Alicia Bárcena, secretaria de Medio Ambiente y Recursos Naturales, al fijarse con este plan metas prioritarias para 2030, como la contribución a la remediación de los ríos Tula, Lerma-Santiago, Atoyac y Sonora o la rehabilitación de 50 por ciento de ecosistemas costeros-marinos. Al presentar este programa en el Pabellón de Cultura Comunitaria del Bosque de Capultepec, Bárcena aseguró que es necesario “recuperar esa visión sistémica de la restauración, que nos permita restaurar esa variabilidad, ese ciclo que se da en ecosistemas naturales como las selvas tropicales, los manglares, los bosques templados”. Afirmó que la remediación “es un acto de justicia también, porque no basta sólo atender las causas, sino también tener esa visión amplia que involucre a la naturaleza”. Ante la acumulación de pasivos ambientales en el país, la funcionaria explicó que esta iniciativa tiene tres propósitos fundamentales: detener las causas del deterioro, permitir la regeneración natural y promover la restauración productiva. Además, considera la participación de los tres órdenes
El programa, detallado por la subsecretaria de Biodiversidad y Restauración Ambiental, Marina Robles, fija que del total de superficie degradada en 2024, se restaure 5 por ciento de ecosistemas costeros-marinos, principalmente manglares, este año, y 50 por ciento para 2030, además de contribuir a lograr la deforestación cero neta para final del sexenio.
También apunta a remediar 26 mil hectáreas de ecosistemas forestales este año y 73 mil 100 a 2030, a restaurar y decretar como áreas de prosperidad marina 10 sitios deteriorados del Golfo de California y a contribuir a la reducción de 35 por ciento de los gases de efecto invernadero al terminar el gobierno, entre otras medidas. El plan tiene identificados 50 sitios a escala nacional para restaurar este año, 25 en 2026 y más de 240 rumbo a 2050. Incluye zonas forestales, sistemas costeros y marinos, parques y bosques urbanos, islas, sitios con estrés sanitario y ambiental extremo. Bárcena señaló que en el país hay “un diagnóstico muy severo” porque 5 por ciento del territorio no está en condiciones de ningún tipo, en calidad de degradado. Agregó que 9.5 millones de hectáreas contienen condiciones extremas, “y son esos territorios justamente los que exigen pronta recuperación, en algunos casos remediación”.
La FGR deberá publicar el expediente de los 43: SCJN
IVÁN
EVAIR SALDAÑA
La Fiscalía General de la República (FGR) deberá hacer pública una versión de la carpeta de investigación sobre la desaparición de los 43 normalistas de Ayotzinapa, iniciada en el sexenio pasado, determinó ayer la primera sala de la Suprema Corte de Justicia (SCJN). Con cuatro votos a favor y uno en contra, la sala respaldó la resolución del extinto Instituto Nacional de Transparencia, Acceso a la Información y Protección de Datos Personales (INAI), impugnada con juicios de amparo promovidos por la Comisión Ejecutiva de Atención a Víctimas, en representación de tres testigos colaboradores, identificados como presuntos ex integrantes del grupo criminal Guerreros Unidos y señalados de haber participado en la desaparición de los normalistas. El INAI ordenó a la FGR entregar una versión pública de la carpeta de investigación FED/SDHPDSC/OI-GRO/000804/2019, en
la que se testaran los datos confidenciales y publicarla en el micrositio de Internet de la dependencia. En los dos juicios de amparo, los inconformes argumentaron que no fueron llamados a participar en el procedimiento ante el INAI, a pesar de estar involucrados en el caso. También señalaron que hacer pública la información podría afectar sus derechos, ya que podrían incluirse datos que revelen su identidad, lo cual los pondría en riesgo debido a la relevancia del caso y su relación con el grupo criminal mencionado.
El juzgado de distrito que conoció ambos asuntos negó el amparo. Ante esta decisión, los solicitantes interpusieron recursos de revisión, los cuales fueron atraídos por la SCJN debido a los temas de constitucionalidad involucrados. La Corte resolvió, con proyecto del ministro Juan Luis González Alcántara Carrancá, que al tratarse de un asunto relacionado con violaciones graves a derechos humanos, la información no puede ser reservada.
En los últimos días hemos atestiguado el desarrollo de un nuevo capítulo de la militarización en nuestro país, pauta que desde hace dos décadas caracteriza a la política de seguridad pública en México en contexto de la crisis generalizada de violencia e inseguridad. En continuidad con el traspaso de la Guardia Nacional a la Secretaría de la Defensa Nacional aprobado por el Congreso de la Unión en septiembre pasado, este martes la Cámara de Diputados aprobó en lo general una nueva Ley de la Guardia Nacional cuyo proyecto original contempla, además, la reforma a nueve leyes relacionadas.
Como muchas organizaciones de la sociedad civil y medios de comunicación han advertido, esta nueva ley significa otro retroceso en materia de derechos humanos, no sólo por los riesgos intrínsecos y ya demostrados que conlleva la militarización como mecanismo privilegiado para atender la violencia en el país, sino también por lo que se deriva de otras disposiciones que se estarían aprobando y que trascienden a la Guardia Nacional, como el fortalecimiento de las labores de inteligencia en manos de las fuerzas armadas. Frente a las críticas ciudadanas, la narrativa oficial ha negado que la Guardia Nacional y su traspaso a la Defensa representen una medida de militarización del país. Se argumenta con frecuencia que la verdadera militarización ocurrió con la salida del Ejército a las calles desde 2006, que ciertamente fue uno de los mayores episodios de militarización en México. Sin embargo, a contrapelo de esta narrativa, la literatura especializada considera el despliegue militar en tareas de seguridad pública como militarización directa y, a la vez, como sólo uno de los múltiples rasgos de la militarización como concepto más amplio del análisis de la realidad pública. Se entiende por militarización indirecta la asignación de labores de naturaleza civil a las fuerzas armadas, así como la incorporación de lógicas castrenses en las instituciones civiles. La creación de la Guardia Nacional con rasgos militares y su posterior traspaso a la Defensa son expresiones claras de esta militarización, del mismo modo que el fortalecimiento de las labores de las fuerzas armadas y la ampliación de sus facultades son signos preocupantes de militarización, sin importar cómo se los asocie al concepto de seguridad nacional. Nos encontramos, pues, ante una larga serie de acciones efectuadas durante décadas con las que se ha fortalecido paulatinamente el papel de las instituciones castrenses. En México no es un proceso privativo de un partido político, sino una dinámica sostenida durante ya cuatro administraciones presidenciales de distinto signo partidista, que han concedido a las instituciones militares un rol, recursos y una confianza superior de las dispensadas a las instituciones civiles, difundiendo pa-
ralelamente entre la sociedad un discurso que asegura una supuesta incorruptibilidad de todo cuerpo castrense, lo que constituiría su principal fuente de legitimidad. A los riesgos que entraña este proceso ante el debilitamiento del ethos y la institucionalidad democrática del país, hay que sumar su probada ineficacia como mecanismo de aseguramiento de la seguridad pública. Hoy, el despliegue de las fuerzas armadas de manera generalizada, sin prácticamente controles sobre su ejercicio y uso de la fuerza, no ha logrado revertir de manera sostenida los índices de violencia ni instrumentar una política de pacificación permanente que permita el combate real a la macrocriminalidad y la reconstrucción de los tejidos sociales. Por el contrario, a 19 años del despliegue de los cuerpos militares en labores de seguridad pública en el país, el saldo es más territorios ausentes del control institucional; y, en cambio, una larga lista de casos en que la letalidad de la intervención de las fuerzas armadas ha incrementado el adeudo estatal en acceso a la justicia. Hechos de meses recientes, como los asesinatos de seis migrantes en Chiapas, de dos jóvenes en Chihuahua, de dos civiles en Nuevo Laredo, y tantos más casos de ejecuciones extrajudiciales o de detenciones arbitrarias –especialmente contra migrantes– dan muestra de la ineficacia que hasta la fecha han mostrado las fuerzas armadas como instrumento para la pacificación del país. Evidencia de ello es que la Guardia Nacional y la Sedena fueron en el sexenio anterior dos de las instituciones con más quejas ante la CNDH.
LILIANA GARCÍA SÁNCHEZ*
Hombre de izquierda imprescindible en la historia social mexicana del siglo XX, orador sencillo y carismático, impulsor de las luchas agrarias en la sierra de Chihuahua. Buscando el bien de campesinos y trabajadores, mantuvo relación con todo nivel de gobierno y aunque pudo obtener riquezas, las cuales rechazó con honradez e integridad, aunque su trabajo benefició a miles con una parcela, él nunca fue dueño de una. Jacinto López nació en Banamichi, Sonora, el 3 de marzo de 1906. Su niñez estuvo marcada por la Revolución: violencia, despojos y reacomodos en lo agrario, económico y político. Los obreros y campesinos sonorenses estaban cansados del despojo de aguas y bosques consumado por latifundistas y extranjeros; eso alimentaba movimientos sociales y la convicción de hombres como Jacinto López, Ramón Oquita, Pascual Ayón o Maximiliano López.
La atención de la crisis generalizada de violencia e inseguridad pasa por el fortalecimiento de las instituciones civiles
Lo que está en juego no es sólo la crisis de violencia, sino también, la agenda misma de fortalecimiento democrático, promoción de los derechos humanos, pacificación y reconciliación social. Como han señalado numerosas voces especializadas y organizaciones defensoras de las víctimas y de los derechos humanos: la ruta para una adecuada pacificación del país apunta en una dirección contraria a la que han promovido los últimos tres gobiernos federales y que el actual profundiza con esta nueva reforma legal. No podemos cansarnos de repetir que la atención de la crisis generalizada de violencia e inseguridad pasa por el fortalecimiento de las instituciones civiles, por el cuidado, la capacitación y la profesionalización policial, por la reforma de las fiscalías y el Ministerio Público para garantizar el efectivo acceso a la justicia, por la adopción de estrategias de seguridad regionales diseñadas a partir del conocimiento profundo de los contextos específicos por la adopción de un enfoque de prevención que atienda las causas estructurales de la violencia, y por la limitación del uso de las fuerzas armadas de manera extraordinaria, estrictamente temporal y con los debidos controles institucionales tanto internos como externos.
A los 15 años se hace zapatero en Cananea. Platicando con sus clientes mineros, se imbuyó del pensamiento sindicalista; fue expulsado del municipio por organizar la cooperativa de zapateros; entonces dijo: “Algún día volveré a Cananea a luchar para que ese odioso latifundio y esa compañía minera vuelvan al seno de la patria” (Humberto Ochoa Bustamante. Biografía de Jacinto López Moreno. Editoria Nacional, Hermosillo, Sonora, 1991). Tenía 22 años y tiempo después lo cumplió. En Hermosillo, Jacinto fundó sindicatos de albañiles y de la Cervecera de Sonora. Es enviado a Nayarit castigado por Rodolfo Elías Calles, entonces gobernador de Sonora. Allá conoció a otro rebelde “castigado” de Baja California, Braulio Maldonado. “Colgados” en un tren, volvieron juntos al Valle del Yaqui; amistad que perduraría en luchas posteriores. Para los años 30 recorría la región Yaqui y Mayo promoviendo la organización campesina, sembrando cariño y lealtad. Esto llegó a oídos de Cárdenas, quien envía a Lombardo Toledano para agilizar el reparto agrario y promover el ejido colectivo. Jacinto se desenvolvía como estratega conocedor de los mecanismos políticos e incluso diplomáticos, y no como un “rebelde radical”, como muchas veces se le acusó. Jacinto López encarna el espíritu de unidad entre obreros y campesinos, que se quiebra por la acción cardenista (CTM-CNC); Fidel Velázquez rompe con Lombardo Toledano, quien con Jacinto y otros líderes forman la Alianza de Obreros y Campesinos, antecedente de la UGOCM y base del Partido Popular (PP), atrayendo a la disidencia de la CTM. En 1949 Jacinto fue candidato a la gubernatura de Sonora por el PP; su campaña mostró tácticas políticas efectivas, fuerte impacto popular e impecable organización con propaganda en yaqui (Miguel Ángel Grijalva. Jacinto López Moreno. Biografía de un agrarista sonorense. Tesis de maestría. El Colegio de Sonora, 2012, pp. 90 y 91). Ante el fraude del PRI, los miembros del PP protestaron en Hermosillo y tomaron el Jardín Juárez en plantón
permanente. Ahí llegó Alejandro Suárez Ibarra a ofrecerse como secretario de Jacinto, nunca se separarían. Jacinto fue secretario general de la UGOCM. En 1952 encabeza la lucha contra el latifundio Green en Cananea, exigiendo su disolución y reparto, cumpliendo su promesa de 1928: en 1958 Jacinto y la UGOCM toman y reparten miles de hectáreas del latifundio en tres estados; fue decisivo el apoyo de los gobernantes de Sinaloa, Gabriel Leyva, y Braulio Maldonado, de Baja California, así como las estrategias yaquis. Jacinto cae preso por seis meses. Cuando sale libre es para seguir exigiendo el reparto de las tierras expropiadas; la gente lo esperó lealmente. Contaba Suárez Ibarra: “Jacinto López, sin levantar demasiado la voz, se puso enfrente del contingente de campesinos, quienes con un grave silencio esperaban las palabras de su líder. “‘¡Pues vámonos, compañeros!’ “‘Vámonos, vámonos, vámonos...!’, coreaban los hombres emocionados, lanzando al aire sus sombreros” (Alejandro Suárez Ibarra. Grabaciones inéditas de Ricardo Montejano).
Jacinto apoyó a las normales rurales que participaron en Madera en 1965
En 1962, Jacinto es diagnosticado de tuberculosis a causa de la humedad de la cárcel; con el espíritu rebelde intacto, logra la dotación de tierras en el Valle del Yaqui; como diputado por el PP abrió las puertas del Departamento Agrario. López Mateos le ofrece la Secretaría de Agricultura y Ganadería. “Lo acepto”, contestó Jacinto, “con una condición: que los campesinos tengan libre militancia, si quieren ser del PRI, del PPS, Partido Comunista, donde quieran militar”. La secretaría no fue para él. Jacinto apoyó a las normales rurales que participaron en Madera en 1965; el grupo de los agraristas de Madera recibe el refuerzo de la gente de Jacinto, entre quienes están Arturo Gámiz, Alejandro Suárez y Álvaro Ríos. Le dolió la muerte de Lázaro Cárdenas, que simbolizó el fin de una época en la izquierda mexicana. Lombardo Toledano falleció en 1968, Jacinto y él se habían distanciado y no tuvieron ocasión para hacer las paces. Los pulmones de Jacinto colapsaron el 3 de mayo de 1975, para no volver a gritar “¡Vámonos!” entre vítores y sombreros voladores. Lo querían sepultar en Cananea, en Banámichi, en Ciudad Obregón, en Hermosillo, donde finalmente su cuerpo descansó el 5 de mayo, ante miles de campesinos y en medio de un sonar fúnebre de tambores yaquis.
*Autora de Cantar de fuego
TATIANA COLL
En el puerto de La Habana está un barco con toneladas de arroz, fondeado y esperando a descargar. Tal vez no llegue a descargar, porque para hacerlo debe recibir una señal de la central comercial que lo contrató, de que ha recibido en pago 60 mil dólares. Para que los 60 mil dólares lleguen a esa central, que puede estar en cualquier parte del mundo porque es muy difícil conseguir barcos que acepten trasladar mercancía a Cuba, La Habana tiene que realizar operaciones casi clandestinas a través de una serie de movimientos camuflados, para no ser detectados por los sistemas estadunidenses de vigilancia de las transacciones cubanas. Si los 60 mil dólares logran dicha hazaña y llegan a la cuenta de la empresa, el barco descargará el arroz; si no, dará media vuelta y se irá. El cargamento puede ser también de harina de trigo, de petróleo, de repuestos, de insumos para fabricar medicamentos, celulosa de papel, o tantísimas otras cosas que se requieren para sostener la vida básica, social, cultural, económica de la isla. El pago se tiene que efectuar siempre así para evadir a los perros fiscales internacionales que los yanquis han desplegado desde hace muchos años para el control financiero. Este control financiero hace que Cuba sea un país sin acceso a créditos, sin préstamos de ningún tipo, todo lo tiene que pagar de contado al momento, en un mundo de libre mercado y paraísos financieros. En México podemos hacer una transferencia bancaria a cualquier país, en cualquier banco, pero a Cuba no se puede, ningún banco lo hace. Esta es una parte poco visible del bloqueo
impuesto, pero ciertamente devastadora. No sólo por la escasez que impone, sino también por el encarecimiento de todo producto, las compañías y barcos que deciden tomar el riesgo de llevar a Cuba algo se aprovechan y duplican precios. En la pandemia, por ejemplo, los aparatos de oxígeno, las jeringas y medicamentos tuvieron que comprarlos al doble o triple, cuando se conseguían. Hay 37 maravillosas escuelas de arte que hacen milagros para seguir en pie, hay 2 mil 300 instituciones culturales, ¿cómo conseguir violines, guitarras, óleos, telas, zapatillas de ballet? ¿Cuánto cuesta traer tenis, balones, mantener canchas, para el deporte?
Cuba es una gran isla, pero, como todas las del Caribe, su entorno impone condiciones muy limitadas de producción. Siempre ha tenido un talón de Aquiles en la carencia energética, la escasa diversidad alimentaria, la necesidad de materias primas de todo tipo para sostener la posibilidad de producción nacional. Sin energía evidentemente nada se mueve: ni un pequeño ventilador casero, ni el transporte, ni las fábricas, elevadores, comercios, Internet, todo se apaga. En los años 80 la URSS propuso construir una planta de energía nuclear, pero su desaparición dejó abandonada una enorme construcción presa de los huracanes que la van desmantelando. México, país petrolero, nunca ha querido establecer un intercambio que podría ser beneficioso: proveer petróleo que sería refinado, por ejemplo en la refinería Ñico López y regresado a nuestro país como gasolinas. Se firmaron acuerdos con Centroamérica para abastecer de petróleo, pero nunca con Cuba. El centro de las actividades de la Promotora de Solidaridad ¡Va por Cuba! fue precisamente ese: petróleo para Cuba desde México. Hoy día el desmantelamiento de
ABRAHAM NUNCIO
El Tribunal Russell fue creado desde la sociedad civil (1966) en respuesta crítica a la incapacidad de la ONU –la misma de hoy– para responder a su principal objetivo, que es mantener la paz entre las naciones, y al silencio cómplice o la participación activa de los gobiernos de algunas de ellas en actos lesivos de los derechos humanos. El tribunal cobró gran influencia en torno a los crímenes perpetrados por EU en el sudeste asiático durante la guerra de Vietnam.
La iniciativa del filósofo británico Bertrand Russell fue asumida por Jean-Paul Sartre y varios de los intelectuales, artistas, académicos, políticos y activistas más destacados de la época: Simone de Beauvoir, Noam Chomsky, Lelio Basso, Lázaro Cárdenas, Frantz Fanon, Léopold Sédar Senghor. Éstas y otras personalidades representativas de
cuatro de los cinco continentes (no había ninguno de Australia) actuaron como jueces y testigos en diferentes casos de violación de derechos humanos; tuvo, por lo mismo, una vasta difusión.
El Tribunal Russell se actualizó en la fundación del Tribunal Permanente de los Pueblos (1979) y ante las atrocidades de las dictaduras en América Latina contra los derechos humanos y la ausencia de instancias oficiales para protegerlos, según la reseña de Magdalena Gómez para La Jornada (11/10/11).
Ante la probable inminencia de la tercera guerra mundial, urge la creación de un organismo similar al Tribunal Russell, que enjuicie al capitalismo de guerra, causa fundamental del armamentismo empresarial y su uso premeditado, alevoso, abusón, en suma criminal, por los gobiernos que hoy atizan lo que puede ser ese terrorífico y cruel neoholocausto de millones de seres humanos. Las armas de efectos letales masivos no han tenido otro objetivo que enriquecer a los fabrican-
En medio de la locura imperial que invade a los gringos, nos preocupa muchísimo que la respuesta a la pregunta de ¿qué más van a implementar? sea el bombardeo sobre la isla valerosa y solidaria
tes de armamento y despojar a los países vencidos de su territorio y sus bienes. Nada más monstruoso –y hasta hoy impune, al menos en el plano de la conciencia moral de la humanidad–.
Es preciso, en ese sentido, recuperar la memoria de lo que significó la Segunda Guerra Mundial y el papel que en ella jugaron empresas alemanas (apoyadas por los medios corporativos) y sus beneficiarios y cómplices en el gobierno. Tyssen, Krupp, Siemens, Volkswagen, Flick, IG Farben y sus socias y subsidiarias (Bayer, Hoechst y Schering) fueron juzgadas y condenadas en los juicios de Nuremberg por crímenes contra la humanidad, esclavismo y participación en mengelescos experimentos biológicos con los prisioneros en los campos de concentración.
Salvo IG Farben, que fue disuelta, las otras empresas juzgadas apenas salieron raspadas, pues a quienes se enjuició con severidad fue a sus directivos. Como vemos, ellas continuaron en el mercado como si nada. No sería improbable que su capacidad y experiencia las volvieran a poner al servicio del abyecto ímpetu armamentista de Europa, para jugar un papel semejante al que jugaron con el régimen de la Alemania nazi.
En el banquillo de los acusados de Nuremberg estuvieron ausentes, por crímenes contra la humanidad, Union Carbide
Pemex ha dejado saldos increíbles, por ejemplo: el 30 de mayo se encontraron 3 millones de litros de huachicol en Tabasco, ahora son bienes malversados y recuperados: ¿no podrían enviarse a Cuba?, ¿no podríamos abrir formas de abastecer a la isla? El petróleo que requiere Cuba es realmente mínimo en relación con nuestra producción. Hasta el mínimo detalle es observado y bloqueado su desarrollo por esta fétida, malsana, arbitraria y despótica determinación de EU. Los cubanos se preguntan con azoro: ¿Qué más van a inventar? ¿Qué otra medida aparecerá? Empezaron gravando las remesas, que de por sí enviarlas a Cuba es una hazaña. Este mes impusieron dos nuevas: se restringe la entrada de ciudadanos a EU, 12 países fueron avisados, entre ellos Cuba y Venezuela; así dijo Trump: “No permitiremos que entren personas que quieren perjudicarnos”. Ahora ya no son bienvenidos cuando antes se fomentó de diversas maneras su salida ilegal. Ahora incluso los deportan a países como Sudán. Otra medida absolutamente arbitraria es decidir que no se otorgará visa a los funcionarios de terceros países que contraten médicos cubanos. Una amenaza que espero no asuste a los directores del IMSS y el Issste, ni al secretario de Salud en México. Los médicos cubren plazas que no tenemos cómo llenar y realizan una labor indispensable. Sólo la derecha-facha de nuestro país se hace eco de esta sandez. En medio de la locura imperial que invade a los gringos, que sueltan bombas por todas partes, nos preocupa muchísimo que la respuesta a la pregunta de ¿qué más van a implementar? sea el bombardeo sobre la isla valerosa y solidaria. Sería una aberración histórica, abyecta frente a cualquier noción civilizatoria.
y DuPont, firmas participantes en la fabricación de las bombas (Little Boy y Fat Man) lanzadas sobre Hiroshima y Nagasaki. Ausentes también estuvieron los responsables del proyecto: el científico J. Robert Oppenheimer y el militar Leslie Groves, general a cargo del Cuerpo de Ingenieros del Ejército de EU. Y, por supuesto, Harry S. Truman, entonces presidente de esta potencia, quien dio la orden criminal de emplear las macrodestructivas bombas. Su ausencia sólo se explica por la etapa bárbara de la humanidad en la cual aún vivimos y a la cual se le sigue rindiendo culto con actos semejantes en nombre de la “civilización”.
Hoy son otras empresas las que cumplen un papel similar: Lockheed Martin, Raytheon, Northrop Grumman, General Dynamics, Boeing, sobre todo por su relación con el Congreso estadunidense.
Los gobernantes y las élites políticas de Occidente sabían que el régimen nazi se preparaba para hacer efectivo su proyecto de conquista, pero nada hicieron para impedirlo. Actuaron reactivamente cuando el afán conquistador era un hecho consumado. Así se inició la Segunda Guerra Mundial. Hoy es peor: las provocaciones, avances y destrucción humana y ecológica se muestran a la mirada de todo mundo en vivo.
El reservorio de ciertos valores que fue Europa se ha convertido en su opuesto: conductas cobardes, oportunistas y cómplices del genocidio de Israel en Gaza, y sometidas al dominio del capitalismo de guerra con epicentro en EU y sus guerras de agresión y rapiña anunciadas como show Los gobiernos del mundo, con muy honrosas excepciones, han sido incapaces de señalar siquiera los proyectos de conquista del eje malvado y genocida que hoy encabezan los nuevos Hitler y Mussolini de Occidente y Oriente. De aquí la urgencia de conformar un tribunal ciudadano que juzgue el negocio de la guerra. Si el capitalismo es ya un peligro en sí para la supervivencia del planeta y sus especies, el capitalismo de guerra implica que sus efectos sean más inminentes, aterradores y dolorosos. Ese tribunal no requeriría inventar el agua tibia. Reunir documentos y testimonios de las empresas y gobiernos que se dedican a propiciar, publicitar, fabricar y usar armas de destrucción masiva será suficiente para enjuiciarlas y emprender una campaña permanente de información pública para crear una conciencia colectiva en todo el mundo sobre quiénes son y qué hacen quienes atentan contra la humanidad produciendo historias, narrativas, políticas y máquinas de guerra bajo el pretexto de defender su seguridad nacional.
DORA VILLANUEVA
El Departamento del Tesoro de Estados Unidos lanzó su primer dardo contra el sistema financiero mexicano, al señalar a tres instituciones: CIBanco, Intercam y Vector, como facilitadoras de lavado de dinero de los cárteles de la droga, por un monto de al menos 46 millones 591 mil dólares. Entre los argumentos que presentó la autoridad estadunidense se encuentran los sobornos a Genaro García Luna, secretario de Seguridad Pública cuando Felipe Calderón ocupó la Presidencia.
La sanción emitida por la Red de Control de Delitos Financieros (FinCEN) prohíbe cualquier transferencia de fondos que involucre a estas instituciones financieras, pero sólo afecta a las empresas mexicanas, no a las filiales que Intercam tiene en ese país, ni tampoco a la rama global de Vector, también con registro ante las autoridades de Estados Unidos, y menos a los bancos corresponsales estadunidenses (como Pershing, LLC, subsidiaria de Bank of New York Mellon) que venían trabajando con sus pares mexicanos.
En la primera sanción que se aplica bajo la Ley de Erradicación del Fentanilo y Disuasión de Narcóticos, en vigor desde el último año de la administración de Joe Biden, el Tesoro señala a CIBanco, Intercam y Vector de ayudar a lavar dinero del cártel Jalisco Nueva Generación (CJNG), el cártel de Sinaloa, el cártel del Golfo y el de los
Beltrán Leyva, que desde el 20 de febrero también son consideradas “organizaciones terroristas” por el gobierno de Estados Unidos. CIBanco, Intercam y Vector “han desempeñado conjuntamente un papel vital y de larga data en el lavado de millones de dólares para cárteles con sede en México y en la facilitación de pagos para la adquisición de precursores químicos necesarios para la producción de fentanilo”, señaló el Tesoro. Scott Bessent, secretario de esta dependencia, describió a estas instituciones como “piezas claves en la cadena de suministro de fentanilo”. Como parte de los documentos oficiales, con los que el Tesoro da 21 días a las instituciones financieras de su país a fin de “prepararse para la prohibición”, se señalan varias transferencias entre empresas chinas y mexicanas como parte de una supuesta asociación comercial que lleva a la producción de fentanilo y su tráfico a Estados Unidos. En algunos movimientos sí se presentan indicios delictivos, en otros sólo se criminaliza el comercio ChinaMéxico.
Al dar cuenta de los hallazgos sobre cada una de las financieras mexicanas sancionadas, la FinCEN señaló que “CIBanco ha sido fundamental en la facilitación de pagos en nombre de empresas con sede en México involucradas en la adquisición de precursores químicos para fines ilícitos”. En particular lo acusa de ser socorrido por el cártel de los Beltrán Leyva, el CJNG y el
Sucursales de CIBanco e Intercam en la Ciudad de México Fotos Afp
del Golfo para comprar precursores químicos a compañías chinas, lo mismo que para esconder sus recursos en Suiza.
El Tesoro respalda su veto contra CIBanco en que “de hecho, dado su tamaño y limitada presencia internacional, los servicios comerciales legítimos que ofrece estarían fácilmente disponibles a través de otras instituciones reguladas”, un argumento que se repite a calca en las acciones contra Intercam y Vector. En el caso de Intercam, la FinCEN presenta transacciones de comercio exterior en las que presume el tráfico de fentanilo para fines ilícitos, por cerca de 8 millones de dólares, pero también lo describe como una pieza “fundamental en las operaciones de las mulas de dinero para repatriar fondos ilícitos a México en nombre de las organizaciones narcotraficantes”; al menos 7 millones 100 mil dólares, todo como parte de la operación del CJNG Sin embargo, la sanción sólo aplica a Intercam en México, pese a que la empresa es propietaria de un banco con sede en Estados Unidos (Intercam Banco Internacional con constitución en Puerto Rico) y tiene otras subsidiarias: Intercam Futures, Intercam Wealth Management Group, Intercam Advisors e Intercam Securities.
Las “subsidiarias de Intercam


con sede en Estados Unidos quedan fuera del alcance de esta orden”, recalca el documento del Tesoro. En 2015, FinCEN informó a la Comisión Nacional Bancaria y de Valores (CNBV) sobre “diversas actividades constitutivas de lavado de dinero, incluyendo transacciones procesadas por Intercam que implicaban compras sospechosas de cheques de caja en la frontera entre Estados Unidos y México, posible actividad en cuentas de canalización y posible lavado de dinero relacionado con el comercio”. En ese momento hubo sanciones y el hallazgo de más de una decena de delitos, sin que el caso llegara a más. Luego de esa primera alerta, FinCEN analizó las referencias a bancos y casas de bolsa mexicanos regulados entre 2022 y 2024, a partir de información reservada que le proporcionó la CNBV, e “Intercam
ocupó el primer lugar en el análisis ponderado por activos de actividad potencialmente ilícita” en el sistema financiero mexicano.
En el caso de Vector, el Tesoro lo acusa de haber proporcionado servicios financieros en beneficio de los cárteles de Sinaloa y del Golfo. Sin embargo, además de 17 millones de dólares en “transferencias electrónicas sospechosas a varias empresas con sede en China”, lo señala de ser el canal para los sobornos que llegaron a García Luna, preso en Estados Unidos por narcotráfico y delincuencia organizada. Además de los “millones de dólares” en sobornos que el cártel de Sinaloa pagó a García Luna, FinCEN halló que entre 2013 y 2019, una empresa controlada por el ex secretario de Seguridad Pública realizó transacciones con Vector por más de 40 millones de dólares.
La Secretaría de Hacienda y Crédito Público fue informada previamente por el Departamento del Tesoro sobre presuntos vínculos de CIBanco, Vector e Intercam con actividades de lavado de dinero de los cárteles de la droga, pero no recibió pruebas al respecto y más allá de algunos “problemas administrativos” que fueron sancionados con multas por 134 millones de pesos, no se acreditaron actividades ilícitas, informó la dependencia en un comunicado.
“Queremos ser claros: de contar
con información contundente que pruebe actividades ilícitas de estas tres instituciones financieras, actuaremos con todo el peso de la ley; sin embargo, a la fecha no contamos con ninguna información en este sentido”, respondió el sector hacendario de México, luego de que el Departamento del Tesoro impuso sanciones administrativas y civiles a CIBanco, Intercam y Vector por presuntamente facilitar a los cárteles de la droga el lavado de dinero asociado al tráfico de fentanilo y otros opioides sintéticos. El Tesoro advirtió a Hacienda y a su Unidad de Inteligencia Financiera (UIF) sobre la presunta coo-
peración ilícita de las instituciones del sistema financiero mexicano con el cártel Jalisco Nueva Generación, el cártel de Sinaloa, el cártel del Golfo y el de los Beltrán Leyva. En ese intercambio de información, las autoridades mexicanas pidieron pruebas. Sin embargo, sus pares estadunidenses no las enviaron, más allá de algunas transferencias electrónicas realizadas por conducto de CIBanco, Intercam y Vector con empresas chinas legalmente constituidas.
“La UIF encontró transacciones realizadas con dichas empresas chinas por más de 300 empresas mexicanas a través de 10 institucio-
nes financieras nacionales”, expuso la dependencia. Nada fuera de lo rutinario, dado que el comercio anual entre México y China alcanza 139 mil millones de dólares y estas transacciones se realizan por miles, apuntó.
Además de las investigaciones en la UIF, la Comisión Nacional Bancaria y de Valores inició un proceso de revisión a CIBanco, Intercam y Vector en el marco de la regulación nacional, pero sólo encontró problemas administrativos que en su momento fueron sancionados con multas por 134 millones de pesos, apuntó la dependencia, al tiempo de enfatizar
que todas las tareas de cooperación que se hacen con el Tesoro son entre pares. “La Secretaría de Hacienda tiene una relación de coordinación y diálogo con el Departamento del Tesoro en el marco del respeto a la soberanía, la responsabilidad compartida y la cooperación sin subordinación”, y aseguró que respecto al caso, la instrucción de la presidenta Claudia Sheinbaum es “ser transparentes, no encubrir a nadie ni nada y actuar conforme al estado de derecho, siempre que haya pruebas contundentes de cualquier anomalía administrativa o presunto delito”.
PREVÉN EFECTO LIMITADO EN ENVÍOS
La recaudación subiría en 900 mdd, 0.56% de la masa salarial migrante
BRAULIO CARBAJAL
De entrar en vigor el impuesto de 3.5 por ciento a las remesas desde Estados Unidos, alrededor de 3 millones 400 mil mexicanos que trabajan en ese país resultarían afectados; en tanto, el gobierno estadunidense recaudaría cerca de 900 millones de dólares en 2026, según estimaciones de Jesús Cervantes González, director de estadísticas económicas del Centro de Estudios Monetarios Latinoamericanos (Cemla). El especialista explicó que la Cámara de Representantes aprobó un plan tributario que incluye aplicar un impuesto de 3.5 por ciento a las remesas, que sería pagado por el remitente y recolectado por la compañía remesadora o cualquier otra entidad que haga el envío. La propuesta (que ya se encuentra en el Senado) dice que
este gravamen puede ser deducido o compensado por los remitentes con ciudadanía y por los inmigrantes.
Por ejemplo, si un ciudadano o inmigrante documentado paga 3.5 dólares de impuesto por enviar 100 dólares, esos 3.5 dólares podrían restarse de los impuestos que debe pagar al IRS (Servicio de Impuestos Internos) o, en algunos casos, incluso obtener un reembolso si es aplicable. Sin embargo, los inmigrantes indocumentados no tendrían acceso a este crédito fiscal, por lo que el impuesto sería un costo neto para ellos, sin posibilidad de recuperarlo.
De esta forma, explicó Cervantes González, de ser aprobado el proyecto de reforma como se encuentra, el impuesto de 3.5 por ciento se aplicaría a los migrantes indocumentados y entraría en vigor a en 2026. Destacó que el número de tra-
bajadores mexicanos en Estados Unidos ascendía al cierre de 2024 a 7 millones 549 mil 833, de los cuales 2 millones 419 mil 904, es decir, 32 por ciento, contaban con ciudadanía, en tanto que un millón 734 mil 200, o 23 por ciento, tenían documentos sin ciudadanía y 45 por ciento (3 millones 400 mil 729) eran indocumentados.
Este último grupo, de acuerdo con el proyecto de reforma, es el que estaría sujeto al impuesto de 3.5 por ciento.
Según Cervantes González, la recaudación por este cobro sería equivalente a 0.59 por ciento de la masa salarial de los trabajadores mexicanos indocumentados e implicaría una erogación adicional de 22 dólares mensuales para este segmento.
Destacó que en 2024 los migrantes mexicanos enviaron 16.73 por ciento de su masa salarial a sus familiares y con el impuesto
a las remesas esa proporción se incrementaría a 16.97 por ciento para el total de trabajadores mexicanos y a 17.31 por ciento para los que no tienen documentos.
Receptores conservarían poder adquisitivo
Para especialistas de Banamex, de aprobarse el impuesto, tendrá un efecto limitado en el flujo de remesas y, por tanto, en el consumo y crecimiento económico. Además, destacaron que la depreciación estimada del peso respecto a 2024 y la tendencia de la inflación a la baja permitirían que el poder adquisitivo de las remesas en pesos reales sea el mayor de los últimos cuatro años.
No obstante, destacó la institución financiera, la propuesta de gravar las remesas tiene un componente político importante que afecta a los más vulnerables.

ALONSO URRUTIA Y ALMA MUÑOZ
El gobierno federal prepara un esquema de reorganización de Petróleos Mexicanos, a partir de las reformas que se han aprobado en el sector, para “darle una nueva visión a largo plazo, financiera y en términos de la producción de la energía”, aseguró la presidenta Claudia Sheinbaum, quien ayer
tuvo una reunión con los directivos de la empresa para avanzar en este proceso, que será formalizado en breve. La mandataria explicó que Pemex arrastra una elevada deuda debido a que en los sexenios de Vicente Fox, Felipe Calderón y Enrique Peña Nieto esta empresa contrató una deuda muy importante. “Particularmente, durante el periodo de Peña, se generaron condiciones difíciles para Pemex. El
presidente Andrés Manuel López Obrador estabilizó y disminuyó la deuda de Pemex, y estableció un esquema de explotación de los pozos, y aparte invirtió de manera importante en refinación.
Durante su conferencia diaria, Sheinbaum dijo que además hay deudas con algunas empresas proveedoras; por eso se analiza un nuevo esquema de operación desde el punto de vista financiero y de funcionamiento.
Aumentó 22.6% anual la producción de gasolinas
ALEJANDRO ALEGRÍA
En mayo, Petróleos Mexicanos (Pemex) produjo 327 mil barriles diarios de gasolinas, lo que equivale a un aumento de 22.69 por ciento frente al mismo periodo del año pasado, de acuerdo con información de la empresa pública.
Con el resultado del quinto mes del año, suma un semestre en el cual el nivel de producción de carburantes para vehículos ligeros se encuentra por encima del promedio de 300 mil barriles diarios.
Aunque en su variación anual la elaboración de gasolinas mostró un avance, en comparación con abril se observó un descenso de 16 mil barriles cada día, equivalente a 4.85 por ciento.
El mayor volumen de la elaboración de gasolinas, así como de otros petrolíferos de Pemex, entre ellos el diésel, se explica por el programa de mantenimiento de tiene la empresa estatal como parte del Sistema Nacional de Refinación (SNR), el cual está enfocado en plantas de conversión para incrementar la producción de destilados.
Entre enero y mayo de este año, la petrolera prometió entregar 325 mil barriles diarios de gasolinas elaboradas, un aumento de 6.13 por ciento respecto a igual periodo del año pasado, cuando la empresa estatal reportó una producción de 306 mil barriles.
Se mantiene la de diésel
En el quinto mes de 2025, Pemex produjo 215 mil barriles diarios de diésel, lo cual se tradujo en un crecimiento de 49.03 por ciento frente a los 144 mil reportados en igual lapso del año pasado.
Además, en el periodo de referencia, en 30 mil barriles diarios la producción de este combustible, utilizado principalmente para transportes pesados, lo que significó un incremento de 16.42 por ciento respecto a abril.
En los primeros cinco meses del año, la petrolera elaboró en promedio 181 mil barriles de diésel al día, nivel prácticamente igual que en igual lapso del año pasado.
▲ Consolidar las finanzas de Pemex a largo plazo es uno de los principales objetivos del proyecto de restructuración de la empresa. Foto La Jornada
Agregó que este proyecto financiero y de visión de largo plazo para la empresa estatal se ha estado preparando desde antes de que ella tomara posesión de la Presidencia, y se piensa presentarlo en breve.
Durante la conferencia con inversionistas y analistas para presentar los resultados del primer trimestre, directivos de Pemex mencionaron que en el periodo mencionado la empresa pública reportó una disminución en la producción de combustóleo de 320 a 241. Entre enero y mayo de este año, la petrolera estatal elaboró en promedio 234 mil barriles diarios de este energético, que es utilizado para la generación de electricidad (pero es altamente contaminante), lo cual representó una caída de 21.57 por ciento respecto a igual periodo de 204. Esto también significa que se aprovecha más el crudo para elaborar otros productos petrolíferos.
Jueves 26 de junio de 2025
CIENCIAS CULTURA ESPECTÁCULOS

LA ASISTENCIA DEL público a las funciones de ópera muestran un panorama alentador, con localidades agotadas, incremento y renovación de público, así como repertorios balanceados y audaces. En esto coinciden investigadores, críticos y aficionados. Marcelo Lombardero, al frente de la Compañía Nacional de Ópera, destaca
que una programación con propuestas contemporáneas a veces es arriesgada: “el público tradicional es un poco reticente a esos espectáculos. Nuestro foco es tener una mirada diversa”. En la imagen, escenas de la obra Rigoletto Foto cortesía CNO-Inbal CULTURA / P 2a y 3a
“Los boletos son más baratos que los de futbol o un concierto de pop”: investigador musical

Los informes pintan un panorama alentador: boletos agotados, incremento y renovación de público, y repertorios balanceados y hasta audaces. Pero tras el aparente nuevo auge de la ópera en México, hay debates fundamentales.
En ello coinciden investigadores, críticos y aficionados tras las recientes afirmaciones oficiales acerca de un fortalecimiento de ese género lírico, encaminado a crear nuevas audiencias.
Claudia Curiel de Icaza, titular de la Secretaría de Cultura federal, destacó hace unos días que, en los últimos ocho meses, el Instituto Nacional de Bellas Artes y Literatura (Inbal) ha presentado 26 funciones operísticas –10 en el Palacio de Bellas Artes y 16 en otros espacios–, que reunieron a más de 20 mil asistentes.
“Uno de nuestros compromisos
es crear nuevos públicos en un género que pudiera parecer sólo para especialistas”, afirmó la funcionaria al referirse a la gran cantidad de “jóvenes, gente nueva” que, según ella, fue atraída por Lady Macbeth de Mtsensk y Rigoletto, los dos primeros montajes de este año de la Compañía Nacional de Ópera (CNO) en el Palacio de Bellas Artes. El historiador e investigador musical Octavio Sosa –asiduo a las producciones operísticas desde hace más de medio siglo– confirma la versión oficial: “Se ha incrementado el público en general, pero sobre todo el de jóvenes. Los boletos son muy accesibles, más baratos que los de futbol o un concierto de pop”. Sin embargo, el ex titular de la CNO aclara que tal fenómeno tiene sus antecedentes a mediados de la década de 2000, cuando esa agrupación abrió sin costo los ensayos generales y “se atiborraban de público”, además de la expectativa por una programación que comenzó a salirse de los títulos del repertorio. “El incremento de asistencia va más allá de los últimos ocho o nueve meses”, afirma. “Lo que sí he visto es que, en este lapso, los boletos se agotan en cuanto se ponen a la venta”.
Salvador Méndez Padilla, responsable del supertitulaje de las producciones operísticas en Bellas Artes desde 1993 y aficionado al género desde 1967, observa que si bien las funciones están llenas de jóvenes, el público tradicional ha decrecido, en parte por el paso
natural del tiempo, pero también porque han perdido alicientes.
“Los legendarios cantantes que antes conformaban los elencos han disminuido en los últimos 20 años de manera acelerada. No es exclusivo de México; se ve en el resto del mundo”, explica el musicólogo y director desde 2006 del concurso Carlo Morelli, el certamen de canto más importante en el país.
“Para el público nuevo que no tiene esos parámetros resulta atractivo acudir a un espectáculo tan emocionante. Lo vemos en la propuesta de títulos nuevos –muchos de ellos estrenos nacionales–, más allá del repertorio canónico de la ópera. Así se ha dado un proceso paulatino de renovación en la audiencia.”
▲ Imágenes captadas en la función de Rigoletto, el pasado 8 de mayo en el Palacio de Bellas Artes. Fotos cortesía CNO-Inbal La programación de la CNO
El crítico musical José Noé Mercado pone la nota discordante y advierte lo complejo que es referirse a un incremento real de público. “Para tenerlo, la CNO debería hacer más funciones anuales que en el último cuarto de siglo, lo cual no sucederá, entre otras razones porque el Palacio de Bellas Artes está repleto de actividades multidisciplinarias. No hay espacio para más”, argumenta. “Las funciones anuales en este siglo no han sido ni 35. Son, de hecho, menos. Estamos a mitad de año y no han alcanzado ni 15. Es cues-

tión de hacer números. También hay que considerar a la población de la Ciudad de México o del país para pensar si echamos las campanas al vuelo como Shakira con sus localidades agotadas y el número de asistentes a sus conciertos. Eso nos daría humildad y perspectiva para poner los pies en la tierra.”
El también escritor –quien acude a la ópera desde hace casi tres décadas– sostiene que la tendencia mundial de asistentes a ese género ha ido en declive en años recientes.
“En Europa, los aficionados han envejecido y las productoras tienen problemas para renovar ese gusto en las nuevas generaciones ante la diversidad de entretenimientos y, cuando ocurre, los jóvenes se encuentran con precios de boletos que no necesariamente pueden permitirse. ¿La CNO va contra esa
tendencia mundial en muchos casos crítica?”
Sosa atribuye la actual avidez por el arte lírico a una acertada programación que equilibra títulos nuevos y audaces –incluso estrenos en el país o América Latina, como es el caso de Un re in ascolto, que la CNO presentará en tres funciones a partir del 1º de julio para celebrar el centenario natal de Luciano Berio– con los ya probados, como La Bohème o Turandot También destaca el papel de la tecnología, en específico las transmisiones en vivo del MET de Nueva York en el Auditorio Nacional, y que por la pandemia “muchos se dedicaron a ver ópera o la descubrieron en esos momentos, a través de plataformas digitales”.
/ 2A P
Méndez Padilla también considera que el giro en la programación ha sido crucial para captar nuevos adeptos, los cuales comenzaron a hacerse más evidentes a raíz de la renovación en el Palacio de Bellas Artes hace unos 15 años.
“No son sólo los ‘caballitos de batalla’ –las obras del repertorio–, hay una buena oferta en años recientes encaminada a repertorio más contemporáneo. Esto atrae más al público joven que al tradicional que acudía desde hace décadas.”
Otro factor esencial, dice, es la incorporación desde 1992 del supertitulaje: “La gente entiende todo lo que se canta y lo vive en su parte teatral, emocional, y no sólo en la música. Este recurso ha permitido que muchísima gente se acerque sin tanta cautela a la ópera”.
Dejar atrás administraciones anteriores de la CNO “ha sido un aliciente”, según José Noé Mercado, quien al igual que Sosa y Méndez Padilla celebra la llegada del argentino Marcelo Lombardero –“un personaje experimentado en diversos ramos del ámbito operístico”– a la dirección artística de esa agrupación en el actual sexenio.
Sin embargo, cuestiona: “¿Era necesario un personaje importado para lograrlo? ¿Nuestro quehacer operístico no ha creado a lo largo de los años un perfil con esa visión y capacidad de mando?”
En su opinión, el planteamiento de la actual temporada, que anuncia algunos títulos contemporáneos con otros clásicos, “probablemente también ha sacudido al público de su letargo o desinterés”.
Aunque, resalta, “muchos operófilos han dejado de ir al Palacio de Bellas Artes y han confesado su hastío, al parecer ya insalvable, por la programación de los últimos años”. Y agrega: “Entonces, ¿quiénes han asistido a esas funciones agotadas? ¿Se han vendido esas entradas o se han destinado a invitados? No me parece criticable que se aprovechen los lugares, pero ¿quiénes lo hacen y con qué criterio? ¿Vuelven a la ópera, se aficionan a ella?”
Si bien considera que no puede hablarse de una nueva época de oro de este arte en México, Sosa subraya el auge que tiene también en Guadalajara, Monterrey, Mazatlán y Colima. “Esto no sucedía hace 15 años; todo estaba muy centralizado”. A partir de ello, el historiador e investigador musical ve con optimismo el futuro.
Para Méndez Padilla, la ópera en México “sí está en una época de oro, porque en algún momento se vivía cierta apatía. Se veían enormes huecos en la luneta y otras áreas de Bellas Artes y ahora las funciones ostentan el letrero de agotado”.
En tono crítico, José Noé Mercado finaliza: “Esas funciones que cuentan con buena asistencia o localidades agotadas podrían llevarnos a preguntar si la taquilla ahora sí será un parámetro de rendición de cuentas de gestión artística, o si incidirá en la asignación de menor o mayor presupuesto, o en el delineamiento de una programación específica, ya que en la actualidad –es decir, desde hace años–, en rigor, la taquilla no influye en la toma de decisiones ni en consideraciones sobre lo que se ofrece al público”.

“Apelamos a los públicos diversos”
ÁNGEL VARGAS
Al frente de la Compañía Nacional de Ópera como director artístico desde noviembre, Marcelo Lombardero considera que “hay que tomar con cautela” el reciente fenómeno de funciones llenas y boletos agotados con anticipación.
“Es muy prematuro para tener un análisis claro. Estamos transitando esta primera temporada; para mí, con mucho asombro positivo. Veo que ha funcionado desde la presentación inicial del año:
la sinfonía coral Romeo y Julieta, de Berlioz; agotamos las entradas rápidamente. Aunque no fue estreno en México, sí fue la primera vez que la Ópera de Bellas Artes hizo esa obra”, explica el director escénico y cantante argentino (Entre Ríos, 1964).
“La referencia a la creación de nuevos públicos no significa sólo que la sala esté llena; es decir, lo primordial es llenarla y agotar las localidades, pero si fuera sólo por eso no programaríamos ópera. Haríamos cosas masivas.”
En entrevista, el también gestor cultural –quien dirigió en su país el Teatro Colón, uno de los más importantes de ópera en Latinoamérica, y el Teatro Argentino de La Plata– advierte que suele confundirse lo masivo con lo popular y viceversa.
“Pero las cosas son distintas. La idea es que los espectáculos llenen salas y tengan éxito, pero también hablar a públicos diversos para ampliar el público”, sostiene.
“Gerard Mortier –director de la Ópera de París, entre otros grandes teatros– decía que en ocasiones era necesario que las salas estuvieran vacías. Es una metáfora: a veces es importante presentar espectáculos que a priori no tienen una masividad, pero son eventos culturales relevantes para cierto tipo de público.”
Entre las políticas para acceder a nuevas audiencias, Lombardero destaca la programación de propuestas arriesgadas, más contemporáneas, como Un re in ascolto (Un rey escucha), el próximo título que la CNO presentará en tres funciones a partir del 1º de julio en el Palacio de Bellas Artes.
“El público tradicional es un poco reticente a esos espectáculos porque espera ver sus obras preferidas, las cuatro o cinco que
se mantienen en el repertorio famoso: La Traviata, La Bohème, Carmen”, señala.
“Por otro lado, hay un público al que sí le interesa la música contemporánea o el teatro y la literatura modernos. Es por el que también apostamos, ese público que mira la ópera desde el prejuicio como un espectáculo vetusto. Sin embargo, ahora haremos esta obra con música de Luciano Berio y texto de Italo Calvino que será un estreno en Latinoamérica. Una experiencia musical, sonora y visual que muy pocas veces es posible presenciar.”
Sin fórmulas
–¿Hay que arriesgar entonces con propuestas que no siempre atraigan a los grandes públicos?
–Exactamente. Para mí, no sólo llenar cinco funciones, sino que se hayan agotado las entradas antes del estreno de Lady Macbeth de Mtsensk –ópera de Shostakóvich que era desconocida en México– y que eso haya trascendido el ámbito operístico, me parece un éxito.
“Nuestro foco es tener esta mirada diversa que abarque la mayor cantidad de públicos posibles: al que le gusta la ópera romántica, la clásica, las innovaciones, la modernidad, los crossovers entre distintos lenguajes como el teatro, la música y la danza.
“Es el sentido que le damos a la programación. Aún es muy prematuro dar un veredicto de cómo estamos. Creo que vamos bien. La fidelización y la creación de nuevos públicos deben sostenerse para generar lo que quisiéramos: una masa crítica. No buscamos que el público esté de acuerdo con lo que hacemos, sino que nos interpele.”
–¿Con qué proyecto llega a la CNO tanto para atender a los aficionados habituales como para crear nuevos?
–Es el gran desafío: no existe una fórmula. Tuve la fortuna de estar al frente de dos teatros muy importantes en mi país, y en ambos tuvimos éxito en las campañas que comenzamos. Aquí son situaciones y formas de producción distintas. Ahora estoy aprendiendo mucho, además de que tengo una gran experiencia en México por todo lo que hice aquí como director de escena.
“La programación es la manera con la que el director artístico habla a la comunidad; en ella está el

▲ Escenas de Lady Macbeth durante su presentación en el Palacio de Bellas Artes. Fotos cortesía CNO-Inbal
corte ideológico y la idea. Lo que intento siempre es, primero, tener un equilibrio entre la tradición y la experimentación; también, correr un poco el límite y ofrecer espectáculos novedosos, estrenos, obras que no se hayan hecho en el país, la ciudad o el teatro.
“Por otro lado, buscar la excelencia artística. Que la producción interese al público, pero que no le deje sólo la sensación de algo bonito, sino pensando, que lo sobresalte. La ópera es un gran espectáculo y así tiene que funcionar. Si no, no hay manera de captar al público. Además, hay que tener políticas muy agresivas de comunicación; hoy son fundamentales.” –¿Cómo hacer accesible la ópera al público no familiarizado?
–Hay varias líneas. Primero, apelar al público interesado, tratar de captar sus intereses en términos de la puesta en escena, de la lectura de la obra, de la elección del repertorio. Por otro lado, salir del Palacio de Bellas Artes, porque este tipo de recintos, por lo general, son expulsivos: el costo de las entradas, los códigos de vestimenta, el conocimiento previo que se requiere. Hay todo un público que no se acerca por temor, prejuicio o complejo. “La idea, entonces, es acercarnos, para lo cual el Estudio de la Ópera de Bellas Artes (EOBA) –la instancia de perfeccionamiento artístico de la CNO– es un arma fundamental. La pensamos como una especie de compañía ambulante; planteamos una serie de espectáculos que puedan viajar.
“Además, trabajamos en coproducciones con la UNAM para tener ese tipo de obras livianas, de interés general para la familia, o piezas con un sesgo teatral muy fuerte e interesante. Buscamos que les sirvan a los jóvenes cantantes del EOBA para hacer tablas, pero también brindar la posibilidad a los sectores que normalmente no acceden a estos espectáculos.”
ÁNGEL VARGAS
En las frías cifras oficiales proporcionadas a La Jornada, la Compañía Nacional de Ópera (CNO) ha registrado un subibaja de asistencia a las actividades que ha programado desde el fin de la pandemia por covid-19 hasta la fecha.
En 2022 captó a 16 mil 402 personas, de las cuales 11 mil 463 correspondieron a los cuatro títulos operísticos que presentaron durante el año en el Palacio de Bellas Artes: Juana sin cielo, Zorros chinos, Dido y Eneas y La carrera de un libertino, con cuatro funciones cada una.
Como parte de los 57 eventos presenciales de ese año, también se realizaron tres conciertos (Pasajes inmortales de la ópera, Navideño y Operístico), un recital, la 39 edición del Concurso de canto Carlo Morelli y talleres de repertorio del Estudio de Ópera de Bellas Artes (EOBA).
En 2023 fueron 151 eventos presenciales con 45 mil 621 asistentes; de estos últimos poco menos de la mitad (20 mil 538) correspondieron a las cinco óperas de la temporada anual: Orfeo y Eurídice, con cuatro funciones; Los pescadores de perlas, tres; Madama Butterfly, cinco; Florencia en el Amazonas, tres, y El elíxir de amor, cinco.
Asimismo, se efectuaron tres galas: la de la mezzosoprano letona Elina Garanča, apreciada por mil 358 espectadores; la del 40 aniversario del tenor Ramón Vargas, por mil 270, y la Conmemorativa del 40 concurso Morelli, por 853. Los 30 conciertos de la Orquesta de Cámara de Bellas Artes reunieron a 15 mil 796 espectadores.
Poeta de cantadores
“ N O HAY OTRA joven más bella / como esta flor de alhelí; / si muere, ¿qué haré sin ella? / Si muero, ¿qué hará sin mí?” ¿Qué importa que se haya sustituido, por razones de metro, un pronombre (“que”) por un adverbio (“como”)? La imagen y el sentimiento expresado pasan al lector (o al auditorio) incólumes, limpiamente. Como redactor, Juan Llanos Rodrigues (así, a la portuguesa aparece su segundo apellido al calce de cada canción o poesía en el libro que comentamos, De amores y argumentos, publicado por la Universidad Michoacana de San Nicolás de Hidalgo y Anona Books) es con frecuencia “incorrecto”, “descuidado”, pero como ser de imaginación, como poeta (popular, qué duda cabe), de vez en vez, muy bien y no tan espaciadamente, da en el clavo:
“PIDO LICENCIA, SEÑORES, / saludando en alta voz / a este portal de flores, / donde nació el Niño Dios”.
DE ESCASA ESCOLARIDAD, tercero de primaria, parte de su producción la dictó el autor, ya invidente, a su esposa Catalina y a su hija Juana, quienes no puntuaron los versos y no parece que pudieran cuidar atentamente la ortografía. De estas dos cosas se ocupó uno de los editores del libro, Raúl Eduardo González (el otro es el también ilustrador Alec Dempster).
EN DIVERSAS OCASIONES
se antoja disentir en cuanto a la primera, y no pocas –otra observación– de la redacción por ahora final de ciertas líneas (esto tomando en cuenta que Llanos “no pensaba”, sino tendía a improvisar sus versos, aparte de los posibles errores de oído de las amanuenses. No olvidemos (no olvidamos) que existen diversos modos correctos de puntuar un mismo texto. Y veamos cómo “restauradas” algunas coplas quedan “mejor”, ganan naturalidad; acaso restituida –atrevemos– su forma original. En el libro: “Estos versos que hoy le muestro / yo creo que no perjudique: / son compuestos por Juan Llanos, / de Juan de la Luz Enríquez”. Nuestra propuesta quiere que “le” sea “les” y que el segundo verso quede: “yo no creo que perjudiquen”. En el libro: “Un niño andaba pescando / cuando el resumo [por torbellino] llegó; en un árbol de tamari [sic] / de inmediato se subió”. Donde proponemos, tercer verso, “a un árbol de tamarindo”. Y –concluyamos–en el libro: “Por eso nada más ver, / dejar la bola rodar, / y que lo disponga Aquel / que es el padre universal”. Otra vez tercer verso: “y lo que disponga…”.
Y NOS VEMOS, no hay (el espacio se acabó) cómo más decir.
AFP BASILEA
La feria de arte de Basilea dibujó este año un retrato de un mundo agitado, mezclando grandes instalaciones sobre la búsqueda de la felicidad con obras relacionadas con la fragilidad de las democracias. Fundada en 1970 por el marchante de arte Ernst Beyeler y otros dos galeristas de Basilea, Art Basel es uno de los principales acontecimientos anuales del mundo del arte contemporáneo.
En su parte dedicada a obras monumentales, la feria presentó esta año una instalación de 85 metros de largo titulada The VoyageA March to Utopia (El viaje - Una marcha hacia la Utopía).
La obra, realizada por el taller del artista holandés Joep van Lieshout, incluyó 80 grandes esculturas que forman una procesión de objetos absurdos, donde “todos se
mueven en la misma dirección”, en “camino hacia un mundo feliz”, explicó el artista a Afp.
Otra de las obras fue del artista español Jaume Plensa, compuesta por 21 puertas en las que están grabados los artículos de la Declaración Universal de los Derechos Humanos aprobada por la Asamblea General de Naciones Unidas en 1948.
La obra Forgotten Dreams (Sueños olvidados) invitó a contemplar las aspiraciones colectivas y a no olvidar los horrores del pasado.
El artista danés Danh Vo, nacido en Vietnam, instaló una enorme bandera de Estados Unidos hecha de troncos de madera y decorada con 13 estrellas de acero, en referencia a la primera versión de la bandera estadunidense de 1777.
La obra fue creada en 2020, durante la campaña electoral que enfrentaba a Donald Trump con Joe Biden, y fue reconstruida para presentarla este año en Art Basel.
En su primera versión, los tron-
cos fueron retirados gradualmente y quemados en chimeneas, haciendo desaparecer gradualmente la bandera.
El artista quería expresar una alegoría del frágil estado del proyecto democrático estadunidense. Cada año, la Feria de Arte de Basilea acoge una sección (Unlimited) de piezas monumentales destinadas a museos y grandes colecciones, la cual también incluyó obras más antiguas, como un performance creado en 1991 por Félix González-Torres, un artista estadunidense de origen cubano que murió de sida en 1996.
La obra no tiene título, pero se conoce como Go-Go Dancing platform
El performance consiste en que dos veces al día un hombre vestido con pantalones cortos plateados baila durante unos minutos en un podio.
“Es interesante volver a verla”, comentó a Afp Giovanni Carmine, curador de Unlimited.
El artista había creado esta obra
poco después de la muerte de su compañero, “en un contexto que también era muy reaccionario”, donde algunos hablaban del sida “como un castigo divino”.
La sala de exposiciones de Art Basel contó este año con 67 obras, entre ellas tres ángeles del escultor alemán Thomas Schütte, que expresó “cierta ambivalencia”, apuntó Carmine.
Mientras, el artista japonés Izumi Kato aportó un toque de poesía con sus estructuras de piedra, pintadas con rostros enigmáticos, inspirándose en la tradición japonesa según la cual “cada piedra contiene un espíritu”, explicó. Y la estadunidense Arlene Shechet jugó con los contrastes mediante una pesada escultura abstracta de color naranja diseñada para dar una impresión de ligereza a pesar de su peso.
“La situación política actual es sombría, por lo que estoy aportando ligereza y color”, señaló Shecet.

▲ El museo de arte Fundació Joan Miró, en Barcelona, mantiene una jornada de puertas abiertas en conmemoración al 50 aniversario de la institución. Estos eventos son en honor a uno de los artistas más famosos de España, Joan Miró, y a esta fundación que creó hace medio siglo. Miró, fallecido en 1983 a los 90 años, fue un gigante del
Estadísticas...
movimiento surrealista, conocido por sus pinturas abstractas y lúdicas con brillantes formas geométricas y líneas caligráficas que simulan garabatos. El recinto se encuentra en un edificio modernista construido en la cima de una colina en Barcelona y alberga una vasta colección de sus lienzos, esculturas y otras obras. Foto Afp
Aunque en 2024 hubo más eventos presenciales (182), el público disminuyó respecto al año anterior, al registrarse 37 mil 601 asistentes, 8 mil 20 menos que en 2023. De ese total, 20 mil 514 personas apreciaron los cinco títulos presentados en el máximo escenario
cultural del país: Giovanna d’Arco, cuatro funciones; El vencedor vencido, tres; Turandot, cinco; Beatrix Cenci, cuatro, y La Bohème, cinco. Deben sumarse las tres “óperas de bolsillo presentadas por el EOBA en distintos espacios: Si me llaman Mimi (ocho funciones), Bastián y Bastiana (tres) y El imitador (dos), que en conjunto reunieron a mil 928 espectadores. En los 48 eventos presenciales
realizados hasta mayo pasado, la CNO convocó a una audiencia de 17 mil 269 personas en Bellas Artes, de las cuales 6 mil 339 correspondieron a las seis funciones de Lady Macbeth de Mtsensk y 6 mil 167 a las otras seis de Rigoletto, para sumar 12 mil 516 espectadores. Romeo y Julieta, con el que la agrupación arrancó sus actividades del año, reunió a mil 81 asistentes; la gala del tenor Javier Camarena,
a mil 223, y la del también tenor Arturo Chacón, a mil cuatro. La producción El niño y la ópera ha sido vista hasta la fecha por 405 espectadores en las cuatro funciones que hasta la fecha ha realizado la EOBA en distintas sedes, como el Centro Nacional de las Artes y el Pabellón Escénico del Bosque de Chapultepec. El sábado y el domingo se harán cuatro funciones más en el primero de esos espacios. / 3A P
Su intención es visibilizar las lenguas indígenas
JORGE A. PÉREZ ALFONSO
CORRESPONSAL
OAXACA,
OAX.
El Instituto de Artes Gráficas de Oaxaca (IAGO) fue sede del lanzamiento de la edición 2025 de los Premios CaSa, que este año incluye a las lenguas zapoteca, mixteca, mixe, chinanteca, triqu, chatina, mazateco y ombeayiüts, cuya convocatoria cierra el 29 de agosto. Sara López Ellitsgaard, presidenta de la Asociación Civil Amigos del IAGO y del Centro Fotográfico Manuel Álvarez Bravo (CFMAB), destacó la importancia de este concurso, creado por el artista plástico Francisco Toledo, quien tenía por objetivo el rescate y preservación de las lenguas indígenas.
Los premios, que surgieron en 2010 bajo la tutela del pintor juchiteco, han ido creciendo y sumado apoyos. Daniel Brena, director del Centro de las Artes de San Agustín (CaSa), destacó que este año habrá cinco categorías: narrativa, poesía, canción, literatura infantil y textos basados en la tradición oral.
Destacó que en los tres lustros que llevan estos premios, han recibido más de 2 mil 200 trabajos, de los cuales han sido galardonadas 199 personas, esto ha significado casi 6 millones de pesos en premios; sin embargo, puntualizó que lo más importante no es el dinero, sino las personas y sacar de la invisibilidad las lenguas indígenas.
Brena destacó las palabras de José Pergentino, ganador de este premio en 2011 en lengua zapoteca: “El logro más tangible de los premios CaSa es que permiten crear una comunidad de lectores en una lengua indígena, ya que va asentando las bases de una tradición literaria”.
Asimismo, Sara López afirmó:
“los apoyos económicos que se dan son una oportunidad para mostrar a las nuevas generaciones que hablan su lengua originaria que a través de ella pueden expresar y compartir las historias de sus pueblos”. Destacó que la idea de rescatar y preservar las lenguas indígenas del maestro Toledo no sólo giraba en torno a estos premios, sino a la promoción mediante otras actividades de las que son parte el CaSa, el IAGO y el CFMAB.
Añadió que en los últimos meses se han entregado más de 9 mil materiales didácticos y publicaciones en lenguas originarias a gestores, docentes y padres de familia, entre otras personas que solicitaron estos apoyos a través de una convocatoria.
Además, puntualizó que “fortalecer las lenguas no es sólo cuestión de reconocerlas, sino también de brindar herramientas concretas que ayuden a su enseñanza y para apoyar a quienes día a día las mantienen vivas: madres, padres, docentes y la comunidad”, pero también es de suma importancia mantener las bibliotecas comunitarias vivas.
La convocatoria estará abierta hasta el 29 de agosto y los resultados se darán a conocer el 24 de octubre en las redes sociales y la página web oficial del CaSa, así como de las instituciones convocantes.

▲ La Sala Nezahualcóyotl recibirá de invitado al prestigioso director de orquesta estadunidense Benjamin Zander y a la Filarmónica Juvenil de Boston, compuesta por 120 jóvenes músicos,
VILMA FUENTES
Ya durante la llamada guerra del Golfo, que viví durante un viaje a México, sufrí el bombardeo lanzado por las cadenas de televisión, Televisa a la cabeza. Las bombas que caían sobre el público eran las de la propaganda de la guerra, así como del moderno armamento utilizado. Bombas, pues, con capacidad mortífera mental. El nombre de Patriots, arma defensiva construida por la firma estadunidense Raytheon, parecía saborease por los presentadores de noticieros y demás emisiones informativas. Las armas, principalmente la Patriot MIM-104, eran descritas con el entusiasmo que ponen los buenos vendedores y otros merolicos para engatusar al posible cliente. Cabía preguntarse, dado el altísimo costo de esos instrumentos bélicos, a quién podía dirigirse esta propaganda de productos inaccesibles al común consumidor, obligado a comparar el precio de dos jabones u otros dos
productos cualesquiera para calcular si le alcanza el dinero. Pude deducir, por eliminación, que la publicidad sobre el poderío mortífero del armamento era una manera indirecta de proclamar la superioridad de los países poseedores de estas herramientas. En efecto, un primer paso de la guerra consiste en atemorizar al enemigo convenciéndolo de la supremacía de su rival y disponiéndolo así a una derrota anunciada, vencido mentalmente de antemano. Aunque los hechos nunca se repiten en forma idéntica, hay similitudes entre un periodo y otro. A semejanza de la guerra del Golfo, el más reciente enfrentamiento en Medio Oriente es narrado en los medios franceses con una pasión semejante a la que los cronistas de los medios audiovisuales ponen en los partidos de futbol y otras competencias deportivas. Pero, ahora, Patriot no es la vedette de las armas. La propaganda del MIM-104 ha sido sustituida por la de las bombas GBU-57, lanzadas por los bombarderos furtivos B-2. De la publicidad y utilización de un arma defensiva se ha pasado a la propaganda y uso de un ar-
quienes junto con la Orquesta Juvenil Universitaria Eduardo Mata interpretarán hoy la Sinfonía Núm. 6 en A menor, de Gustav Mahler. Los boletos cuestan 50 pesos. Foto Música UNAM
ma de ataque: una ojiva de 13 toneladas capaz de alcanzar decenas de metros de profundidad antes de explotar. Los Northromp B-2, fabricados durante la guerra fría, disponen de una tecnología furtiva que les permite sustraerse a los radares enemigos. Con un autonomía de 9 mil 600 kilómetros, pueden alcanzar el territorio iraní desde las bases estadunidenses de la isla de Guam en el Pacífico (7 mil 500 kilómetros) y la de Diego García en el océano Indico (5 mil kilómetros).
La propaganda subraya el poderío destructivo de las bombas y el costo del B-2, como si el precio estratosférico de 2 mil millones de dólares fuera un motivo de elogio. Así, en la absurda lógica de nuestros tiempo, el dinero es causa de alabanza y una concluyente forma de ensalzar y clasificar seres humanos y cosas: el hombre más rico y el arma más cara, a la cabeza de la clasificación.
Por desgracia, la propaganda de las armas no bastó para calmar los impulsos bélicos de Israel e Irán, y obligó a Donald Trump a utilizar los GBU-57 y
los B-2 para terminar de una vez con las ambiciones nucleares iraníes, calmar los temores de Israel e imponer la paz entre los dos países. Al parecer, Trump logró matar dos pájaros de un tiro con este bombardeo: probar la eficacia de los B-2 y los GBU57 e impedir la continuación de la guerra. ¿Triunfo comercial y victoria política? ¿Se venderán bien estas armas a países ricos como Arabia Saudita, siempre buen cliente? ¿Israel e Irán calmarán sus ánimos guerreros y sus deseos de venganza? ¿Trump será aplaudido por su electorado y recibirá el Nobel de la Paz? ¿Acabará con las dudas sobre la real aniquilación de los sitios nucleares iraníes? De todo eso, lo más previsible es el éxito comercial y la venta de armas al último grito de la moda. Y Trump, tan satisfecho de sí mismo, compara la guerra entre Israel e Irán con una pelea de niños en el patio de recreo. Una manera como otra de negar la muerte que no deja de evocarme Las batallas en el desierto, la tan magnífica novela de José Emilio Pacheco, siempre vivo. vilmafuentes22@gmail.com
El Aspergillus flavus provocó las muertes prematuras de quienes participaron en la excavación en la tumba de Tutankamón hace un siglo
EUROPA PRESS MADRID
Un equipo de investigadores liderados por la Universidad de Pensilvania ha logrado convertir el Aspergillus flavus, un hongo conocido por su toxicidad y vinculado a muertes en excavaciones de tumbas antiguas, en un “prometedor” compuesto anticancerígeno que abre “nuevas fronteras” en el campo de los medicamentos antifúngicos.
“Los hongos nos dieron la penicilina (...) Estos resultados demuestran que aún quedan muchos más medicamentos derivados de productos naturales por descubrir”, afirmó la autora principal del estudio y profesora asociada del programa universitario Penn Compact, Sherry Gao.
El Aspergillus flavus provocó una serie de muertes prematuras entre los equipos de excavación que entraron en la tumba del faraón Tutankamón en la década de 1920, y entre aquellos que hicieron lo propio en el sepulcro del rey Casimiro IV en Polonia durante los años 70. Ahora se ha convertido en la “fuente improbable de una nueva y prometedora” terapia contra el cáncer, según los investigadores.
El estudio, publicado en la revista Nature Chemical Biology, muestra un tratamiento que consiste en una clase de péptidos sintetizados ribosómicamente y modificados postraduccionalmente (RiPP, por sus siglas en inglés), lo que potencia las propiedades
para combatir el cáncer del hongo. El análisis genético indicó que una proteína específica de Aspergillus flavus es una fuente de RiPP fúngicos; al desactivar los genes que la producen, los marcadores químicos que marcaban la presencia de RiPP también habían desaparecido. Una vez que lograron purificar cuatro RiPP diferentes, los científicos descubrieron que las moléculas compartían una estructura única de anillos entrelazados que bautizaron como asperigimicinas, de las cuales, dos tuvieron “efectos potentes” contra las células de leucemia; otra de las variantes funcionó como la citarabina o la daunorrubicina después de añadirle un lípido.
Esta potenciación por parte de los lípidos tiene que ver con el gen SLC46A3, que ayuda a que los materiales salgan de los lisosomas, unas bolsas que recogen elementos extraños que entran en las células. “Este gen actúa como una puerta de entrada. No sólo facilita el paso de las asperigimicinas a las células, sino que también permite que otros péptidos cíclicos hagan lo mismo”, afirmó la primera autora del artículo, Qiuyue Nie.
La científica también destacó que saber que los lípidos afectan la forma en que este gen transporta sustancias químicas a las células proporciona “otra herramienta” para el desarrollo de fármacos.
Asimismo, los investigadores descubrieron que las asperigimicinas “probablemente” alteran el proceso de división celular, aunque no tienen casi ningún efecto sobre
el cáncer de mama, de hígado o de pulmón, lo que sugiere que sus efectos son específicos para ciertos tipos de células, lo que es “fundamental” para el desarrollo de futuros fármacos.
Además, han logrado identificar grupos de genes similares en otros hongos, lo que indica la existencia de más RiPP fúngicos por descubrir.
Por último, apuntaron que el siguiente paso es probar las asperigimicinas en modelos animales.
En el estudio colaboran científicos de las universidades estadunidenses de Rice, Pittsburgh, Texas, Washington en San Luis, la Escuela de Medicina de Baylor y, de Portugal, la Universidad de Oporto. El proyecto ha sido financiado por los institutos nacionales de salud estadunidenses, la Universidad de Pensilvania, la Fundación Welch, el Programa de Biofísica Molecular del Área de Houston, el Instituto de Prevención e Investigación del Cáncer de Texas y la Fundación Nacional de Ciencias.

▲ Muestra del Aspergillus flavus cultivado en el Laboratorio Gao. Sobre estas líneas, las investigadoras Qiuyue Nie y Maria Zotova al purificar el hongo. Fotos Bella Ciervo / Universidad de Pensilvania
Es un paso hacia una producción menos contaminante del fármaco y el reciclado de residuos PET: investigadores
Un grupo de químicos logró sintetizar paracetamol a partir de desechos plásticos gracias a una reacción que involucró bacterias Escherichia coli (E. coli), según un estudio difundido el lunes, aunque su aplicación a gran escala sigue siendo muy incierta.
Este experimento “demuestra que es posible producir este medi-
camento esencial a partir de residuos plásticos, mediante un proceso que no podría funcionar únicamente con una síntesis química o biológica”, resume el estudio publicado en la revista Nature Chemistry por investigadores de la universidad de Edimburgo, en Escocia. El paracetamol, usado contra el dolor y la fiebre, es uno de los medicamentos más comunes. Se produce a partir de derivados del petróleo, la mayoría de las veces por subcontratistas en Asia, mediante técnicas
de bajo costo muy contaminantes. Los autores del estudio financiado, entre otros, por el laboratorio farmacéutico AstraZeneca, procedieron en varias etapas. Primero utilizaron componentes de una botella usada de plástico PET (polietileno tereftalato) para inducir una reacción química en una cepa de bacterias E. coli. Al final de esta primera etapa las bacterias sintetizaron una molécula llamada PABA. Luego, modificando genéticamente las bacterias, los in-
vestigadores lograron transformar esa molécula en paracetamol. Los autores sostienen que este experimento abre la puerta a nuevas técnicas para reciclar residuos plásticos. Sin embargo, su aplicación a gran escala no es sencilla.
Todavía hay “varias consideraciones prácticas” por resolver para ir más allá de una simple “demostración de viabilidad”, indicaron científicos que no participaron en la investigación, de acuerdo con un texto crítico en el mismo número de Nature Chemistry. Señalan que la reacción inicial sólo produce una cantidad limitada de moléculas PABA, lo cual “podría
no ser suficiente para aplicaciones industriales”. No obstante, reconocen que el experimento es “prometedor”, subrayando el interés en estudiar procesos que mezclen biología con reacciones químicas artificiales. El estudio suscita escepticismo entre grupos ambientalistas. “Desde hace años, no pasa un trimestre sin que aparezca una nueva ‘bacteria que come plástico’”, expresó Melissa Valliant, de la organización Beyond Plastic. “Estos descubrimientos nunca alcanzan una escala suficiente como para hacer frente al enorme problema que representa la contaminación por plásticos”.

El grupo de rap se presentará el sábado // Rod Stewart, NeilYoung, Alanis Morissette, Olivia Rodrigo y Charli XCX encabezan el cartel
Asimismo, Alanis Morissette, The Prodigy, Snow Patrol, Burning Spear y Raye forman parte de los grandes nombres de esta edición.
El legendario festival de música de Glastonbury, en Inglaterra, abrió sus puertas ayer en una edición que reúne, entre otros, a Rod Stewart, Olivia Rodrigo y Charli XCX, y la controvertida presencia de los raperos norirlandeses de Kneecap.
Una multitud entusiasta, equipada con mochilas y carpas, invadió Worthy Farm, la granja en Somerset donde se celebra el evento hasta la noche del domingo.
La cita comenzó con un espectáculo seguido de fuegos artificiales. Las cabezas de cartel subirán al escenario a partir de mañana; se trata de ídolos del pop de las jóvenes generaciones, incluidos Olivia Rodrigo y Charli XCX, pero también los veteranos Neil Young y Rod Stewart, quien anunció que estará acompañado en el escenario por Ronnie Wood, de los Rolling Stones.
La atención mediática se centra en Kneecap, un trío de raperos originarios de Belfast que actuará el sábado. Uno de los miembros del grupo enfrenta cargos judiciales por haber exhibido durante un concierto una bandera de Hezbollah, movimiento islamista clasificado como organización terrorista en el Reino Unido.
Su presencia generó críticas dentro de la clase política y el primer ministro laborista, Keir Starmer, consideró “inapropiado” que el grupo esté en el festival.
La líder de la oposición conservadora, Kemi Badenoch, hizo un llamado a la BBC, socia del festival desde 1997, a no transmitir el concierto de los raperos.
Las entradas para el festival se agotaron en 35 minutos tras salir a la venta en noviembre, con un precio promedio de 507.8 dólares. Glastonbury, que atrajo a más

de 210 mil personas en 2024, nació de la contracultura británica en los años 60 y de los movimientos jipi, con su primera edición en 1970, bajo el nombre de Pilton Festival. El grupo de glam rock T Rex fue la primera cabeza de cartel. Desde entonces han participado figuras de la talla de David Bowie, Paul McCartney, Stormzy y Elton John, quien ofreció allí su último concierto en Reino Unido en 2023. Fiel al clima británico, el equipamiento de los asistentes incluye

Falleció Lea Massari, la más francesa de las actrices italianas
▲ Aspectos de la ceremonia de apertura del encuentro musical de Glastonbury, en Worthy Farm, Inglaterra, al cual asistieron decenas de miles de jóvenes en el primer día. Fotos Afp
sombreros, gafas de sol y botas de goma, ya que el terreno puede convertirse en un lodazal en caso de lluvia. El festival no se celebrará el próximo año, para permitir que el terreno descanse.
La actriz italiana Lea Massari, conocida por sus papeles en las películas La aventura, de Michelangelo Antonioni, y Murmullos del corazón, de Louis Malle, falleció a los 91 años.
La secretaria de Cultura de Italia, Lucia Borgonzoni, rindió homenaje a “una actriz de magnetismo irresistible y un talento fulgurante”.
Según el diario romano Il Messaggero, la actriz, cuyas últimas apariciones en el cine datan del siglo pasado, murió el lunes en Roma y fue enterrada al día siguiente en Sutri. Lea Massari formó parte de numerosas películas de las décadas de 1960 y 1970; trabajó tanto en su país natal, Italia, como en Francia bajo la dirección de cineastas de primer nivel, incluidos Sergio Leone, Claude Sautet, Francesco Rosi y el español Carlos Saura. Compartió escena con los actores Yves Montand, Jean Paul Belmondo, Gian Maria Volonté, Mel Ferrer y Anthony Perkins. Su verdadero nombre era Anna María Massatani y nació el 30 de junio de 1933 en Roma. Alcanzó el éxito en 1960 con La aventura (junto a Monica Vitti), película que narra la búsqueda de una joven desaparecida antes de su boda y que impuso una visión innovadora del arte cinematográfico. Un año más tarde actuó en El coloso de Rodas, de Sergio Leone y en Una vida difícil, de Dino Risi. En Francia participó en 1964 en El desertor, de Alain Cavalier, al lado de Alain Delon, con quien volvió a trabajar en la película italiana de Valerio Zurlini El profesor, en 1972. Considerada “la actriz más francesa de las estrellas italianas”, cobró gran notoriedad en 1971 con Murmullos del corazón en su papel de una madre que mantiene una relación incestuosa con su hijo.
Hay que saltar, hay que saltar, una producción universitaria disponible de forma gratuita en la web
HERNÁN MULEIRO ESPECIAL PARA LA JORNADA
Jipis, metaleros y punks fueron espiados por la policía durante décadas en Argentina. Así lo documenta Hay que saltar, hay que saltar, miniserie universitaria que prueba el espionaje al rock con filmaciones y archivos desclasificados.
El documental, de cuatro episodios y disponible de forma gratuita en youtube.com/UNQtv, difunde información de al menos tres décadas de archivos de espionaje policial al rock hecho en Argentina. Su título hace referencia a un canto que se empezó a escuchar en partidos de futbol y conciertos al final de la última dictadura: “Hay que saltar / hay que saltar / El que no salta / es militar”.
Los archivos que incluye el documental forman parte de la comisión nacional por la memoria y dan constancia empírica del espionaje al rock argentino. Un texto de la comisión, titulado De lo privado a lo público, da cuenta del interés policial en las subculturas asociadas con la música: “Jipies, melenudos, rockeros, punks, skin heads, metaleros violentos, ¿seguidores, tribus, fans, bandas o barras? ¿Cómo visten? ¿Qué drogas consumen? ¿Qué música escuchan? ¿Por qué la escuchan? ¿Cuál es el mensaje oculto de sus letras? ¿Cuál es su relación
con la política? ¿Qué peligros encierran las multitudes? Definiciones y preguntas que durante más de 30 años los agentes de la desaparecida Dirección de Inteligencia de la Policía en la Provincia de Buenos Aires (DIPBA) intentaron responder. Para eso sacaron fotos, ficharon, espiaron, hicieron informes de inteligencia, filmaron y fundamentalmente vigilaron a la multitud”.
Vigilancia a la cultura
La cantidad de material que nutre el documental permite trazar una línea histórica del espionaje a la actividad musical en Argentina.
En los años 70, una redada al concierto del grupo Almendra en el estadio Obras terminó con una buena porción del público detenida para “averiguación de antecedentes”. En los 80, los integrantes de la banda punk Los Violadores (de la ley) fueron investigados por posesión de un polvo blanco que resultó ser una sustancia altamente tóxica que se usaba para generar humo arriba del escenario. Y en los 90 también espiaron la relación entre determinados grupos y organizaciones sociales y de derechos humanos; tal fue el caso de las pioneras del rap Actitud María Marta. Durante la dictadura, el espionaje bonaerense buscó una conexión entre el rock y la militancia política, a pesar de que no siempre estaban
conectados. En los 80 se hablaba de primavera democrática, pero la institución policial distaba mucho de una renovación. Y en los 90, los espías miraron azorados cómo el rock con reivindicaciones sociales se masificaba; pusieron el foco en los hijos de desaparecidos que recuperaron su identidad y formaron grupos musicales.
Los archivos se hicieron públicos en 1999 y hoy son parte de una institución pública que las analizó y divulgó. Miles de páginas detallan las investigaciones de los servicios de inteligencia en argentina enfocadas en los músicos. La información está detallada en una carpeta rotulada “Grupos musicales sospechosos”. Asociaciones como Correpi (Coordinadora contra la represión policial) denunciaron el autoritarismo y abuso de su época, impunidad aún mayor en barrios marginados.
Según los archivos, los espías buscaron información sobre las actividades de Correpi y otras organizaciones simulando ser periodistas. En otros informes, los motivos del espionaje ilegal sobre movimientos musicales parecen más difusos. El periodista Juan Ignacio Provéndola cuenta en el documental que los escritos parecen buscar la peligrosidad de las tribus urbanas para justificar el trabajo que realizaban. En los textos destaca el frío lenguaje de los informes “oficiales” sobre los movimientos musicales,

mezclado con observaciones banales que mostraban una incomprensión casi total. En algunos casos, los espías lograban infiltrarse correctamente en conciertos y pasar desapercibidos hasta que lo consideraban necesario. En otros, su presencia resultaba notablemente visible y con intenciones intimidatorias, como una cámara de video apostada no muy lejos de una manifestación. Músicos como Pato Strunz, baterista entonces del grupo metalero Malón, comprobaron que su banda estaba en los archivos de inteligencia a partir de la difusión de Hay que saltar El asesinato el 26 de abril de 1991 de Walter Bulacio, un joven sin boleto capturado por la policía al intentar ingresar a un concierto del grupo Patricio Rey y sus Redonditos de Ricota, terminó de dar forma masiva y juvenil al reclamo contra la violencia de la DIPBA.
Una de las videograbaciones de los espías en Hay que saltar exhibe el tipo de consignas de los inconformes: “No al ajuste, no a la represión y no al gatillo fácil”, expresión asignada al homicidio en manos de un policía. Se trata de la filmación de un recital de la Correpi en 1996, en Florencio Varela, provincia de Buenos Aires, en la que 8 mil personas cantaron contra el gobernador, mientras se escucha que los espías intentan ubicar a las madres y fami-
▲ Integrantes de Todos Tus Muertos en su primera época, una de las bandas espiadas por la policía en Argentina. Foto tomada de su Facebook
liares de jóvenes asesinados presentes en el concierto.
Sospechosos en dictadura y en democracia
En Hay que saltar confluyen elementos detestados por el presidente Milei: es un logro de una industria audiovisual castigada, realizada por una institución pública de educación superior, la Universidad de Quilmes, que cuenta con el testimonio de docentes con formación rockera y con la participación clave de un organismo del Estado que preservó tal cantidad de material escrito y filmado, que permite reconstruir el interés en espiar la cultura tanto en la dictadura como en la democracia.
El entrevistador y narrador es Ruso Verea, conductor de uno de los programas de radio pioneros del metal en Argentina, la Heavy Rock & Pop.
Las historias de infiltración policial en conciertos suelen ser mitos hasta que dejan de serlo; el documental Hay que saltar desmitifica con la fría certeza que otorga el material desclasificado.
Delito no prescribe; Luis de Llano debe indemnizar a Sasha Sokol,
IVÁN EVAIR SALDAÑA
La primera sala de la Suprema Corte de Justicia de la Nación (SCJN) confirmó ayer la condena civil impuesta al productor Luis de Llano Macedo, quien deberá indemnizar y reparar el daño causado a la artista Sasha Sokol por el abuso sexual que cometió en su contra hace más de 30 años, cuando ella tenía 14 años y él 39.
Con esta resolución, votada por unanimidad, el máximo tribunal estableció la jurisprudencia que determina que, en casos de abuso sexual infantil, no aplica la prescripción para presentar una demanda por la vía civil cuando no es posible hacerlo por la vía penal.
“Cualquier medida prescriptiva lesionaría el derecho de acceso a la justicia de las víctimas, lo que ade-
más se traduciría en la imposibilidad de obtener una compensación por el daño sufrido”, argumentó la Corte en el proyecto del ministro Jorge Mario Pardo Rebolledo. En su cuenta de la red social X, la cantante comentó: “Esta sentencia trasciende por mucho mi caso personal y abre la vía del juicio civil para otras víctimas, ya que la primera sala de la SCJN ha declarado la imprescriptibilidad de la acción civil en casos de abuso sexual de menores. Desde ahora, cuando esté lista, cada víctima podrá acceder a la justicia y a la verdad.
La artista agregó: “A los 14 años no tuve herramientas para comprender lo que me estaba pasando, mucho menos para defenderme. El abuso de Luis también sucedió al manipular la verdad con declaraciones falsas como que mis papás estaban de acuerdo, o incluso min-
“Esta sentencia trasciende por mucho mi caso personal y abre la vía del juicio civil para otras víctimas”, destacó la cantante. Foto Roberto García Ortiz
tiendo ante el juzgado al declarar que la relación no había existido más que ‘en la mente de una niña fantasiosa’.
“Por eso la justicia lo ha condenado por el abuso continuo; desde la relación sexual hasta el daño moral que violentó mi dignidad, integridad física, intimidad y honor. Llevar las cosas hasta aquí me ha devuelto la capacidad de acción. Hoy tengo en mis manos las riendas de mi vida y puedo cuidarme. Estabilizar la verdad es el principio de la reparación.”
La Corte confirmó la sentencia de la séptima sala civil del Tribunal Superior de Justicia (TSJ) de la Ciudad

de México en septiembre de 2023, que ordena a De Llano Macedo pagar una indemnización a la actriz, tomar un curso de sensibilización, ofrecer una disculpa pública a la víctima y no volver a hablar de ella. Lo anterior, debido a que la Corte consideró que los agravios planteados en el recurso “son infundados”.
El productor musical y de televisión alegó errores procesales, como la omisión de incluir a otra persona en el juicio, la mala valoración de pruebas y testimonios, y un análisis incorrecto sobre la prescripción. También cuestionó que el TSJ utilizara la perspectiva de género para justificar sus decisiones.

La muestra revela el talento como dibujante
y fotógrafo del creador
JUAN JOSÉ OLIVARES
Johnny Depp, actor reconocido en el mundo y uno de los histriones fetiches de Tim Burton, reveló que cuando se preparaba para encarnar a El joven manos de tijera, uno de los clásicos del cineasta estadunidense, le bastaron para representarlo las ideas que tenía en su cabeza, pero más aún, ver uno de los dibujos sobre el personaje que el también artista plástico había hecho.
Se sabe que Tim Burton, realizador de películas con seres fantásticos de otro universo, egresó a finales de los años 70 del Instituto de Artes de California –creado por Walt Disney como plataforma de aprendizaje para jóvenes talentosos en el dibujo y la animación–. Su trabajo final fue un cortometraje sobre un monstruo de apio, mismo que le abrió la puerta a un empleo en los estudios del señor Disney.
A partir de ahí, a través de sus filmes y miles de dibujos, se le ha conocido en el orbe como el taumaturgo de la fantasía, el cual ha creado personajes de cómic, antes unidimensionales, en entidades complejas, profundas, sombrías, rechazadas y atormentadas por la humanidad, pero con sentimientos, con su propio espacio y modo de enseñanza.
Ese mundo de historias y personajes irreales en los que los hu-
manos nos reflejamos se exhibe en la Ciudad de México a partir de hoy, cuando se abre al público Tim Burton: Laberinto, exposición que presenta una curaduría de su producción como ilustrador, dibujante, fotógrafo, cineasta y creador de personajes ya entrañables.
Laberinto es un portal hacia la mente de su creador, repleta de cientos de piezas originales, semillas de sus largometrajes que “susurran” los secretos detrás de su obra. Cada puerta del espacio llevará a varios de los capítulos de 40 años de creatividad.
Se puede andar por las sombras de un bosque en el que esperan los personajes de la película El cadáver de la novia. También por los de El joven manos de tijera. Además de sumergirse en la extravagancia de Charlie y la fábrica de chocolate y, por supuesto, por donde no se puede pronunciar tres veces la palabra
Beetlejuice
En la muestra se aprecian los medios formatos y las escalas de los bocetos, hechos con lápiz, pluma, óleo, pasteles, los cuales, con el don de Burton, determinaron la creación final de los personajes de sus películas. Hay gran cantidad de dibujos, pinturas y fotografías. Si bien el trabajo de Tim Burton es ampliamente conocido en las pantallas de cine, la exposición revela su talento como dibujante y fotógrafo, en un recorrido por 15
▲ Figura de El joven manos de tijera, película protagonizada por Johnny Depp, incluida en la exhibición. Foto Jorge Ángel Pablo García
minisalas o experiencias en las que está dividido el dédalo expositor; cuenta con partes interactivas que dan vida a sus esbozos.
Burton está en la lista de quienes entienden la belleza bizarra y el arte no convencional, y cómo se conectan entre sí para transformarse y entregarse a la gente. Por eso tiene tantos seguidores, además de que su ecléctico estilo es distintivo, al grado de transportar a lugares de cuentos mágicos y de pesadillas infantiles.
De hecho, su propósito es que cada visitante extraiga al niño interno para sacarlo a divertirse con el miedo, y con monstruos y animales de inventiva que suelen despertar más simpatía que los humanos. Con sus creaciones, Burton hace que no haya mejor forma de calmar el temor natural del ser humano hacia la muerte que aceptar su existencia de forma lúdica.
Tim Burton: Laberinto incluye cientos de piezas originales, maquetas, muñecos y parte de sus filmes, que expresan el sentir de la mente emocional del director.
La exposición, con un costo de 450 pesos en boleto general y de 800 el premium, estará abierta hasta el próximo 5 de octubre. La visita dura alrededor de 60 minutos. Su sede es el Casino del Bosque del Lienzo Charro, en avenida Constituyentes 500, en la alcaldía Miguel Hidalgo.





Con la soga en el cuello y una mínima posibilidad, el Monterrey encontró la salvación en el cierre de la fase de grupos del sector E para clasificar a octavos de final del Mundial de Clubes y ser el único plantel mexicano sobreviviente en el torneo. Con una goleada 4-0 sobre al japonés Urawa Reds, los Rayados le arrebataron el pase al River Plate, que en paralelo fue derrotado 2-0 por el Inter de Milán.
Con doblete de Nelson Deossa y tantos de Germán Berterame y Jesús Tecatito Corona, Rayados se impuso para terminar en el segundo puesto del grupo con cinco puntos, dos menos que el Inter y apenas uno más que el River, al tiempo que el Urawa se quedó en cero. El pase le permite al club mexicano pelear por la honra en el Mundialito luego de que Pachuca fue eliminado en el Grupo H. Ahora, los regiomontanos enfrentarán en octavos de final al Borussia Dortmund, líder del sector F, mientras el Inter, subcampeón de la Champions de Europa, tendrá de rival al Fluminense de Brasil.
La etiqueta de uno de los equipos más costosos de la Liga Mx –valuado en 83.5 millones de dólares–y con estrellas internacionales como Sergio Ramos, campeón mundial con España en 2010, así como Sergio Canales, los Rayados tenían que evitar una bochornosa eliminación temprana en el certamen. Todo y nada estaba en sus manos. Después de dos empates, los regiomontanos tenían dos puntos frente a cuatro que presumían el Inter de Milán –que caminaba como líder– y el River Plate. La única vía para seguir con vida era derrotar al Urawa
ERENDIRA PALMA HERNÁNDEZ
Ante la encomienda de convertir al futbol en el deporte número uno en Estados Unidos y con la Copa del Mundo 2026 en puerta en ese país, Gianni Infantino, presidente de la FIFA, enfrenta el cierre de la fase de grupos del Mundial de Clubes con cifras de asistencia que generan controversia, pues mientras algunos juegos han atraído a un amplio número de aficionados, otros se muestran con las gradas casi vacías. Aun cuando la FIFA aseguró que en la primera semana el certamen recibió a 556 mil personas, con un promedio de 34 mil 700 por partido, hasta ahora el juego con mayor número de seguidores fue el PSG-







y esperar una victoria o empate con menos de dos goles entre argentinos e italianos.
No había empezado el encuentro y la presión ya se vivía a tope. En un Rose Bowl Stadium, en Pasadena, que mostraba una baja asistencia (14 mil personas), el equipo de Domenec Torrent desplegó un juego ofensivo de precisión y entera concentración con el cual aseguró la victoria antes del descanso.
Con un potente disparo de pierna zurda desde fuera del área, Deossa le dio a Monterrey el primer tanto a los 30 minutos para marcar el rumbo del juego: atacar sin miramientos. Apenas cuatro minutos después, Berterame aumentó la cuenta con facilidad tras recibir un pase dentro
del área y sentenciar a quemarropa. Tecatito Corona, quien había sido clave en los ataques de los regiomontanos, también celebró al 38 tras marcar un golazo con un disparó casi desde la media cancha.
Con el arranque del complemento, Monterrey sabía que ya había cumplido, ahora sólo debía esperar a lo que sucediera al mismo tiempo en el Lumen Field Stadium, en Seattle.
Fue entonces cuando la garra de los italianos y un yerro vital de los argentinos fueron claves para que Monterrey clasificara. El River Plate vio poco a poco cómo sus esfuerzos se perdieron cuando Lucas Martínez fue expulsado al 65 por una fuerte entrada.
Ya con la ventaja numérica, el Inter de Milán sólo tardó siete minutos para que Franscesco Esposito pusiera el primer tanto y después Alessandro Bastoni (90+3) concretara la victoria de los italianos y la salvación de los Rayados. Ambos encuentros cerraron con controversia. En Pasadena, le fue anulado un tanto al Urawa, mientras Deossa puso la cuarta diana (90+7), al tiempo que en Seattle fue expulsado Gonzalo Montiel, lateral del River. Ya no importaba, los pases estaban sellados.
Más temprano, el Fluminense reiteró el potencial del futbol brasileño al convertirse en el cuarto equipo carioca en clasificar a octavos de final tras empatar sin go-
▲ El equipo regiomontano celebra su clasificación, pues se convirtió en el único club tricolor que continúa en la competencia tras la eliminación del Pachuca. Los Rayados enfrentarán el martes al Borussia Dortmund. Foto Afp
les con el Mamelodi Sundowns en el Grupo F, mientras el Borussia Dortmund clasificó como el primero del sector al vencer 1-0 al Ulsan sudcoreano.
Así, Brasil es el único país que puede presumir a sus cuatro equipos dentro de la segunda fase del Mundial de Clubes, luego de que también sellaron su boleto Palmeiras, Flamengo y Botafogo.
Atlético de Madrid con 80 mil 600 aficionados en el Rose Bowl, recinto con aforo para 89 mil asistentes. Sin embargo, la cifra contrasta frente a los 3 mil 400 seguidores que vieron el Ulsan-Mamelodi en el Inter&Co, el cual puede recibir a 25 mil 500 personas; el partido del torneo con el registro más bajo hasta ahora. El ambiente en el Pachuca-Salzburgo también fue gélido con 5 mil aficionados en el TQL Stadium; una cifra mínima ante las 26 mil butacas del recinto. Incluso varios medios como ESPN, The Guardian, Los Angeles Times o The Athletic destacan la baja venta de boletos para el torneo. Apenas unos ocho encuentros de los 44 disputados hasta el miércoles –la penúltima jornada de la fase de grupos– podían presumir una asis-
tencia mayor a 75 por ciento de su capacidad, de acuerdo con un análisis realizado por La Jornada Entre los partidos con mejor asistencia está el juego inaugural entre el Inter Miami, con la estrella argentina Lionel Messi, y Al Ahly con 60 mil 900 seguidores en el Hard Rock Stadium, que tiene capacidad para 65 mil 300 personas, así como el Real Madrid-Al Hilal que fue visto por 62 mil aficionados en el mismo recinto.
Boca Juniors fue uno de los equipos que también atrajo a un gran número de seguidores al enfrentar al Bayern Múnich ante 63 mil personas también en el recinto de Miami. Sin embargo, las cifras son muy distantes al resto de los encuentros. El River Plate-Urawa apenas reunió a 11 mil fanáticos en el Lu-
men Field, que tiene una capacidad para 67 mil 500, mientras el Fluminense-Mamelodi recibió ayer a 14 mil aficionados en el Hard Rock Stadium. El duelo entre el Borussia Dortmund, subcampeón de la Champions de Europa en 2024, y el Ulsan enfrentó un peor escenario con sólo 8 mil personas, menos de la cuarta parte del TQL Stadium. Desde antes de comenzar el torneo se vislumbraba un panorama de incertidumbre respecto a la venta de boletos, sobre todo por el endurecimiento de las políticas migratorias del presidente Donald Trump, al realizar redadas en varias entidades como Los Ángeles, ciudad que tiene a un gran número de habitantes latinos y mexicanos. Incluso, los pases para el encuentro inaugural bajaron drásticamente
de precio hasta llegar a 61 dólares, cuando el valor inicial más económico era de 250.
Pese a un escenario que pareciera desalentador, Infantino ha respaldado al torneo que él mismo impulsó al cambiar el formato tradicional de seis a 32 equipos y en el cual se reparten mil millones dólares en premios.
“Quizás algunos lo critiquen un poco, pero es algo nuevo y especial. Es un auténtico Mundial con los mejores equipos y jugadores. El torneo y la Copa 2026 son para mostrar a los jóvenes estadunidenses que si eres bueno y tienes talento no necesitas ir a otro deporte, porque a través del futbol hay un camino hacia la gloria y también hacia el dinero”, dijo Infantino a la cadena Fox Sports.
2025




Copa Oro 2025







▲ Christian Gray (centro), profesor de secundaria y quien es felicitado por su compañeros, se convirtió en la figura del equipo neozelandés, luego de anotar el gol del empate ante el Boca Juniors, que a la postre significó la eliminación de los sudamericanos en el Mundialito. Foto Ap
JUAN MANUEL VÁZQUEZ
Sin modestia actuada, Christian Gray, jugador del Auckland City, se volvió un acontecimiento en el futbol global. Apenas terminó su actuación en el Mundial de Clubes de la FIFA con el conjunto neozelandés volverá, al igual que toda la plantilla, a su empleo común, en el mejor sentido, tras un mes de permiso sin goce de sueldo.
Auckland City es un equipo amateur cuyos jugadores son agentes inmobiliarios, representantes de ventas, comerciantes, estudiantes, un encargado en una fábrica de herramientas, un hojalatero, un peluquero de origen colombiano y un profesor, Gray, autor del gol que significó el empate (1-1) que eliminó al célebre Boca Juniors.
Una vez terminada su participación, que muchos señalaron con dedo flamígero escandalizados de que un equipo de aficionados se codeara con la élite del futbol mundial, consideraron que su paso era un desastre evidente: Bayern Múnich los goleó 10-0 y Benfica 6-0. Sólo faltaba la puntilla del internacional Boca Juniors, cuyos seguidores se
expresaban indignados de tener que medirse con un adversario que consideraban de tan poca cosa.
Pero el duelo fue inesperado para todos. Gray, el profesor de la secundaria Mount Roskill de Auckland, se levantó para recibir el servicio de Jerson Lagos, el peluquero de origen colombiano. Un empate que echó del torneo al Boca, el equipo más global de América Latina.
“Ahora los muchachos volverán a sus trabajos cotidianos, esa es nuestra realidad”, dijo el docente que salvó la dignidad de su equipo y del futbol como un hecho lúdico.
“Soy profesor, laboro en una escuela, también estudio y trabajo a tiempo completo, además soy entrenador de principiantes. Cuando regrese a casa tengo algunas tareas que me esperan; eso es a lo que volveré, al igual que todos los chicos del equipo”, agregó.
Lagos también es un emblema en este equipo. Nació en Bogotá, Colombia, y llegó a Nueva Zelanda acompañado de su madre y hermanos como refugiados.
“Nos ha encantado Nueva Zelanda, nos han tratado muy bien siempre; jugué en el club Melbourne (en Australia), ahí estuve varios años
antes de esta oportunidad”, declaró el jugador para la cadena ESPN.
“Desde enero soy barbero, ha sido complicado con los horarios, vivo lejos de donde entrenamos y termino tarde, debo apresurarme”, contó a la cadena deportiva.
Ahora sus vidas tendrán una recompensa con el premio que les otorgará la FIFA por anotar y participar: se repartirán 3.5 millones de dólares entre todos. Pero eso no les quitará su condición de futbolistas por puro gusto.
Lo que para muchos fue un episodio pintoresco, para otros resulta una rareza que recupera la espontaneidad de un deporte que se ha convertido en una industria con cálculos de ganancias por encima de todo. Una anomalía que devuelve al futbol su placer por el juego y la pasión, que lo hermana con ese espíritu que han regalado personajes como Garrincha. “Para Garrincha, el futbol era una fiesta, no un trabajo ni un negocio. Le gustaba jugar por el simple placer, no por ganar o por contratos”, escribió el inolvidable Eduaro Galeano, y eso nos recuerda el Auckland, elevado por el gol de un profesor de secundaria.
“Éxito de Tena, Herrera y Aguirre pone al técnico mexicano en lo más alto”
KARLA TORRIJOS
Mientras en la Liga Mx cada vez hay menos técnicos mexicanos, tres de las ocho selecciones que disputarán los cuartos de final de la Copa Oro 2025 son dirigidas por estrategas tricolores (Guatemala, Luis Fernando Tena; Costa Rica, Miguel Herrera, y México, Javier Aguirre), lo cual, “es algo muy positivo porque posiciona a los entrenadores nacionales en lo más alto; sin embargo, todavía es temprano para celebrar, pues se necesita que las nuevas generaciones se preparen aún más para también poder destacar a escala internacional”, consideró el timonel mexicano Jacques Passy.
El actual director técnico de la selección nacional de Antigua y Barbuda indicó que más allá de las escasas oportunidades que existen en el futbol mexicano, las recientes camadas de entrenadores tricolores “no han demostra-
do tener un buen nivel. No se han capacitado lo suficiente para estar a la altura de las circunstancias y son justamente ellos los que deben ponerse las pilas. “En la actualidad no basta con tener la licencia, es necesario prepararse también en otras áreas y, sobre todo, innovar para poder aportar.”
Asimismo, el otrora director técnico de la selección de San Cristóbal y Nieves, así como del representativo Sub-23 de República Dominicana, señaló que “tanto Tena, como Herrera y Aguirre, han trabajado mucho para poder estar ahí, ellos forman parte de una generación mejor lograda, ganaron varios títulos en la Liga Mx, pero de los jóvenes, ¿quién se ha coronado recientemente en el torneo local? ¿Quién fue el último técnico mexicano en hacerlo y cuándo fue? La verdad es que muy pocos han sobresalido”.
Puso de ejemplo a Efraín Juárez y Gonzalo Pineda, actuales entrena-
Luis Fernando Tena, actual timonel de Guatemala, tras su paso por el futbol mexicano ahora triunfa fuera del país. Foto @fedefut_oficial
dores de Pumas y Atlas, respectivamente, quienes después de brillar en el ámbito internacional fueron contratados por clubes mexicanos. “Ellos han destacado porque se forjaron en el balompié internacional. Desafortunadamente esa es la tendencia actual, ambos se ganaron el puesto después de triunfar fuera, en el caso de Juárez en la liga de Colombia, y en el de Pineda en la de Estados Unidos. Ahí te das cuenta de que el éxito de los estrategas jóvenes mexicanos está en salir, destacar en otras ligas y regresar, no hay otra.”
Destacó que el programa de capacitación de la Federación Mexicana de Futbol (FMF) “ha hecho entrenadores que quizá no estén

tan preparados para enfrentar retos a escala mundial. Los timoneles nacionales están en un círculo muy vicioso y hay que romperlo. En la Liga Mx apenas hay tres o cuatro, y el concepto que se tiene de ellos en general, incluso en el país, es que tienen un nivel muy bajo”. Finalmente, lamentó que ocurran situaciones como la del técnico ar-
gentino Fernando Gago, quien, después de abandonar de forma intempestiva a Chivas para dirigir al Boca Juniors, regresa al futbol mexicano como entrenador del Necaxa. “No sé por qué se permiten ese tipo de cosas en nuestro balompié, pero creo que hay códigos de ética que nunca se deberían romper”, aseveró.
ADRIANA DÍAZ REYES
Honrar a los pueblos fundadores de la Ciudad de México y las raíces prehispánicas de nuestro país es la meta del Medio Maratón y Maratón capitalinos.
Durante la presentación de las playeras y medallas de la edición 2025, la jefa de Gobierno, Clara Brugada, detalló que en esta ocasión los más de 30 mil participantes correrán en el contexto del aniversario 700 de la fundación de Tenochtitlan.
“Serán carreras muy significativas. El Quetzal en la medalla del Medio Maratón representa la libertad, resiliencia y belleza en movimiento; Cihuacóatl, en la del Maratón, nos habla de una mujer serpiente, madre y guerrera que se caracteriza por la valentía y protección a los que no se rinden. Las deidades reflejadas son una buena manera de homenajear nuestras tradiciones”, detalló Brugada en la fuente de Xochipilli.
Las competencias están certificadas y homologadas por la Federación Mexicana de Asociaciones de Atletismo (FMAA) y la Asociación de Maratones y Carreras de Distancia (AIMS).
“Cada maratón tiene su historia y este año es especial, porque se inscribe en la conmemoración de una de las ciudades más antiguas del continente y la grandeza de sus raíces”, agregó Brugada. Correr no es nuevo en la ciudad, explicó la mandataria, quien se refirió a los painanis, corredores ancestrales del imperio mexica, quienes recorrían largas distancias para mantener unidos los territorios.
“Hoy, quienes corren estas rutas, siguen ese mismo espíritu: vencen altitud, distancia y cansancio con la frente en alto y el corazón firme.”
A la presentación asistieron Javier Peralta, titular del Instituto del Deporte capitalino; Antonio Lozano, presidente de la FMAA; Natasha Uren, directora ejecutiva del Bosque de Chapultepec, y la ultramaratonista Lorena Ramírez.
La edición 18 del Medio Maratón

(54 por ciento hombres, 46 por ciento mujeres) se llevará a cabo el 13 de julio. El recorrido tendrá la salida en la Torre del Caballito y llegada en el Ángel de la Independencia.
El Maratón 42 (69 por ciento hombres, 31 por ciento mujeres) se celebrará el 31 de agosto. Se espera la participación de corredores de más de 30 países, entre los que destacan representantes de Gua-
temala, Estados Unidos y España. Brugada se refirió a la construcción de 100 Utopías en la ciudad (Unidades de Transformación y Organización para la Inclusión y la Armonía Social), que contarán con infraestructura deportiva como pistas de atletismo, canchas y albercas. “Lo que buscamos es que cada persona tenga una a 15 minutos de su casa. El deporte y la cultura
transforman la vida de la población y educan a la niñez”, subrayó Brugada, quien anunció 500 nuevas inscripciones para el Medio Maratón. Aquellos corredores que crucen la meta de ambas carreras recibirán el reconocimiento Painani y se otorgará, además, a todas y todos los participantes la distinción honorífica de embajadores del deporte y la paz.
La llegada de una mujer a la presidencia del Comité Olímpico Internacional (COI) abrió la puerta para que más de ellas puedan aspirar a puestos de decisión en el deporte. Marijose Alcalá, quien en 2021 se convirtió en la primera mandamás del Comité Olímpico Mexicano, celebró la elección de Kirsty Coventry, pues con esto “se dio un voto de confianza” al género femenino.
“Al llegar a un cargo tan distinguido e importante tendrá la oportunidad de demostrar que las mujeres tenemos capacidad, liderazgo y disciplina. Una ex atleta y medallista olímpica como ella puede hacer mucho por el olimpismo”, comentó Alcalá. Coventry, la titular más joven que ha tenido el COI y la primera africana, enfrentará muchos retos los
próximos años. Según Marijose, la oriunda de Zimbabue deberá reforzar la confianza y credibilidad que se tiene en el organismo.
“Ahora tiene una gran responsabilidad. En su discurso comentó que aprovechará el poder del deporte para maximizar la colaboración y el compromiso en la familia olímpica. También reforzará alianzas para crecer en lo económico y liderar un desarrollo sostenible.”
Según la ex clavadista, Coventry deberá reforzar el trabajo realizado por su antecesor, Thomas Bach.
“Ella nos va a representar bien no sólo a las mujeres, sino a todo el movimiento olímpico. Debe continuar con el liderato firme que dejó Bach y dar continuidad a temas de equidad de género, transversalidad y autonomía”.
A Paola Longoria, presidenta de la Comisión del Deporte de la Cámara de Diputados, le parece un
acierto que una ex deportista tome las riendas del COI. La raquetbolista compartió que nadie que no haya experimentado el alto rendimiento puede entender las necesidades de los atletas.
“Hay un nuevo liderazgo. Estoy segura de que ella entiende y sabe qué necesita un seleccionado y cuáles son las cosas que se deben mejorar. Me siento muy contenta de que una mujer esté al frente del COI, es un paso adelante en la lucha que enfrentamos para demostrar que también tenemos la habilidad de manejar organizaciones tan importantes”, comentó.
La raquetbolista espera que la elección de Coventry favorezca a la igualdad en temas como el pago de salario.
“Siempre lo he dicho, el hombre sigue sobresaliendo más en algunos deportes y el gasto salarial en lo que se refiere a los premios todavía no es
el mismo en ambas ramas. Seguimos luchando para tener esa igualdad, vamos rompiendo juntas estos techos de cristal, dando paso a las oportunidades para las mujeres en puestos que antes eran sólo para hombres.”
“Las mujeres sólo tienen una labor en el deporte: coronar a los campeones con guirnaldas”, dijo Pierre de Coubertin sobre la participación femenina en los Olímpicos, idea con la que Longoria no concuerda.
“Hoy por hoy tenemos la oportunidad de presentar nuestras habilidades y aptitudes para pelear por puestos de decisión. En la Comisión del Deporte han estado varias mujeres, como Marijose Alcalá, Jackie Nava y Ana Guevara; en los últimos años hemos crecido porque antes ni lo soñábamos. Me enorgullece ver que a muchas secretarias y diputadas apoyando al deporte y seguiremos en la búsqueda de la equidad”, aseveró la multimedallista.
▲ Clara Brugada, jefa de Gobierno de la Ciudad de México, presentó las playeras y medallas conmemorativas del Medio Maratón y Maratón. Estuvo acompañada por la ultramaratonista Lorena Ramírez (izquierda) y Javier Peralta, titular de Instituto del Deporte capitalino. Foto cortesía Indeporte CDMX

▲ La presidenta del Comité Olímpico Internacional llega con la misión de reforzar la confianza y credibilidad del organismo. Foto Afp
Protegidos, los recursos de sus clientes, aseguran
JULIO GUTIÉRREZ
Intercam, CIBanco y Vector, negaron ser instituciones que faciliten el lavado de dinero de cárteles de la droga como planteó el Departamento del Tesoro de Estados Unidos por medio de la Red de Control de Delitos Financieros (FinCEN).
En comunicados difundidos por separado horas después de las acusaciones, las entidades aseguraron estar dispuestas a colaborar con las autoridades mexicanas y estadunidenses para aclarar la situación, además de garantizar a sus clientes que sus recursos están protegidos.
La primera en emitir una postura fue Vector, la casa de bolsa fundada por Alfonso Romo; la segunda fue Intercam, cuyo presidente del consejo de administración es Eduardo García Lecuona Mayeur, y la última fue CIBanco, que opera desde hace 40 años en México.
“Vector rechaza categóricamente cualquier imputación que comprometa su integridad institucional. Con más de 50 años de trayectoria, nuestra casa de bolsa ha operado con los más altos estándares de cumplimiento normativo, auditoría interna y supervisión por parte de las autoridades financieras nacionales.”
Intercam señaló: “Negamos ta-
jantemente la vinculación de esta institución con cualquier práctica ilícita, particularmente lavado de dinero, y reiteramos nuestro compromiso con la transparencia y la legalidad”.
Y CIBanco apuntó: “Con relación al reciente anuncio del Departamento del Tesoro de Estados Unidos, el banco precisa que no mantiene relación con actividades ajenas a la legalidad y reitera el cumplimiento de todos los lineamientos establecidos por las autoridades competentes”.
La tercia de instituciones también se respaldó en la postura emitida por la Secretaría de Hacienda y Crédito Público (SHCP), en el sentido de que el Tesoro estadunidense no aportó pruebas sobre las acusaciones.
Se solicitó la postura de la Asociación de Bancos de México (ABM) sobre el tema, pero al cierre de esta edición, no se recibió respuesta.
En febrero pasado, luego de que Estados Unidos designó a los cárteles mexicanos como organizaciones terroristas, los bancos dijeron que era un tema que tomaban con calma.
“Nos sentimos con mucha tranquilidad, pero también con mucha responsabilidad de hacer que las cosas se sigan haciendo bien en la banca y así lo continuamos haciendo… Tenemos que ver qué es lo que quiere el gobierno de Estados Unidos, pero, como dice el dicho, no hay que ponerse el huarache antes de espinarse”, declaró el entonces presidente de la ABM, Julio Carranza.
La compañía es “víctima de un sistema judicial sometido a intereses políticos”, dice
El Grupo Salinas, propiedad del empresario Ricardo Salinas Pliego, calificó este miércoles como “arbitraria e ilegal” y “guiada por presiones políticas” la resolución por la cual el martes se ordenó a Grupo Elektra –una de las subsidiarias del consorcio– el pago de un adeudo por 2 mil millones de pesos correspondiente al ejercicio 2010.
En un comunicado, la compañía señaló ser “víctima de un sistema judicial sometido a presiones e intereses políticos”, luego de que el segundo tribunal colegiado en materia administrativa del primer circuito le negara un amparo “sólidamente fundamentado”.
Participan en el mercado de divisas, inversión y pagos internacionales
JULIO GUTIÉRREZ
Intercam, CIBanco y Vector, instituciones financieras que fueron acusadas de lavado de dinero por el gobierno estadunidense, tienen una participación activa en el mercado de divisas, gestorías de inversión y pagos internacionales, según indican los intermediarios en sus sitios oficiales.
En México, el conjunto de las entidades con todas sus líneas de negocio cuenta con activos que superan 360 mil millones de pesos, de acuerdo con información oficial de la Comisión Nacional Bancaria y de Valores (CNBV).
En el sistema local, Intercam Banco figura como el único intermediario que forma parte de un Grupo Financiero (Grupo Financiero Intercam); CI reporta como banco y como casa de bolsa y, bajo esta última figura, también opera Vector.
Los señalamientos hechos por el Tesoro estadunidense son claros: a Intercam y a CI los acusa en el
negocio bancario y, a Vector, por el único que tiene, el de la casa de bolsa.
En el sector bancario, Intercam y CIBanco, al cierre del primer trimestre, contaban con activos conjuntos por un monto de 248 mil 975 millones de pesos, el equivalente a 1.64 por ciento de los totales del sector de banca múltiple, de acuerdo con información de la CNBV.
Y en el de casas de bolsa, Vector tenía 3.73 por ciento de los activos al concluir el primer trimestre del año, con un monto de 45 mil 402 millones de pesos, según datos oficiales.
Operaciones desde hace más de 40 años
CI (Consultoria Internacional) es una institución que fue fundada en 1983 como casa de cambio y en 2008 obtuvo su licencia bancaria. Actualmente, ofrece servicios y estrategias de inversión, al mismo tiempo de participar en el mercado de divisas. Así mismo, cuenta con una licencia independiente de casa de bolsa.
El presidente del consejo de administración de CIBanco es Jorge Rodrigo Mario Rangel de Alba Brunel, en tanto, Mario Maciel Castro es su director general.
El banco y la casa de bolsa, en conjunto, cuentan con activos por 169 mil 614 millones de pesos, de acuerdo con la CNBV. Intercam es una institución cuyo presidente del consejo de administración y director general del grupo financiero es Eduardo García Lecuona.
Intercam, que se define a sí mismo como “el banco del nearshoring”, ofrece al público servicios de pagos internacionales, inversiones y financiamientos, y se especializa en el sector empresarial. El banco, por sí solo, reportó activos por 87 mil 797 millones de pesos al concluir el primer trimestre del año, mientras el grupo financiero en su conjunto contaba con 146 mil 7 millones de pesos, según la autoridad reguladora. Vector Casa de Bolsa –fundada por Alfonso Romo, quien fuera jefe de la oficina de la presidencia del gobierno de Andrés Manuel López Obrador, entre 2018 y 2021–proporciona servicios de banca de inversión, asesoría patrimonial y también participa en el mercado de divisas, según su portal de Internet. Como presidente del consejo de administración, aparece Raúl Gerardo Farías Arizpe y al concluir el primer trimestre del año reportó a los reguladores activos por 45 mil 6 millones de pesos.
La decisión del tribunal federal se dio a conocer el martes y se emitió por unanimidad de votos. La empresa aún puede impugnar la sentencia mediante un recurso de revisión, el cual tendría que ser resuelto por la Suprema Corte de Justicia de la Nación (SCJN) (https:// bit.ly/3IdovZc).
Grupo Elektra acusa que los integrantes del referido tribunal colegiado resolvieron el caso con una sentencia que reproduce el mismo patrón y guion utilizados en el revés que ya habían sufrido la semana pasada por parte del décimo tribunal colegiado (https://bit.ly/3HSuMtt).
Más aún, apunta que la nueva resolución en su contra “no se trata de decisiones aisladas, sino de una justicia alineada y que responde a un proyecto político, como consecuencia directa de la reciente farsa electoral judicial”. Añadiendo que así “el Poder Judicial comienza a institucionalizar la extorsión fiscal en lugar de proteger los derechos de los contribuyentes”.

JESSIKA BECERRA
Los cambios abruptos en las políticas comerciales de Estados Unidos podrían debilitar las condiciones para hacer negocios en América Latina relacionados con el mineral de hierro y el carbón metalúrgico, que se utilizan en la fabricación de acero, advirtió la calificadora Moody’s.
“Los aranceles aumentan el riesgo de debilitar la demanda de porcelana de metales básicos, incluido el cobre, lo que en última instancia provocará una caída en los precios globales. Por su parte, los fabricantes de productos químicos y acero se enfrentarán a un exceso de oferta.
“Los metales preciosos seguirán siendo una inversión segura, lo que beneficiará a los productores de oro y plata, como la mexicana Fresnillo y las peruanas Buenaventura y Volcán”, aclaró la firma.
En el análisis, los exportadores de materias primas son los más expuestos a grandes cambios en el comercio global, pues la política comercial de Estados Unidos aumenta las vulnerabilidades actuales de América Latina.
“La región tiene ciertas ventajas competitivas gracias a sus grandes reservas de minerales y metales y su abundante energía renovable”, sostuvo la institución financiera en su informe.
Las industrias orientadas al con-
sumo tienen una baja exposición a los aranceles, lo que beneficiaría a la industria agropecuaria.
A su vez, la creciente demanda de China impulsará las exportaciones de carne de res, cerdo y ave de América Latina, y los requerimientos de soya también es probable que aumenten a medida que Estados Unidos reduzca las exportaciones al país asiático.
Respecto al sistema financiero, Moody’s dijo que además de México, los bancos de América Latina tienen una exposición directa limitada a las industrias que son vulnerables a los cambios de las políticas comerciales. Sin embargo, una mayor inflación, tasas de interés más altas y un menor crecimiento aumentarían el riesgo de deterioro en la calidad de los activos, su rentabilidad y capital.
Moody’s dijo que la mayoría de los países latinoamericanos lucharían contra cualquier deterioro de las condiciones económicas y financieras globales.
“Sin embargo, los lazos de México con la economía estadunidense lo dejan particularmente expuesto a cambios en la política comercial, ya que las exportaciones a ese país representan tres cuartas partes del total y alrededor de 30 por ciento de su producto interno bruto.”
Recordó que los aranceles afectarían especialmente al sector automotor, aunque el T-MEC ofrece cierta protección.

BRAULIO CARBAJAL
México y Estados Unidos fortalecieron este miércoles su alianza estratégica en la cadena de semiconductores, materiales indispensables para la fabricación de teléfonos inteligentes, ordenadores, coches, frigoríficos y para prácticamente cualquier aparato electrónico, informó la Secretaría de Economía (SE).
En el marco del foro de colaboración en semiconductores entre México y Estados Unidos, Capítulo 4, celebrado en Phoenix, Arizona, Diego Flores Jiménez, titular del sector de Industria Electrónica y Digital de la SE, destacó los esfuerzos conjuntos para avanzar hacia una mayor integración de las
JOHN SAXE-FERNÁNDEZ.”
Después de que Estados Unidos bombardeara tres sitios nucleares de uso civil iraní el pasado 21 de junio, destacados funcionarios del gobierno de Trump como Marco Rubio, secretario de Estado, y J.D. Vance, vicepresidente, salieron a distintos medios a afirmar que no era el objetivo de esos operativos el cambio de régimen, inmediatamente descalificados por el presidente Trump cuando posteó que si bien “no era un término políticamente correcto”, si el régimen es incapaz de hacer a Irán Grande otra vez (MIGA, por sus siglas en inglés) ¿por que no puede haber un cambio de régimen? (sic) (Truthout).
Queda claro que la excusa de la inminente bomba nuclear fue un recurso falaz. A decir de Charles Freeman, ex embajador estadunidense, “el objetivo de los israelíes es promover un cambio de régimen y fragmentar Irán en distintas comunidades étnicas… De manera similar a lo que han intentado en Siria… ¿Quieren hacer lo mismo con Irán? No se puede hacer eso sin la ayuda de Estados Unidos” (entrevistado por India & Global Left, 22/6/25).
El domingo 15 debía celebrarse en
Omán la sexta ronda de negociaciones EU-Irán. sobre el tratado de no proliferación nuclear, donde el punto de discusión hubiera sido el derecho inalienable de todos los países a enriquecer uranio con fines civiles, cancelado por el bombardeo de Israel contra Irán.
Como lo recuerdan Alain Gresh y Sarra Grira ya en mayo de 2018, alentado por Netanyahu, Donald Trump retiró la firma de EU del tratado nuclear iraní firmado tres años antes, y que había sido respaldado en dos resoluciones por el Consejo de Seguridad de Naciones Unidas. Por tanto, por segunda vez, Israel sabotea una salida diplomática. (“Israel sumerge a Oriente Medio en el caos”, VientoSur, 20/6/25) Para el coronel (retirado) Douglas Macgregor, veterano de guerra y hoy analista político, (en entrevista con Glenn Diesen, 22/6/25) “el presidente Trump hizo lo que pudo para crear la ilusión de que estábamos interesados en algún tipo de resultado negociado y eso ayudó a desarmar a los iraníes. Esta es una guerra por la hegemonía del Estado judío, lo que implica la conquista y aseguramiento de los campos de petróleo y gas en la región, como sucedió con Rusia: esa guerra siempre trato de eliminar a Putin, fragmentar Rusia, despojarla de sus recursos y convertir lo que quedara en un Estado
cadenas globales de suministro. El funcionario hizo énfasis en la mayor cooperación para atraer inversión estratégica en procesos de gestión de inventarios, cadena de suministro, y el desarrollo de talento especializado con miras a posicionar a América del Norte como una región clave en la nueva geopolítica del siglo XXI.
Arizona es el epicentro emergente de la industria de semiconductores en Estados Unidos, destaca por su infraestructura, el desarrollo de la industria y su conectividad con México.
En 2024, de acuerdo con la Arizona Commerce Authority, las exportaciones a México alcanzaron 8.9 mil millones de dólares, incluyendo más de 824 millones de dólares en componentes elec-
vasallo, propiedad en gran parte de los bancos de Londres y Nueva York”. De hecho, como recuerda Michael Hudson, “Estados Unidos se apoderó de 300 mil millones de dólares de los ahorros monetarios de Rusia en Occidente en 2022” (¿Por qué EU está en guerra con Irán?, Counterpunch.org, 23/6/25).
A pesar del plan fallido, Israel trata de aplicarlo a Irán, un país con más de 90 millones de habitantes, una potencia continental casi del tamaño de Europa occidental, un Estado mucho mas avanzado tecnológicamente y mucho más capaz al de hace 20 años.
Sin embargo, Tel Aviv continúa su diseño neocolonial para derrocar al régimen iraní con la experiencia en Siria, donde la caída del régimen de Bashar Al-Assad le sirvió “no sólo para ampliar el territorio que ya ocupa ilegalmente en el Golán, sino para avivar las tensiones internas bombardeando regularmente el territorio, tratando de establecer relaciones con las “minorías” para impedir la reconstitución de un Estado estable” (VientoSur, op cit.).
Y, es que a decir de Michael Young, “para los israelíes la fragmentación de Siria y de los países árabes circundantes sería una bendición… Estados árabes debilitados también abren otras puertas, en particular la que permite a Israel proceder a una limpieza étnica
▲ Funcionarios del gobierno de Arizona y de la SE participaron en el foro de colaboración en semiconductores Foto Secretaría de Economía
trónicos y semiconductores. En el encuentro se subrayó el papel estratégico de instituciones como la Arizona State University y el liderazgo de la Secretaría de Economía para generar condiciones propicias para la inversión en este sector que continúa creciendo.
“México se posiciona como un aliado clave en el rediseño de las cadenas globales de suministro impulsado por el Plan Maestro de Semiconductores 2024-2030 y el Plan México”, dijo la SE.
de la población palestina, empujándola hacia los países vecinos, sin encontrar mucha resistencia. Estas serían las ventajas de una partición del país según líneas etno-confesionales” (L’OrientLe-Jour, 16/1/25).
Pero, ¿cuál es el objetivo que persigue EU al intervenir en esta confrontación entre Israel e Irán? Se puede decir que la idea de un Irán desmembrado y balcanizado ha sido un deseo compartido con el gobierno sionista y eje de su plan maestro para reconfigurar al Medio Oriente en función de sus intereses. Desde el ataque a las Torres Gemelas, el cual se utilizó de pretexto para acumular poder y lanzar la guerra contra Irak –y 6 países más– con el invento de las armas de destrucción masiva, a decir de Michael Hudson, “lo que está en juego es el intento de Estados Unidos de controlar Medio Oriente y su petróleo, como un puntal de su poder económico, y de impedir que otros países avancen para crear su propia autonomía respecto del orden neoliberal centrado en Estados Unidos y sus instituciones”. Y no sólo eso: derrotar a Irán sería interrumpir un tramo importante del programa de la Franja y la Ruta de China y lograría bloquear el comercio ruso a través del mar Caspio, amenazando a Rusia desde su flanco sur (Op. cit.) Un tiro a tres bandas.





































































Bessent: ¿realidad o ficción? // Banca, lavandería industrial // CIBanco, Intercam y Vector
CARLOS FERNÁNDEZ-VEGA
DADOS LOS ANTECEDENTES, nada raro sería que la denuncia tenga sustento, aunque la Secretaría de Hacienda asegura que el gobierno mexicano “no recibió pruebas y a la fecha no contamos con ninguna información”, pero el hecho es que el titular del Departamento del Tesoro estadunidense, Scott Bessent, lanzó una bomba al sistema financiero que opera en nuestro país: “Facilitadores financieros como CIBanco, Intercam y Vector ayudan al envenenamiento de innumerables estadunidenses al mover dinero para los cárteles, lo que los convierte en piezas claves en la cadena de suministro de fentanilo”.
ALGO MÁS: “CIBANCO e Intercam, bancos comerciales con más de 7 mil y 4 mil millones de dólares en activos totales, respectivamente, y Vector, una firma de corretaje que gestiona casi 11 mil millones en activos, han desempeñado conjuntamente una función vital y de larga data en el lavado de millones de dólares para cárteles con sede en México y en la facilitación de pagos para la adquisición de precursores químicos necesarios para la producción de fentanilo” (La Jornada, Dora Villanueva).
EN EL DETALLE, el Departamento del Tesoro acusa a CIBanco (que preside Jorge Rangel de Alba) de “lavar dinero a los cárteles de los Beltrán Leyva, Jalisco Nueva Generación (CJNG) y del Golfo, así como de haber facilitado la adquisición de precursores químicos de China con fines ilícitos”. A Intercam (la cabeza visible es Eduardo García Lecuona), de “haber procesado transferencias de fondos en dólares que financian la adquisición de precursores químicos de China en nombre de organizaciones narcotraficantes, al tiempo que ejecutivos de esa institución se reunieron directamente con integrantes del CJNG para discutir esquemas de lavado de dinero”. Y a Vector (a cargo de Edgardo Cantú Delgado, aunque el presidente honorario es Alfonso Romo), de “facilitar esquemas financieros a los cárteles de Sinaloa y del Golfo, y de posibilitar la adquisición de precursores químicos de China con fines ilícitos”.
EXPLOSIVO, SIN DUDA, pero no hay que desestimar las muy sucias prácticas de Donald Trump para presionar a los gobiernos, y ésta podría ser una de ellas, aunque el sistema financiero que opera en México tiene ficha roja desde hace muchos años. Aun así, lo que Bessent omite es que al menos desde hace casi tres déca-
das el Departamento de Estado ha denunciado esas prácticas y, lejos de contribuir a clausurar la enorme industria financiera del lavado de dinero, ésta se mantiene boyante aquí, allá y acullá, sin olvidar que buena parte del efectivo ya limpio y planchado retorna a Estados Unidos para depositarse y/o invertirse en las propias instituciones financieras de su país.
COMO CÁPSULA DE memoria: en 1996 (sexenio de Zedillo), el Departamento de Estado denunció que el sistema financiero mexicano fue “elegido por los cárteles internacionales de la droga como el principal centro de lavado y repatriación de dinero proveniente del narcotráfico en el hemisferio occidental; sólo ese año habría lavado alrededor de 30 mil millones de dólares”.
AGREGABA: COLOCADO EN el sistema financiero que opera en México, el dinero se mueve en una amplia variedad de formas, incluyendo transferencias en línea e inversiones en bancos mexicanos, pagaderas directamente en cuentas paralelas en Estados Unidos, luego de la emisión y renvío por medio de cheques personales. “El gobierno mexicano ha hecho poco por contener esas prácticas, que resultan extremadamente benéficas para la comunidad bancaria y los corredores criminales que explotan ese sistema operativo. Un creciente número de empresas legales son utilizadas por los lavadores para transparentar las operaciones del narcotráfico”.
Y A PARTIR de esa fecha, el sector financiero que opera en México se lleva la palma, sin dejar de lado que resulta imposible que los bancos no registren esos colosales montos. En su informe correspondiente a 2009, en pleno gobierno de Felipe Calderón, el Departamento de Estado advirtió que de la multimillonaria cantidad que aquí circula ilegalmente en el sistema bancario, la Procuraduría General de la República sólo fue “capaz” de detectar uno por ciento del total. ¿Y la “guerra contra el crimen organizado”?
Las rebanadas del pastel
SI EL DEPARTAMENTO de Estado asegura que desde 1996 el sistema financiero que opera en México “lava” anualmente cerca de 30 mil millones de dólares, en los últimos 29 años alrededor de 870 mil millones provenientes de Estados Unidos han pasado por esa lavandería, monto equivalente a cerca de 50 por ciento del producto interno bruto. ¿Y cuánto regresa al sistema financiero estadunidense?
X: @cafevega
Correo: cfvmexico_sa@hotmail.com

CLARA ZEPEDA
El peso mexicano acumuló ayer tres días de ganancias. Ante el rebrote de optimismo en la sesión previa, alentado por el alto el fuego entre Irán e Israel, la moneda mexicana tuvo una apreciación diaria de 0.36 por ciento, equivalente a 6.36 centavos, para cerrar en 18.9244 pesos por dólar spot, a la par del debilitamiento del dólar.
De acuerdo con el Banco de México, el tipo de cambio operó entre un máximo de 18.9370 unidades y un mínimo de 18.9000 en el mercado al mayoreo.
La moneda nacional ha acumulado en tres jornadas una apreciación de 1.27 por ciento o 24 centavos. En el año, la recuperación frente al dólar ha sido de 9.38 por ciento. El mercado está a la espera de la decisión de política monetaria del Banco de México. Se prevé que hoy baje la tasa de referencia de 8.5 a 8 por ciento. No obstante, el dato de inflación provocó mucho ruido. El dólar, que intentó recuperarse en la mañana, cerró con un retroceso de 0.17 por ciento frente a divisas de países desarrollados, según el índice DXY, en 97.29 unidades, un nivel no visto desde marzo de 2022. Los rumores de que Donald Trump está preparando el relevo de Jero-
me Powell, presidente de la Reserva Federal, tuvieron un fuerte impacto en el mercado cambiario.
Los mercados accionarios cerraron mixtos y el petróleo tuvo ligeras ganancias. El Nasdaq avanzó 0.31 por ciento, a 19 mil 973.55 puntos; mientras el S&P 500 permaneció en 6 mil 92.16 enteros y el Dow Jones bajó 0.25 por ciento, a 42 mil 982.43 unidades, luego del segundo día de comparecencias semestrales de Powell ante el Senado de Estados Unidos.
“Durante su participación, el funcionario recordó la importancia de mantener la paciencia y esperar nuevos datos antes de tomar decisiones sobre la tasa de referencia”, precisó Actinver.
La Bolsa Mexicana de Valores avanzó 0.33 por ciento, a 56 mil 933.19 puntos.
Los precios del petróleo subieron por una caída de las reservas de crudo estadunidense mayor a la esperada y por una demanda sostenida de gasolina en Estados Unidos, indicaron analistas.
El precio del barril de petróleo Brent del Mar del Norte para entrega en agosto ganó 0.8 por ciento, a 67.68 dólares. Su equivalente estadunidense, el West Texas Intermediate, para entrega también en agosto, subió 0.85 por ciento, a 64.92 dólares.
Repuntaron los conflictos laborales 20.4% en 2024; la mayoría, por despido ilegal
Durante 2024 se presentaron en México 95 mil 226 conflictos laborales, un aumento de 20.4 por ciento frente a 2023, cuando sumaron 70 mil 69, la cifra más baja desde que el Instituto Nacional de Estadística y Geografía (Inegi) tiene registro (2016). Casi todos los conflictos fueron individuales y siete de cada 10 se debieron a despido injustificado. A su vez, los colectivos representaron sólo 0.1 por ciento y el motivo más recurrente fue la titularidad de contratos, con 32.9 por ciento, seguida de la suspensión de relaciones, con 10.7 por ciento. De acuerdo con la Estadística sobre Relaciones Laborales de Jurisdicción Local, que este miércoles dio a conocer el Inegi, los emplazamientos a huelga se incrementaron 16.6 por ciento respecto a 2023, de mil 260 a mil 469. De ese total, 36.4 por ciento se originaron por demanda por revisión de contrato y 20.6 por ciento por revisión salarial. Los emplazamientos a huelga
solucionados disminuyeron 33.7 por ciento respecto a 2023, de 2 mil 989 a mil 982. Del total de emplazamientos, en 34 por ciento se determinó que no cumplían los requisitos de ley y 17.6 por ciento se resolvieron por desistimiento. Entre 2023 y 2024 se observó una disminución de cuatro a dos huelgas estalladas. Los dos paros de 2024 se realizaron en Baja California Sur y se solucionaron el mismo año.
El Inegi estimó que en 2024 se suscribieron 484 mil 827 convenios de trabajo prejudiciales, de los cuales 451 mil 970 se derivaron de expedientes en los cuales se logró la conciliación laboral antes del juicio. Los acuerdos más frecuentes firmados en los convenios de trabajo prejudiciales fueron el retiro voluntario, con 46 por ciento, y la indemnización, con 35.5 por ciento. Las entidades federativas con el mayor número de convenios prejudiciales fueron Nuevo León, con 11.9 por ciento; Sonora, 10.7;
“Bombardeos a plantas iraníes equivalen al de Hiroshima por acabar una guerra” // Aboga Teherán por una región sin arsenal atómico si Tel Aviv hace lo mismo
Estados Unidos retomará conversaciones con Irán la próxima semana, anunció el presidente, Donald Trump, aunque afirmó que no cree necesario un acuerdo sobre el programa nuclear de la república islámica después del bombardeo a sus tres instalaciones atómicas, Fordo, Natanz e Isfahán la semana pasada, en una arremetida que comparó con los bombardeos sobre Hiroshima y Nagasaki en 1945, que causaron entre 150 y 246 mil muertos, en su mayoría civiles. En tanto,Teherán abogó por un Medio Oriente “libre de armas nucleares y de destrucción masiva, siempre que Israel haga lo mismo”.
El magnate insistió en desestimar la evaluación de la agencia de
Inteligencia de Defensa, adscrita al Pentágono, que indica que los bombardeos de Washington no destruyeron los elementos centrales del programa atómico de Teherán; en cambio, aseveró que los pilotos que realizaron la operación el 22 de junio, “obtuvieron un éxito legendario.
“No quiero usar el ejemplo de Hiroshima, no quiero usar el ejemplo de Nagasaki, pero fue esencialmente lo mismo. Aquello acabó con aquella guerra (Segunda Guerra Mundial). Esto puso fin a la guerra” de los 12 días que inició Israel contra Irán en la madrugada del 13 de junio, aseveró Trump. “Hemos destruido la energía nuclear”, aseguró y adelantó que en la próxima reunión con Teherán, Washington pedirá lo mismo que antes de que Israel iniciara sus ataques: “No queremos nada nuclear (en Irán)”.
Ataques israelíes matan a 78 palestinos // Se agudiza la crisis de salud y alimentaria: Middle East Eye
mediadores israelíes y árabes a reanudar las negociaciones para un posible acuerdo sobre Gaza.
El presidente Donald Trump pretende aprovechar la inercia del momento tras el acuerdo de cese de hostilidades entre Irán e Israel e impulsar negociaciones para poner fin al enfrentamiento entre Tel Aviv y Hamas, así como para la liberación de los cautivos en el enclave tras 20 meses de conflicto.
“Creo que se están logrando avances en Gaza”, afirmó ayer el magnate a los periodistas en Países Bajos, y señaló que los ataques de Washington contra Teherán pueden tener un efecto positivo en Medio Oriente.
El mandatario añadió que su emisario especial, Steve Witkoff, le dijo que “Gaza está muy cerca” de una solución.
De acuerdo con The Wall Street Journal, tras meses de estancamiento, ha habido indicios de nueva actividad. Horas antes de que Trump anunciara el alto el fuego entre Israel e Irán, Witkoff llamó a
En tanto, el grupo de resistencia palestina confirmó ayer por separado a la agencia francesa de noticias Afp que las conversaciones con los mediadores para alcanzar una tregua “nunca se detuvieron e incluso se intensificaron en las últimas horas”, afirmó Taher al Nunu, un alto cargo de Hamas.
“Nuestros contactos con los hermanos mediadores egipcios y cataríes nunca se detuvieron, y se intensificaron en las últimas horas", declaró al Nunu. Sin embargo, el dirigente reportó que no han recibido todavía ninguna propuesta nueva para un alto el fuego.
Por su parte, el primer ministro israelí, Benjamin Netanyahu, se enfrenta a una presión cada vez más fuerte de la oposición, los familiares de los rehenes retenidos en Gaza e incluso de miembros de su coalición para poner fin a la guerra en el enclave, que estalló tras el ataque de Hamas en Israel del 7 de octubre de 2023.
El secretario de Defensa estadunidense, Pete Hegseth, tiene previsto revelar hoy la magnitud del daño causado al programa nuclear iraní y “luchar por la dignidad de los grandes pilotos”, señaló Tump, quienes “estaban muy disgustados” por la información “falsa” que difundieron “CNN y el fracasado The New York Times”, al publicar un informe preliminar de inteligencia que afirmaba que los ataques estadunidenses sólo retrasaron unos meses las ambiciones nucleares de Teherán. A su vez, el republicano calificó de “ridícula cacería de brujas” y “espectáculo de terror” el juicio en Israel contra Netanyahu por corrupción, al enterarse de que el premier debe comparecer el lunes para continuar con el proceso iniciado en 2020.
“Bibi y yo acabamos de pasar un infierno juntos, luchando contra Irán”, afirmó, y sentenció que
el juicio debería ser “cancelado” o “se debería conceder un indulto a un gran héroe”. También tachó de “injustas” las acusaciones contra Netanyahu, un “guerrero como ningún otro”, y advirtió: “Fue Estados Unidos el que salvó a Israel, y ahora será Estados Unidos el que salve a Bibi Netanyahu. ¡Esta parlamentación (sic) de la justicia no se puede permitir!”
A su vez, Netanyahu aseguró que Fordo “está fuera de servicio” e imposibilitado de enriquecer uranio “por años”.
El director de la Agencia Central de Inteligencia (CIA), John Ratcliffe, afirmó que “información creíble” demuestra que “varias instalaciones nucleares iraníes claves fueron destruidas y que si se fueran a reconstruir tomaría años”. Teherán aún no dio datos oficiales sobre el asunto, porque “no se debe esperar que los expertos se
apresuren a visitar las instalaciones dañadas, mientras están siendo bombardeados”, subrayó Esmaeil Baqaei, vocero de la cancillería, quien también reprochó las felicitaciones del secretario general de la Organización del Tratado del Atlántico Norte (OTAN), Mark Rutte, a Trump, por su ofensiva contra Irán, en un mensaje revelado por el mandatario en su cuenta de Thrut Social: “Felicidades y gracias por su acción decisiva en Irán, que fue realmente extraordinaria”, escribió Rutte. “Es vergonzoso, despreciable e irresponsable que el secretario general de la OTAN califique de ‘realmente extraordinario’ un acto criminal de agresión contra un Estado soberano”, recalcó Baqaei. En tanto, el Ejecutivo iraní, Masud Pezeshkian, se declaró “partidario de crear una región sin armas nucleares, ni de destrucción masiva (…) bajo la condición de que esto también se aplique a Israel”. En este contexto, el Parlamento iraní votó ayer a favor de suspender la cooperación con el Organismo Internacional de Energía Atómica (OIEA) de la ONU “hasta que se garantice la seguridad de las instalaciones nucleares (iraníes)”, al argumentar que esa instancia “se negó incluso a condenar mínimamente el ataque a las instalaciones nucleares de Irán”, dijo el presidente de la Asamblea Consultiva Islámica, Mohammad Bagher Ghalibaf, en la televisión estatal, mientras los parlamentarios coreaban consignas como “muerte a Israel, muerte a Estados Unidos”.

En el terreno, la ofensiva israelí dejó al menos 78 muertos ayer en la franja, incluidos 14 que esperaban cerca de los centros de distribución de ayuda establecidos por la Fundación Humanitaria de Gaza, dijeron fuentes médicas, al tiempo que 71 camiones cargados de víveres entraron al enclave, en medio de la catástrofe que agobia a los palestinos, y que ha causado que los bebés estén al borde de fallecer, amenazados por la escasez de fórmula para alimentarse.
Middle East Eye advirtió de que una inminente debacle sanitaria amaga a recién nacidos y bebés prematuros en Gaza que luchan por sobrevivir.
Según el médico Yasser Abu Gha-
lee, jefe de la sección pediátrica del Hospital Nasser, “los niños de la franja, incluidos los sanos, sufren una escasez extrema de leche de fórmula, la cual “está agotada tanto en el sector privado como en el público”.
Ni siquiera hay leche de vaca en cantidades adecuadas, indicó, y la que se encuentra en las tiendas cuesta más de 59 dólares.
En tanto, el gobierno de Israel acusó “sin pruebas” a Hamas de estar haciéndose con el control de la entrega de ayuda humanitaria que entra por el norte de la franja.
▲ Personas con paquetes de ayuda transitan cerca del campo de refugiados de Nusseirat, en el norte de Gaza. Foto Eyad BABA / Afp
En este contexto, un funcionario bajo condición de anonimato informó al diario The Times of Israel que Tel Aviv suspendió el envío de ayuda a Gaza y subrayó que la pausa permanecerá vigente hasta que las Fuerzas de Defensa de Israel presenten un plan de acción durante las próximas 48 horas. Su declaración se produjo después de que el ministro de Finanzas, Bezalel Smotrich, amenazó con renunciar al gobierno si no se tomaban medidas urgentes respecto al envío de insumos, que acusó llegan directamente a Hamas.
El secretario general de la alianza llama a Trump el “papito” de los países en guerra // Anuncia el bloque 58 mil mdd para Kiev
AFP, REUTERS, EUROPA PRESS, XINHUA Y THE INDEPENDENT LA HAYA
Los líderes de la OTAN se reunieron para ratificar su compromiso de elevar el gasto en defensa a 5 por ciento del producto interno bruto (PIB) en la próxima década, en un acuerdo con el que la alianza renueva su horizonte de inversión militar bajo la presión del presidente de Estados Unidos, Donald Trump, quien aseguró que la cumbre fue un “gran éxito”.
No obstante, el primer ministro belga, Bart de Wever, señaló las dificultades de su país para alcanzar el nuevo objetivo aunque lo calificó de “realista” y evitó confrontar con la organización, como lo hizo España.
La declaración final de la cumbre en La Haya menciona que los países invertirán “al menos 3.5 por ciento” de su PIB al año en capacidad militar, de acuerdo con varias prioridades establecidas por la organización, como la defensa antiaérea, la logística, la ciberseguridad y los satélites.
Esta inversión debería permitir incrementar de manera global 30 por ciento las capacidades, quintuplicar el volumen de las defensas antiaéreas y añadir miles de tanques a los arsenales de la alianza, detalló el secretario general de la OTAN, Mark Rutte.
Además, los países deberán gasta 1.5 por ciento adicional de su PIB en la protección de infraestructura
crítica, como el control de fronteras e infraestructuras de servicios (puertos, aeropuertos y carreteras).
“Si no puedes llevar tanques al frente porque las carreteras o los puentes o los ferrocarriles no aguantan esos tanques ni su peso, entonces estos no tienen, obviamente, ningún valor”, explicó el embajador estadunidense ante la OTAN, Matthew Whitaker.
El capítulo del 1.5 por ciento incluye, igualmente, el concepto de “resiliencia”; es decir, todo aquello que la sociedad civil necesita en caso de conflicto para superar crisis.
El documento firmado por los líderes de las 32 naciones de la alianza es el “compromiso inquebrantable con la defensa colectiva”, y deberán presentar, sin excepciones, planes anuales que muestren “un camino creíble y progresivo para alcanzar esta meta”.
Al respecto, el mandatario estadunidense, Donald Trump, opinó en una conferencia de prensa al término de la cumbre: “Es una victoria monumental para Washington, porque estábamos cargando con lo que es mucho más que nuestra justa parte”.
De Weber recalcó que el objetivo de 5 por ciento fijado a la OTAN “no es tonto, es realista” y no hay cláusulas de escape posible.
La declaración justifica el incremento por la “amenaza a largo plazo planteada por Rusia a la seguridad euroatlántica y el riesgo persistente del terrorismo”.
Asimismo, garantiza “el apoyo a

Ucrania (en la guerra con Rusia), cuya seguridad contribuye a la nuestra”.
Los países de la alianza anunciaron que el apoyo militar a Kiev para finales de 2025 podría superar los 58.4 mil millones de dólares.
En tanto, Trump señaló que su comentario de “terminar con la guerra entre Moscú y Kiev en 24 horas” realizado durante su campaña electoral “fue sarcástico”.
Al ser consultado por periodistas sobre por qué no ha podido cumplir esa promesa, Trump respondió: “porque es más difícil de lo que la gente imagina (...) Vladimir Putin ha sido más difícil. Francamente, tuve algunos problemas con (el presidente de Ucrania, Volodymir) Zelensky. Quizás hayan leído sobre él, y ha sido más difícil que otras guerras”, declaró el magnate, quien sostuvo en La Haya una reunión con el presidente ucranio, en la que conversaron sobre una tregua en Ucrania y de la posible compra de sistemas de defensa antiaérea estadunidenses.
▲ Los mandatarios de Ucrania, Volodymir Zelensky, y de Estados Unidos, Donald Trump, platicaron en La Haya, Países Bajos, sobre cómo lograr una paz duradera frente a Rusia. Foto del gobierno de Ucrania vía Afp
La Casa Blanca considera enviar más misiles Patriot a Kiev
“Dialogamos sobre cómo lograr un alto el fuego y una paz real. Hablamos acerca de cómo proteger a nuestro pueblo”, escribió Zelensky en la red social X.
Trump apuntó que está considerando enviar más misiles Patriot a Kiev, dijo que no descarta un nuevo paquete de asistencia de defensa y reiteró su frustración ante la negativa de Putin de sentarse a negociar
la paz con el país eslavo invadido. Rutte, en tanto, no escatimó en elogios para el jefe de la Casa Blanca y se refirió a él como “papito”. Las cámaras captaron a Trump y Rutte conversando animadamente, cuando el republicano comentaba que Israel e Irán se comportaban como “dos niños en el patio de una escuela” y Rutte respondió: “hay momentos en que papito tiene que usar un lenguaje más duro”, al referirse al exabrupto de Trump la víspera, cuando dijo que Teherán y Tel Aviv “no saben qué carajos están haciendo”, ante los mutuos ataques después de acordada la tregua que él mismo anunció.
“Fuck Trump, fuck OTAN”, así cierra filas la izquierda con el presidente español
ARMANDO G. TEJEDA
CORRESPONSAL
MADRID
Ante la negativa del presidente del gobierno español, el socialista Pedro Sánchez, de aumentar el gasto en defensa más allá de 2.1 por ciento del producto interno bruto (PIB) y no llegar hasta 5 por ciento como el resto de países de la OTAN, el pre-
sidente de Estados Unidos, Donald Trump, amenazó a Madrid con una nueva guerra comercial, utilizando su coacción habitual: los aranceles. “La economía va muy bien, pero podría torcerse si algo malo pasara. Estamos negociando un acuerdo de comercio con España y les voy a hacer pagar el doble. Y lo digo en serio. Me gusta España. Conozco mucha gente de España. Es un gran lugar y son grandes personas. Pero España es el único país que se niega a pagar y eso es injusto”, aseguró Trump. La nueva andanada del magnate se originó a raíz de la postura discordante del presidente Sánchez en el último cónclave de la OTAN, en el que se convirtió en el
único mandatario que decidió plantarse ante las exigencias de Trump de aumentar el gasto militar. Sánchez firmó el acuerdo común de dedicar 5 por ciento de su PIB a un plan de defensa militar, pero confirmó que no aumentará el gasto militar en detrimento de los servicios públicos y las políticas sociales. “Todos los estados miembros saben de la garantía, de la confianza, de la predictibilidad, del compromiso que tiene España con la OTAN. Y eso además no son palabras vacuas, es que están los presupuestos, nos hemos comprometido a llegar a 2 por ciento siendo una administración que no adquirió ni asumió ese compromiso en 2014. Es un porcen-
taje suficiente, realista y compatible con nuestro modelo social, con nuestro estado de bienestar”. Estas palabras incrementaron la cólera de Trump, que amenazó de nuevo: “Lo haré por mi cuenta; va a pagar más”, dijo tras la breve cumbre de la OTAN, de tan sólo día y medio, en la que los presidentes de Estados Unidos y de España no coincidieron en ningún momento y ni siquiera hubo ocasión de que se dieran la mano.
La ofensiva de Trump contra Madrid indignó al resto de partidos de izquierda, que cerraron filas con el gobierno. La vicepresidenta segunda y líder de la coalición de izquierdas Sumar, Yolanda Díaz,
respondió: “España es soberana y no admite amenazas de nadie. No vamos a aumentar el gasto castrense para contentar a Donald Trump. Nuestra prioridad es el gasto social y nosotros nos debemos al pueblo español”.
Por su parte, el vocero en el Congreso de Esquerra Republicana de Catalunya (ERC), Gabriel Rufián, aseguró que “siempre es buena cosa cabrear (molestar) a un fascista neoliberal. Siempre ha sido una buena cosa cabrear a Trump”. Además, la líder de Podemos, Ione Belarra, afirmó: “por mucho que le moleste a la derecha hay que decir alto y claro, ‘fuck Trump y fuck OTAN’”.
TRUMP LO LLAMA “COMUNISTA LUNÁTICO”
En el estado de tradición demócrata gana las primarias del partido un político musulmán con amplio empuje de nuevas generaciones
DAVID BROOKS Y JIM CASON CORRESPONSALES
NUEVA YORK Y WASHINGTON
En una de las sorpresas electorales más grandes de la historia del país, un joven socialista democrático tumbó a la vieja guardia de Nueva York al perfilarse como el ganador de una elección primaria para alcalde al derrotar a una figura nacional demócrata financiada por multimillonarios y endosado por la cúpula política, económica y mediática de la ciudad más grande de Estados Unidos.
Tanto el triunfo de Zohran Mamdani, de 33 años de edad –el cual será oficial con el conteo final del 1º de julio–, sacudió no sólo las cúpulas de Nueva York, sino a escala nacional, en particular al Partido Demócrata. Su campaña impulsada por decenas de miles de voluntarios, en su mayoría jóvenes, se enfrentó a la poderosa maquinaria detrás de su principal competidor, el ex gobernador Mario Cuomo, quien desde el arranque de este concurso el año pasado había encabezado todas las encuestas por márgenes amplios ante sus 10 retadores, incluyendo Mamdani.
El triunfo de este político, descendiente de indios y nacido en Uganda, está provocando júbilo entre sectores progresistas de un Partido Demócrata visiblemente a la deriva después de su derrota nacional, y asombro temeroso entre viejos bastiones del poder. El ganador declaró en su mitin de celebración: “hicimos historia” y citó a Nelson Mandela: “siempre parece imposible hasta que se hace”.
Tal vez el mejor resumen de como lo perciben las cúpulas fue el de The Wall Street Journal: “La mañana del miércoles, el epicentro mundial del capitalismo se despertó para encontrar que pronto podría tener alcalde socialista”.
Hasta el presidente de Estados Unidos, Donald Trump, decidió comentar: “Ya finalmente ocurrió. Los demócratas han cruzado una línea. Zohran Mamdani, un comunista lunático 100 por ciento, acaba de ganar una primaria”, escribió.
Hace sólo unos días, la junta editorial del periódico más influyente de la ciudad y del país, The New York Times, calificó a Mamdani de “no elegible” para ocupar la alcaldía, sobre todo por su inexperiencia y propuestas inviables.
Pero el político miembro de la Asamblea neoyorquina demostró que no sólo es “elegible”, sino que su mensaje de mayor igualdad, más servicios públicos financiados por mayores impuestos sobre los ultra-

ricos y una ciudad “más asequible” para todos logró motivar una ola de apoyo. Más aún: ahora es parte de un elenco de figuras progresistas, que se identifican como “socialistas democráticos”, que buscan transformar la política electoral del país.
Su campaña fue endosada por las principales figuras de este movimiento, el senador Bernie Sanders y la diputada federal Alexandria Ocasio-Cortez.
Cuomo ha recibido apoyo de la cúpula demócrata local y nacional, incluyendo el ex presidente Bill Clinton y el ex alcalde y multimillonario Michael Bloomberg, quien encabezó un elenco de donantes ricos, entre ellos los titanes de Wall Street y otros sectores alineados con el liderazgo demócrata.
Sorprende a analistas y a sus adversarios de manera irrefutable
Pero el triunfo del treintañero fue tan definitivo que Cuomo reconoció su derrota la noche del martes poco después del cierre de las casillas y el inicio del conteo, con sus simpatizantes y patrocinadores en shock al ver los resultados. No descartó la posibilidad de presentarse como candidato independiente en la elección general para alcalde en noviembre. Mamdani declaró la noche de la elección que todo indicaba que será el abanderado demócrata, lo cual será confirmado oficialmente el 1º de julio. El sistema empleado por la ciudad para las primarias permite que los electores seleccionen hasta cinco candidatos en orden de preferencia, y si nadie de ellos alcanza 50 por ciento en el primer cálculo, se hace un segundo conteo al integrar las segundas (y si es necesario, las terceras, etcétera) opciones. Nadie logró superar ese porcentaje, por lo tanto habrá conteo final hasta el próximo día 1º. Pero la decisión de Cuomo de conceder, antenoche, aun antes de que se contaran las segundas preferencias indicaba que evaluó que no había posibilidad de superar el déficit de apoyo. Nueva York es una ciudad mayoritariamente demócrata y por lo tanto se supone que el triunfador de la primaria de ese partido ganará
tendrá esta sorpresa a escala nacional sobre las fuerzas progresistas, aspecto que los analistas ya están evaluando.
Otra dimensión de la contienda en la era de Trump y la coalición de derecha es no sólo el sorprendente triunfo de un socialista democrático, sino también de un joven y un musulmán –si llega a la alcaldía será el ocupante de menor edad en un siglo y el primer musulmán en una de las ciudades más antiguas del país. Además, el triunfo aparente de Mamdani fue en parte gracias a un mosaico de apoyo muy neoyorquino, ciudad cuya población es 40 por ciento migrante y donde se hablan más de 200 idiomas. De hecho, Mamdani, que nació en Uganda con padres de origen indio, es ejemplo de ese mosaico. Su madre es Mina Nair, directora de cine nominada en los Oscar por Salaam Bombay y de otras obras como Mississippi Masala; su padre es Mahmood Mamdani, profesor en la Universidad de Columbia (https://www.instagram. com/reel/DLR19--u1Uc/?igsh=MXg 4dmtqeWJ6OHYwNA%3D%3D). El triunfo de Mamdani no sólo asusta a la derecha, sino también a la cúpula nacional del Partido Demócrata. En lugar de festejar la elección, la más importante tras la derrota humillante ante Trump, entre las primeras reacciones de los círculos cupulares del partido se hallan las de descartar lo ocurrido en Nueva York como guía para la estrategia nacional del partido, y por supuesto advertencias de que serán calificados de “radicales” y “marxistas” por contrincantes (este miércoles The New York Times advirtió que Mamdani tiene una “agenda de utraizquierda”).
▲ Zohran Mamdani (en imagen de su campaña) tuvo una ventaja tan amplia en los comicios primarios que su principal rival, el ex gobernador de Nueva York Andrew Cuomo, admitió su derrota antenoche. Foto Afp
la elección general en noviembre. Pero esta vez podría ser más difícil si Cuomo decide participar de forma independiente en esos comicios, algo que ya decidió el actual alcalde de la ciudad, Eric Adams, quien optó por no participar en las primaras, ya que está manchado por su subordinación a Donald Trump cuando el nuevo presidente le obsequió anular el proceso judicial criminal contra el alcalde por corrupción. Más aún, se puede esperar que el poderoso elenco que apoyó a Cuomo –incluyendo a demócratas– podrían dedicarse a frenar el triunfo del joven demócrata en noviembre. Por ahora, Mamdani es el candidato más favorecido para ganar en noviembre, sobre todo si logra mantener la dinámica de su campaña y seguir convenciendo a las bases, ante todo los jóvenes, de que vale la pena participar para impulsar una nueva agenda progresista para esta metrópolis. Además, será igual de importante el efecto que
Pero otros insisten en que este triunfo tiene enormes implicaciones nacionales. Muchos coinciden con la afirmación del analista Eric Blanc: “Los multimillonarios intentaron comprar esta elección y perdieron feo. Resulta que la oligarquía no es invencible”.
O en otra opinión: “Organizar es todo. No fue una campaña de una estrella política. Es una estrella que hizo campaña sobre un esfuerzo gigantesco de organización”, del analista Anand Giridharadas, quien sugiere que en lugar de asustarse por algo nuevo, los demócratas tienen que aprender que su futuro está en manos de una nueva generación progresista.
El senador Sanders comentó que “la victoria de Zohran me comprueba que cuando la gente puede votar a favor de algo en lugar de sólo en contra, cuando damos prioridad a la organización y la movilización, nuestra agenda progresista puede ganar aun ante las posibilidades más remotas”.
Puede ganar la agenda social pese a remotas posibilidades: Bernie Sanders
Pese al dictamen, el salvadoreño permanecerá en la cárcel debido al temor de que sea detenido por agentes del ICE
y Control de Aduanas (ICE, por sus siglas en inglés) lo deporten cuando sea liberado.
Una jueza de Tenesi dictaminó ayer que Kilmar Ábrego García, el migrante deportado por error a El Salvador por el gobierno de Donald Trump, tiene derecho a ser puesto en libertad, e incluso estableció condiciones específicas para ello, aunque permanecerá por ahora en la cárcel ante el temor de que los agentes del Servicio de Inmigración
La magistrada Barbara Holmes dictaminó el domingo pasado en la sala del tribunal de Nashville que el gobierno no podía seguir deteniendo a Ábrego, de 29 años, a la espera de juicio porque lo acusan de conspirar con al menos otros cinco integrantes de una red de contrabando para introducir inmigrantes indocumentados en Estados Unidos.
ALDO ANFOSSI
CORRESPONSAL
SANTIAGO
El gobierno y la clase política chilena parecían haber quedado en estado de shock, luego de que se confirmó el arresto de seis suboficiales del ejército pertenecientes a una unidad a cargo de la seguridad fronteriza con Bolivia, acusados de ser integrantes de una organización criminal dedicada a la internación de drogas al país.
Tanto así, que el ministro de Seguridad Pública, Luis Cordero, admitió que lo sucedido “puede comprometer a la seguridad pública en Chile”, al poner de manifiesto “la penetración de una organización criminal en una entidad armada.
“Es el hecho más grave del que hemos tenido registro en el último tiempo”, reconoció el funcionario sin ambages, porque “cuando se compromete a una institución armada en materia de narcotráfico y no la detienes oportunamente, los hechos son irreversibles para el país”.
Además de desarticular la organización, lo relevante, enfatizó, es establecer “desde cuándo operaba, quién era su contacto en el origen y el destino.
“Es un asunto serio para la seguridad pública, pero también para la seguridad del país”, recalcó.
Los militares, ahora dados de baja, estaban asignados a la segunda Brigada Acorazada Cazadores, en Pozo Almonte, y al Centro Clínico Militar de Iquique, ciudades de la región de Tarapacá, ubicada mil 700 kilómetros al norte de la capital Santiago.
Formaban parte de una banda “estructurada para internar, ocultar y trasladar sustancias ilícitas hacia la Región Metropolitana”, informó el Ministerio Público. Se les decomisaron 200 kilogramos de cocaína y pasta base al momento de ser detenidos.
Cordero consideró especialmente grave que el grupo cumpliera “el rol central” de transportar estupefacientes desde el norte del país hasta la capital, aportando logística y medidas de seguridad, porque “el acceso de estas organizaciones a militares facilita el traslado y amplifica el impacto de sus operaciones.
“Toda la evidencia demuestra que cuando las organizaciones criminales y el narcotráfico tienen esa capacidad de penetrar en una institución armada, jerarquizada como una entidad de la fuerza armada, lo tenemos que erradicar de raíz”.
Desarticulan célula local del Tren de Aragua
Aunado a lo anterior, el Ministerio Público dio cuenta el martes pasado de que fue desbaratada una célula local vinculada al cartel venezolano Tren de Aragua, con la detención de 52 personas, de las cuales 45 son extranjeros, 29 de ellos con situación migratoria al día y 16 en estatus irregular.
Los detenidos, mediante actividades comerciales que les facilitaron abrir cuentas corrientes en el sistema financiero, consiguieron lavar 13.5 millones de dólares, provenientes de secuestros y otros delitos, los cuales sacaron del país mediante transferencias bancarias a Colombia, Venezuela, España, México, Paraguay, Argentina y EU.
medida, con el argumento de que podría enfrentarse a la persecución de las bandas en su país de origen.
A su vez, Alejandro Barranco, hijo de Narciso Barranco, migrante detenido y golpeado con brutalidad por las autoridades, declaró al diario Los Angeles Times que a su padre lo detuvieron por su color de piel, “lo rociaron con gas pimienta y le dislocaron el hombro”.
Además, reveló que pasó más de 24 horas sin recibir atención médica, sin comida y sin agua en un centro de detención de Los Ángeles.
El caso del salvadoreño residente de Maryland que se declaró inocente se ha convertido en un emblema de la agresiva política de inmigración del presidente republicano y del rechazo de los grupos de defensa de los derechos humanos.
Sus abogados calificaron los cargos como un esfuerzo del gobierno para justificar su violación de los derechos de Ábrego al deportarlo a El Salvador a pesar de una orden judicial de 2019 que prohíbe tal
Según datos analizados por Los Angeles Times, la mayoría de los arrestados durante las redadas contra inmigrantes indocumentados en el estado no son delincuentes convictos.
El rotativo indicó que la mayoría eran hombres detenidos en la calle, sin antecedentes penales. Por otra parte, una corte ordenó a las autoridades de Costa Rica liberar a los migrantes extranjeros que encerró en un refugio tras ser “deportados” por la administración del presidente Trump, según la resolución que se emitió antes de la
visita a dicho país de la secretaria de Seguridad Interior estadunidense, Kristi Noem, quien ofreció asistencia para controlar a los viajeros y mercancías.
“Va a ser el primer país, me parece, en el mundo que va a estar escaneando a toda persona o producto completamente cuando entra a Estados Unidos”, señaló Noem. La secretaria se reunió con el presidente costarricense, Rodrigo Chaves, en la segunda escala de una gira centroamericana iniciada en Panamá.
Su caso es un emblema de la agresiva política antinmigrante de Donald Trump

▲ Dieciséis personas murieron y 400 resultaron heridas en Kenia tras los enfrentamientos en la capital Nairobi que conmemoraron las protestas de 2024, informaron organizaciones de defensa de los derechos humanos. El año pasado,
protestaron contra el aumento de impuestos decretado por el presidente William Ruto. La manifestación fue reprimida y terminó con 60 muertos. Ayer, nuevamente los ciudadanos fueron golpeados. Información y foto Afp
AFP PANAMÁ
El presidente de Panamá, José Raúl Mulino, extendió hasta el domingo la prohibición para reunirse en la provincia de Bocas del Toro, pese al cese de las protestas que causaron pérdidas millonarias por saqueos y bloqueos de carreteras. El viernes pasado, Mulino suspendió por cinco días varios derechos constitucionales en esta zona, fronteriza con Costa Rica, por dis-
turbios y enfrentamientos entre manifestantes y policías. De acuerdo con el gobierno panameño, ya no hay disturbios ni enfrentamientos entre manifestantes y policías; sin embargo, “continúan los bloqueos (de rutas) en algunas regiones”, indicó el ministro de seguridad, Frank Ábrego.
La ONG Aldeas Infantiles SOS denunció que “una niña de un año y 8 meses” falleció “como consecuencia de los gases lacrimógenos lanzados dentro de su vivienda (por la policía) durante las violen-
tas represiones registradas tras las manifestaciones”, las cuales se realizan desde abril en rechazo a una reforma de pensiones. El organismo añadió que los hechos ocurrieron en la localidad de Pueblo Nuevo, sin especificar el día, y anunció que presentaría una denuncia para que “este homicidio no quede impune”. El director de la Policía, Jaime Fernández, negó que hubiera una denuncia formal sobre esta muerte y acusó a la ONG de relatar el caso “de una forma anticipada y sin la evidencia”.
CARLOS GARCÍA
CORRESPONSAL
IRAPUATO, GTO.
Once personas murieron y 20 resultaron heridas durante un ataque perpetrado por un grupo de hombres armados durante una fiesta con motivo del Día de San Juan, en el municipio de Irapuato, informó la Fiscalía General del Estado (FGE).
El atentado fue cometido ayer casi a la medianoche en la calle Bustamante, colonia Barrio Nuevo, cuando los asistentes disfrutaban la celebración y un baile; según testigos, en ese momento irrumpieron los pistoleros y abrieron fuego.
La FGE precisó que entre los fallecidos hay ocho hombres, dos mujeres y un adolescente de 17 años. Tres de los 20 lesionados tienen 16, 14 y 11 años; varios de ellos fueron trasladados a hospitales de la ciudad por familiares y amigos.
Libia García Muñoz Ledo, gobernadora de Guanajuato –uno de las estados más violentos de la época actual–, condenó el crimen múltiple y expresó su solidaridad con las familias de las víctimas. Afirmó que en el rubro de seguridad trabaja en coordinación con el gobierno federal.
Ayer en la mañana, la mandataria panista escribió en su cuenta de X que desde “el primer momento en que se conoció del crimen las autoridades estatales colaboran con el municipio para detener a los responsables y garantizar justicia.
“En Guanajuato, municipios, estado y Federación seguimos trabajando en la construcción de la paz”, puntualizó.
La FGE refirió, en tanto, que personal ministerial y pericial se desplazó al lugar del atentado para llevar a cabo el procesamiento, preservar indicios relevantes y recabar información que permita reconstruir la mecánica del crimen y reconocer a los responsables.

“El Ministerio Público trabaja en la identificación de todas las víctimas y no descarta que existan más personas lesionadas porque algunos fueron llevados por particulares a hospitales de la ciudad.”
Prometió que no dejará impune el crimen y también condenó “enérgicamente el asesinato de los 11 personas” y las lesiones que sufrieron otras 20.
La Secretaría de Seguridad municipal dio a conocer que en la zona se aplicó un operativo para arrestar a los multihomicidas, y en la movilización participaron la policía local, la Guardia Nacional, el Ejército y las Fuerzas de Seguridad Pública del Estado (FSPE). “A través del Centro de Atención
Integral a Víctimas brindamos atención sicológica, asesoría jurídica y acompañamiento a las víctimas para interponer la denuncia ante las autoridades correspondientes”, di-
fundió la corporación de Irapuato. Agregó que el multihomicidio genera incertidumbre entre la población, pero “no daremos paso atrás en la misión de recuperar la paz de nuestra ciudad. El gobierno municipal lamenta y condena la agresión y se solidariza con las víctimas, familiares y ciudadanía afectada por este cobarde acto”.
Guanajuato, escenario de masacres
El primero de julio de 2020 fue perpetrada una masacre sin precedente en el estado. En un anexo irregular de la comunidad de Arandas, municipio de Irapuato, 28 internos fueron ejecutados. Los sicarios pertenecían al cártel Santa Rosa de Lima (CSRL). En la llamada zona Laja-Bajío, los grupos criminales CSRL y cártel Jalisco Nueva Generación (CJNG)
▲ Un vecino de Barrio Nuevo, municipio de Irapuato, Guanajuato, limpia un área de la calle Bustamante, donde ayer se cometió un multihomicidio. Atrás de él, una pared con impactos de arma de fuego. Foto Afp
están en guerra por el control de la región que incluye Apaseo el Grande, Apaseo el Alto, Celaya, Cortázar, Comonfort, Santa Cruz de Juventino Rosas, Jaral del Progreso, Tarimoro y Villagrán; la lucha se extiende a los municipios de Salamanca e Irapuato, han dicho autoridades. La madrugada del 19 de mayo pasado, un grupo armado ejecutó a siete jóvenes de la comunidad de San Bartolo de Berrios, municipio de San Felipe. Dos meses antes (17 de mayo), ocho jóvenes fueron ultimados en la comunidad de San José de Mendoza, en Salamanca.
Sheinbaum lamenta la matanza; “ya se investiga”
En su conferencia matutina de ayer, la presidenta Claudia Sheinbaum informó sobre el ataque armado cometido en Irapuato, Guanajuato, que dejó 11 personas asesinadas, entre ellas un menor, y 20 heridas. “Es muy lamentable lo que ocurrió. Se está haciendo la investigación” y en su momento informará el gabinete de seguridad, dijo. La mandataria señaló que se va a seguir trabajando ahí en conjunto con la gobernadora Libia García Muñoz Ledo, “hasta donde se puede trabajar conjuntamente y también las fuerzas federales se encuentran haciendo su trabajo”.
Por otro lado, Sheinbaum comentó que los gobiernos estatales suelen integrar cuerpos policiacos especiales que les permiten actuar, incluso contra acciones de la delincuencia organizada. En el caso de Chiapas, ayudaron a varios filtros que había de delincuencia organizada que ya fueron abiertos, pero “Guanajuato es otra cosa. Hay una historia ahí de la policía de Guanajuato”, dijo la Presidenta. Hay que tener cuidado también con este tipo de cuerpos, en las policías, porque no pueden sobrepasar las atribuciones que tienen.
Alonso Urrutia y Alma Muñoz.
DE LA REDACCIÓN
La captura ayer de Cirilo Sepúlveda Arellano, alias El Capi, por fuerzas federales y estatales en Michoacán, provocó una reacción en grupos criminales que bloquearon la carretera Apatzingán-Buenavista-Aguililla y quemaron vehículos. Según fuentes policiacas, el operativo fue desplegado por elementos del Ejército, Guardia Nacional y Fiscalía General de la República (FGR), en el municipio de Buenavista, colindante con Apatzingán. El Capi es hermano de César Sepúlveda Arellano, El Botox, líder
del grupo delictivo autodenominado Los blancos de Troya, , uno de los aliados del cártel Jalisco Nueva Generación (CJNG) en esa entidad. En respuesta a la operación militar y policiaca, integrantes de Los blancos de Troya, apoyados por Los Viagras, realizaron al menos tres narcobloqueos en la carretera Apatzingán-Buenavista-Aguililla, donde una camioneta y un camión de carga fueron incendiados. Junto con Cirilo Sepúlveda fue arrestado su yerno, Servando G, con quien presuntamente se encargaba de “cobrar cuotas” a comerciantes, transportistas, tortilleros, carniceros, empresarios y produc-
tores de limón.
César Sepúlveda es identificado como un ex autodefensa y el principal aliado de Nicolás Sierra Santana, El Gordo, cabecilla de Los Viagras, por quienes la Fiscalía General del Estado ofrece recompensas de 100 mil pesos, al ser considerados autores intelectuales del asesinato de Hipólito Mora Chávez, en junio de 2023, fundador de los grupos de autodefensa.
El pasado 25 de febrero fuerzas federales y estatales aprehendieron a Gerardo Valencia y a Joana Lizbeth S, yerno e hija de El Botox. Ambos son acusados de torturar y asesinar a un comandante y a un
agente investigador de la subdelegación de la FGR en Apatzingán. El Botox ya había sido detenido en Morelos en 2018 por el delito de secuestro; después de 20 meses en prisión salió libre.
Un hijo de dicho sujeto, identificado como César Alejandro Sepúlveda Valencia, fue arrestado en octubre de 2024, en poder de rifles de asalto.
Durante el operativo para capturar a El Capi hubo presencia de patrullas militares y de la policía estatal, así como un helicóptero que sobrevoló la zona cercana a Apatzingán y Buenavista Tomatlán. También en Buenavista Toma-
tlán, un policía municipal falleció y otros dos resultaron lesionados tras ser atacados antenoche por un grupo armado cuando se encontraban en la caseta de seguridad ubicada a la entrada de esa población de Tierra Caliente, informaron fuentes policiacas. En Tabasco, la fiscalía estatal informó que investiga el ataque armado, el martes en la tarde, contra tres personas en una vulcanizadora en el municipio de Tenosique, con resultado de dos muertos y un herido, a quien identificaron como hijo del ex alcalde Fernando Peralta. Con información de Ernesto Martínez y René Alberto López, corresponsales
Prepara el ayuntamiento partida especial en apoyo a los damnificados
DE LOS CORRESPONSALES
Al menos 200 casas resultaron afectadas por las inundaciones que la intensa y prolongada lluvia de ayer provocó en el área metropolitana de Guadalajara, Jalisco, según datos preliminares. Ayer las autoridades continuaban con el recuento de daños.
El gobierno de Zapopan informó ayer en la tarde que en 66 viviendas ingresó agua y dañó menaje en las colonias Cantaluna, El Briseño, Villas Perisur, El Mante y Los Periodistas, por lo cual el ayuntamiento prepara una partida especial para apoyo a los damnificados.
En Tlaquepaque una treintena de inmuebles de la colonia El Mante resultaron perjudicados tras el desborde del arroyo El Seco; todo el sur de esta demarcación tuvo afectaciones.
En Guadalajara las anegaciones dejaron poco más de 30 vehículos varados en avenida Colón, lo que obligó a muchos de sus ocupantes a salir y pararse sobre los toldos para esperar a que bajara el nivel de agua. Tlajomulco, otro de los municipios con severos estragos, no ha dado a conocer un balance de los mismos, pero se estima que decenas de casas sufrieron el embate de la lluvias.
Las precipitaciones se extendieron a casi todo el estado, por lo que se reportaron también desbordes de arroyos en distintos puntos, uno de ellos en Acatic, donde 14 viviendas quedaron anegadas.
La Comisión Estatal de Derechos Humanos emitió una medida cautelar dirigida al Sistema Intermunicipal de los Servicios de Agua Potable y Alcantarillado solicitando la implementación de acciones urgentes para mitigar las inundaciones en la zona conurbada de Guadalajara.

Chihuahua: falleció hombre arrastrado por la corriente
En Chihuahua, el cuerpo de Abel M R, trabajador de la zona minera y conductor de un tractocamión, fue hallado en un camino de terracería que conecta las instalaciones del yacimiento La Morita y el ejido Niños Héroes, municipio de Ascención; su vehículo fue arrastrado por la corriente de un arroyo que se desbordó por las lluvias, informó este miércoles la Agencia Estatal de Investigación.
Protección Civil de Ciudad Juárez dio a conocer que 10 viviendas y 15 vehículos quedaron dañados en las colonias La Montada, Fronteriza Baja y Felipe Ángeles, por la crecida del arroyo Las Víboras a consecuencia de una precipitación torrencial la madrugada de este miércoles.
Sergio Rodríguez, director de Protección Civil municipal, refirió que el agua en los inmuebles llegó al metro y medio de altura, además de que algunos de los automotores fueron pérdida total.
En Ocampo, 151 familias pierden todo su patrimonio
En Guanajuato, a causa de las anegaciones por las lluvias en la comunidad de San Pedro de Ibarra, municipio de Ocampo, 151 familias perdieron todo su patrimonio, informó el secretario de Gobierno estatal, Jorge Jiménez Lona, quien aseguró que hay un fondo de 10 millones de pesos para atender a los damnificados.
Por otra parte, un aguacero el miércoles en la tarde dejó afectaciones en la parte baja de Chimalhuacán, estado de México, principalmente en la avenida de El Peñón. Una de las colonias con mayores anegaciones fue Tlatel Xochitenco, donde el agua ingresó a las viviendas.
En Querétaro, el gobernador Mauricio Kuri González indicó que unos 9 mil metros cúbicos de tierra y rocas mantienen bloqueada desde el pasado lunes la circulación en la carretera estatal 100, en inmediaciones del poblado San Antonio de la Cal, municipio de Tolimán.
▲ Perjuicios en una vivienda de la colonia El Briseño, municipio de Zapopan, Jalisco, tras una inundación por la crecida del arroyo El Seco. Foto Arturo Campos Cedillo
Por la magnitud del derrumbe, ocasionado por el resblandecimiento de la tierra, los trabajos para liberar la vía concluirán el próximo viernes “siempre y cuando las condiciones climatológicas sean favorables”, subrayó el mandatario panista. El Servicio Meteorológico Nacional prevé para hoy lluvias puntuales intensas en regiones de Chihuahua (oeste y suroeste), Veracruz (sur), Oaxaca (norte y noreste), Chiapas (noroeste, sur y este) y Tabasco (oestey suroeste); muy fuertes en zonas de Sonora, Durango, Sinaloa, Nayarit y Jalisco.
Juan Carlos G. Partida, Jesús Estrada, Rubén Villalpando, Carlos García y René Ramón
JORGE A. PÉREZ ALFONSO CORRESPONSAL OAXACA, OAX.
El gobierno del estado solicitará la declaratoria de desastre para 55 municipios de las regiones de la Costa, i´stmo de Tehuantepec, Sierra Sur, Cuenca del Papaloapan, Sierra Juárez y la Sierra de Flores Magón, por los daños que causó el huracán Erick
En un comunicado, la administración estatal explicó que la petición será entregada al gobierno federal, mismo que revisará y certificará los datos aportados para tomar una decisión al respecto. Indicó que se estima que resultaron afectadas más de 20 mil personas en toda la entidad por el impacto del meteoro el 19 de junio y las fuertes lluvias que provocó en todo el estado.
Asimismo, informó que a través el plan DN-III-E se han otorgado 200 consultas médicas, 50 apoyos a comunidades, mil 201 despensas, 12 mil 980 raciones de comida y 8 mil 20 litros de agua con planta potabilizadora.
Además suman 30 caminos despejados, 124 árboles removidos y mil 200 metros cuadrados de basura y escombro retirados. Mientras, la Secretaría de Marina ha entregado 4 mil despensas, más de 26 mil litros de agua, auxilió a 36 personas, dio 96 atenciones médicas, apoyó en nueve comunidades, despejó 45 vías, removió 114 árboles, así como 106 toneladas de escombro y basura.
La Secretaría de Seguridad y Protección Ciudadana dio a conocer que las comunidades perjudicadas por Erick en Guerrero y Oaxaca “avanzan paulatinamente hacia el restablecimiento de sus actividades cotidianas”.
Añadió que más de 26 mil integrantes de las fuerzas armadas continúan con acciones de rehabilitación de tramos carreteros, reparación de escuelas y apoyo a las familias afectadas.
Con información de Gustavo Castillo
No hay fecha para reabrir carretera cubierta con espuma tóxica en Hidalgo
RICARDO MONTOYA CORRESPONSAL ALFAJAYUCAN, HGO.
Julio Agustín Cruz Tovar, alcalde de Alfajayucan, dijo que no hay fecha para que se reabra la circulación de la carretera que comunica esa localidad con la cabecera de Chilcuautla toda vez que fue insuficiente la labor que bomberos, elementos de Protección Civil y voluntarios reali-
zaron para retirar la espuma tóxica y pestilente que desdeel lunes en la madrugada cubrió un tramo de 100 metros de la vía que se ubica en inmediaciones de la comunidad La Cañada.
“Es demasiada la espuma proveniente de un canal de aguas negras que conecta con la presa Javier Rojo Gómez, abarca una superficie de 50 metros de ancho y cuando hay viento se dispersa en el camino”, explicó en conferencia.
Aunque ayer en la tarde el área de prensa del ayuntamiento de Alfajayucan informó que ya habían comenzado las labores para limpiar la carretera, Cruz Tovar afirmó que el lunes se realizaron diversas maniobras para tratar de quitar la espuma.
“El gobierno municipal intentó retirarla; estuvimos hasta muy tarde con el camión de bomberos, con una pipa, pero cuando ya estábamos llegando a la orilla el viento
volvió a impulsar la espuma hacia la vía”, explicó. Reportó que el embalse Javier Rojo Gómez se encuentra a 98 por ciento de su capacidad de almacenamiento ya que recibe grandes volúmenes de agua residual proveniente del valle de México a través de las presas Endhó y Requena. Debido a esta situación el embalse debe drenar o dar salida a 20 metros cúbicos por segundo del líquido, a través de un extenso canal
cuya corriente circula a alta velocidad, lo que es un factor para que se produzcan grandes cantidades de espuma que los vientos impulsan hasta la carretera. Cruz Tovar comentó que mientras la presa siga drenando agua continuará la generación de espuma, por lo que será necesario esperar a que bajen los volúmenes del líquido. Mencionó que el embalse presenta una fractura en las compuertas.

Reprueban eventuales reformas contra “excesos” de la libertad de expresión
LORENZO CHIM
CORRESPONSAL
CAMPECHE, CAMP.
Periodistas de Campeche marcharon y realizaron plantones frente a las sedes del palacio de gobierno y el Congreso del estado para demandar un alto a la censura.
Los inconformes lamentaron el anuncio de diputados locales morenistas sobre reformar las leyes para sancionar con mayor rigor los “excesos” de la libertad de expresión. Encabezados por el ex director del diario Tribuna, Jorge Luis González Valdez –vinculado a proceso por los presuntos delitos de incitación al odio, a la violencia, difamación y calumnias contra la gobernadora Layda Sansores– caminaron
del parque principal rumbo al palacio de gobierno.
Denunciaron la intención gubernamental de callar las voces críticas no sólo de la prensa libre, sino de la sociedad en general y se sumaron a la manifestación que periodistas agremiados a la agrupación Reporteros 2025 efectuaron en el Senado de la República para exigir un alto a la censura a los medios de comunicación y garantías para el libre ejercicio de su labor.
Los quejosos también se apostaron en la sede del Congreso local, donde leyeron el “Manifiesto por la libertad de expresión y el libre ejercicio del periodismo”, presentado por reporteros en el Senado.
Ahí, reprobaron las pretensiones de diputados locales morenistas de reformar las leyes a fin de sancionar
▲ Comunicadores se manifestaron ayer frente al Congreso de Campeche para exigir a las autoridades locales garantizar el libre ejercicio de su labor. Foto Lorenzo Chim
con mayor rigor a quienes incurran en “libertad de agresión”.
Lo anterior, luego de que la legisladora de Morena Gladys Rivera López anunció en la tribuna que denunciará penalmente al periodista Yair Rodríguez por supuestamente haberla ofendido con sus publicaciones.
Durante su discurso se subieron junto con ella al podio los diputados de su bancada así como de los Partidos del Trabajo y del Verde Ecologista de México.
El morenista José Antonio Jiménez Gutiérrez, líder del Congreso estatal, aseguró que reformarán el marco jurídico para frenar los ataques contra servidores públicos.
Morelos: perito de la fiscalía denuncia que lo presionaron para perjudicar a El Cuau
RUBICELA MORELOS CRUZ
CORRESPONSAL
CUERNAVACA, MOR.
Elliot Gabriel Rivera Hernández, perito desde hace 14 años en el área de Sicología de la Fiscalía General del Estado (FGE) de Morelos denunció que fue víctima de amenazas, acoso y discriminación en la pasada administración encabezada por Uriel Carmona Gándara, para que elaborara un dictamen sicológico a modo y perjudicar a Cuauhtémoc Blanco Bravo, quien gobernó la entidad de 2018 a 2024.
El caso en el que según el perito se le ordenó dictaminar daño sicológico a una mujer identificada con las iniciales NFB, data de 2024, y fue por conducto del entonces fiscal metropolitano Jorge Wences Aguirre, a fin de “darle un sustito” a Blanco Bravo, actualmente diputado federal por Morena. Las iniciales NFB corresponden a la media hermana de Blanco, quien en 2024 lo denunció de intento de abuso sexual, y por el cual Uriel Carmona solicitó en febrero pasado su desafuero ante el Congreso de la Unión, mismo que fue desechado y calificado de improcedente.
JUAN CARLOS G. PARTIDA
CORRESPONSAL
GUADALAJARA, JAL.
El Hospital Civil de Guadalajara (HCG) y el Sistema DIF municipal sufrieron hackeo en su base de datos por un presunto ciberdelincuente que se hace llamar Kazu, quien por 250 dólares puso a la venta información sensible de ambas instituciones que incluye a pacientes y a menores, informaron las dos dependencias, las cuales presentaron denuncias ante la Fiscalía del estado y anunciaron un reforzamiento de protección en sus sistemas de seguridad digital.
Esta semana en un foro de hackers, un usuario que se identifica como Kazu, puso a la venta 7.6 gigabytes con información del HCG por dicha cantidad, donde afirmó que contenía al menos 63 mil archivos que incluyen datos personales y clínicos de pacientes, fotografías, teléfonos y direcciones, programas académicos, investigaciones e información de transparencia.
Ayer en la mañana, a través de un comunicado, el DIF de la capital jalisciense reconoció que existió una “posible vulneración” y presentó denuncia formal para que la fiscalía realice la investigación pertinente, en tanto activaron protocolos internos de revisión y se auditan los sistemas de seguridad informática. La alcaldesa Verónica Delgadillo también reconoció el robo y la denuncia presentada; pero no quiso precisar si entre lo hurtado y puesto a la venta por los hackers estaban datos e identificaciones de los niños nacidos entre 2017 y 2022 registrados ante el DIF y, en la gran mayoría de los casos, debido a algún tipo de vulnerabilidad. La rectora de la Universidad de Guadalajara, Karla Planter, también reconoció lo ocurrido en el sistema informático del Hospital Civil y dijo que se interpuso la denuncia correspondiente; el HCG, además de brindar servicio a la población sin seguridad social, también sirve también como hospital escuela para la facultad de medicina de la Universidad de Guadalajara.
Funcionarios de Puebla no podrán buscar sanción si los critican en redes: Armenta
YADIRA LLAVEN LA JORNADA DE ORIENTE PUEBLA, PUE.
El gobernador Alejandro Armenta Mier dio a conocer que los servidores públicos en Puebla quedarán exentos del beneficio de la Ley de ciberasedio; es decir, no podrán buscar la sanción o penalización por críticas en su contra en redes sociales. En entrevista colectiva, el mandatario estatal refirió que es totalmente respetuoso del ejercicio del periodismo y de la libertad de expresión, por lo que detrás del artículo 480 del Código Penal del estado no hay ningún interés de censura.
Rivera Hernández afirmó lo anterior en un video que difundió en redes sociales debido a que, aunque presentó una denuncia y la amplió en mayo pasado, a la fecha no hay avances. Al contrario, la FGE, que preside Edgar Maldonado Ceballos –ex consejero jurídico de la gobernadora Margarita González–, ha empezado a hostigarlo laboralmente, pues siguen en funciones en la FGE algunos mandos y funcionarios que trabajaron en la pasada administración, cercanos a Carmona Gándara, como el coordinador general de Servicios Periciales, Samuel Nava.
“Ustedes conocen la fábrica de mentiras y nosotros somos totalmente respetuosos y tomamos muy en cuenta lo que dijo la presidenta (Claudia Shienbuam): deben quedar exentos del beneficio de esta ley los servidores públicos; no tenemos ningún interés, no hay censura”, declaró.
Explicó que la Constitución Mexicana consagra por encima de leyes locales las libertades de asociación, tránsito y organización, por lo que recalcó que no hay razón por la cual se deba vincular la Ley de ciberasedio con limitaciones a la libertad de expresión.
Argumentó que la intención de la reforma es atender delitos como ciberataques a empresas y el robo
de identidad, que calificó de algo “delicado”, porque no sólo puede afectar las finanzas de un inversionista, sino vincularlo a delitos como el lavado de dinero. En el caso de las niñas, niños y adolescentes, detalló, los protege del bullying y el acoso, de los ataques en redes sociales que denigran, ofenden, señalan y pueden llevar a menores a pensar en el suicidio.
“Hoy cuántos millones de mensajes recibe un niño que tiene sobrepeso y alguna otra condición, en las redes sociales. Todo eso lastima, las conductas suicidas desde la niñez se dan en gran medida, según los científicos, sicólogos y siquiatras, por esa repetición de imágenes o de señalamientos que afectan su mente y su estado anímico”, comentó.
Por lo tanto, destacó que era necesario legislar en la materia y se respaldará al gobierno federal en la estrategia contra los ciberdelincuentes que atentan contra los derechos humanos.
Armenta Mier consideró que el resultado de los foros y las reuniones que el Congreso del estado lleva a cabo sobre el tema, permitirá que se exente a los servidores públicos de la Ley de ciberasedio. “La presidenta dio a los legisladores una opción importante, estoy seguro lo van a considerar, pero que nadie se ponga el saco, hablamos de ciberdelincuentes no de medios de comunicación”, afirmó.
USUARIOS SUFRIERON PARA ABORDAR TRANSPORTE HACIA EL EDOMEX
La lluvia duró más de tres horas y provocó 43 grandes encharcamientos

▲ Durante dos horas usuarios padecieron el viacrucis de buscar un transporte que los llevara al oriente de la
Caos, aglomeraciones y empujones sufrieron cientos de personas para abordar un transporte alterno sobre la calzada Ignacio Zaragoza por la suspensión de dos horas en el servicio de la línea A del Metro, entre la estación Guelatao y La Paz, en el estado de México, por las inundaciones en la zona de vías tras la fuerte lluvia de ayer por la tarde. Minutos después de las 19 horas, cientos de usuarios se quedaron varados en los pasillos y puentes de acceso de la estación Guelatao, que se convirtió en terminal provisio-

ciudad y el estado de México, luego de que a las 7 de la noche fueron cerradas las estaciones de la línea de
nal porque el agua ya no permitió el avance de los trenes hacia territorio mexiquense, mientras el servicio fue lento en el resto de la ruta por la lluvia que no dio tregua. A las 20 horas se activó el servicio de apoyo de autobuses de la Red de Transporte de Pasajeros y de patrullas de la Secretaría de Seguridad Ciudadana (SSC) que llegaron hasta esa parte, conocida como Cabeza de Juárez, para trasladar a los varados; sin embargo, las unidades resultaron insuficientes.
Personas viajaron colgadas en los autobuses que arrancaban rumbo a La Paz sin que cerraran las puertas, usuarios se empujaron para subir y
alcanzar un lugar; otros portaban paraguas, impermeables o quedaron totalmente mojados por la pertinaz lluvia de más de tres horas.
En redes sociales, el Metro informó de la suspensión “debido a la intensa lluvia en la zona y a la acumulación e ingreso de agua del exterior”, que se solucionó alrededor de las 21 horas luego de bombearla, por lo que se reanudó el servicio.
En el corte de las 22 horas, las autoridades reportaron 43 encharcamientos en las alcaldías Tláhuac, Iztapalapa, Iztacalco, Benito Juárez, Xochimilco, Álvaro Obregón y Venustiano Carranza, 23 de los cuales fueron atendidos en su totalidad.
Agregó que fueron controlados los niveles de desfogue pluvial por medio del drenaje profundo, a pesar de que a las 21 horas el volumen de lluvia en la ciudad era de 16.1 millones de metros cúbicos.
El nivel máximo fue de 40.5 milímetros en la estación Presa Mixcoac, en Álvaro Obregón, mientras la SSC informó de encharcamientos en Eje 5 Sur y Tlalpan, por lo que policías empujaron autos atorados.
Un total de 150 efectivos, entre policías de tránsito, trabajadores en cuadrillas para la atención al drenaje, así como personal técnico y operativo y 68 vehículos –camiones hidroneumáticos, unidades de tránsito
y equipos de bombeo de emergencia Hércules– ,fueron movilizados. Al cierre de la edición, la Secretaría de Gestión Integral de Riesgos y Protección Civil mantuvo la alerta roja por lluvias fuertes de entre 50 y 70 milímetros en las alcaldías Álvaro Obregón, Iztapalapa, Tláhuac, Tlalpan y Xochimilco. Asimismo, actualizó la alerta naranja por precipitaciones de 30 y 49 milímetros para Benito Juárez, Gustavo A. Madero, Iztacalco, Milpa Alta y Venustiano Carranza, y amarilla por otras de 15 y 29 milímetros para Azcapotzalco, Coyoacán, Cuauhtémoc, Cuajimalpa, La Magdalena Contreras y Miguel Hidalgo.

En laderas que alcanzan hasta 40 metros de caída, cientos de familias levantaron sus viviendas a pesar del riesgo que representa habitar la zona, sobre todo en la temporada de lluvias, cuando andar por los estrechos y frágiles caminos se vuelve muy riesgoso.
Colonias como El Pirú, Calzada Jalalpa, Jalalpa Tepito, Lomas de Becerra, El Pocito y La Joya –en la alcaldía Álvaro Obregón– comenzaron a transformar las barrancas desde los años 70 del siglo pasado, ante la llegada de migrantes del estado de México y Michoacán que, sin grandes ingresos, adquirieron esos terrenos a bajo costo.
Carmen de Jesús, de la colonia El Pocito, relata que su familia campesina se instaló aquí hace décadas y por años enfrentaron dificultades para acceder al agua potable, electricidad y drenaje.
Sin embargo, su situación ha empeorado, pues esas colonias sufren por las condiciones insalubres, ya que las personas utilizan los taludes como tiraderos de basura y desde 1988 la red de drenaje desemboca en las 13 barrancas de la alcaldía.
Durante un recorrido, se constató que hay casas a punto de caer, están en mal estado vialidades y puentes, los callejones son muy angostos, el asfalto está dañado y las pendientes pronunciadas complican el acceso de unidades del transporte público.
Gerardo Rodríguez, presidente de la ruta 46, que va de Jalalpa Las Torres al mercado Tacubaya Becerra, dijo que la altura y falta de mantenimiento causan que los autobuses se descompongan seguido, y “en época de lluvia es difícil y peligroso manejar porque la poca visibilidad, hay exceso de pasajeros y hacemos
recorridos de más de una hora”. Por su parte, Francisco Velázquez, un chofer, expresó que la calzada Jalalpa es conocida como la tripa, por ser una vía estrecha y con muchas curvas.
El diputado local de Morena Fernando Zárate explicó que en la temporada de lluvias la tierra se reblandece por la constante caída de agua proveniente del cauce, lo que incrementa el peligro de deslaves, como ha sucedido en años anteriores. Aseguró que este 2025 el gobierno de la ciudad destinó 5 millones de pesos para realizar obras de mitigación en esa área, mientras la Secretaría de Gestión Integral del Agua ha colocado costaleras a fin de contener el terreno y evitar que presas como la de San Francisco, conocida como Becerra, se desborde y cause mayores afectaciones.




















































































MÁQUINA PERFORA TUBERÍA
Trabajadores atendían derrame de agua potable en una línea de 20 pulgadas, que no pudo ser reparada

ELBA MÓNICA BRAVO Y KEVIN RUIZ
Una retroexcavadora que pretendía arreglar la línea de agua potable de 20 pulgadas en la calle Correspondencia esquina Castilla, colonia Álamos, en la alcaldía Benito Juárez, ocasionó una explosión al dañar la tubería de gas natural, sin que resultaran personas intoxicadas ni lesionadas, informaron autoridades capitalinas.
Alrededor de las 15:40 se registró la intensa movilización de bomberos, personal de la Secretaría de Gestión Integral de Riesgos y Protección Civil y efectivos de la Secretaría de Seguridad Ciudadana por el siniestro.
Ante esa situación, se activaron los protocolos de emergencia para que al menos 200 residentes de la zona fueran evacuados, así como trabajadores de establecimientos mercantiles en las inmediaciones.
La Secretaría de Gestión Integral del Agua señaló que durante los trabajos que se hacían para reparar el derrame de agua en la línea de 20 pulgadas, en conjunto con autoridades de la alcaldía Benito Juárez, “la retroexcavadora impactó accidentalmente un tubo de gas, esto
provocó una explosión sin fuego”. Los servicios de emergencia controlaron la fuga de gas; sin embargo, la dependencia indicó que “los trabajos de reparación no pudieron ser concluidos debido al incidente”, por lo que sigue el desperdicio de agua y se espera acabarlos mañana. En cuanto al suministro para los residentes de la zona afectada, aclaró que “no existe afectación alguna para los usuarios, ya que no se realizaron cierres de válvulas”, con lo que “el servicio de agua potable continúa con normalidad”.
Los vecinos se percataron de lo ocurrido por el sonido que hizo la tubería de gas natural, de inmediato atendieron el llamado de dejar
En 5 años se duplicó cifra de detenidos por “apartar” lugares en la calle
ÁNGEL BOLAÑOS SÁNCHEZ
La mesa directiva del Congreso de la Ciudad de México turnó la iniciativa de la jefa de Gobierno, Clara Brugada Molina, para sancionar con arresto inconmutable de 36 horas los abusos de los franeleros, a las comisiones unidas de Administración y Procuración de Justicia, que preside el diputado de Morena Alberto Martínez Urincho, en conjunto con Justicia Cívica y Defensoría Pública, encabezada por el panista Mario Enrique Sánchez. El plazo constitucional de 10 días para que los ciudadanos propongan modificaciones a la iniciativa, a partir de su publicación en la Gaceta Parlamentaria el pasado 18 de junio, concluye el martes, por lo que las comisiones podrán iniciar la dictaminación del proyecto.
En su exposición de motivos, la propuesta refiere que la Consejería Jurídica y de Servicios Legales reportó un crecimiento de las remisiones por esa actividad de 3 mil 682 en 2019 a más de 7 mil en 2024.
Agrega que eso se sustenta porque en muchos casos las personas que apartan lugares y los ofrecen para estacionar solicitan el pago de una cuota o propina, que puede dejar de ser voluntaria bajo amenaza de causar daño al vehículo o a quien se niegue a cubrirla, lo que puede dar lugar a la actualización de los delitos de extorsión, amenazas, daño a la propiedad, robo de autopartes y lesiones.
De esa manera, esquematiza niveles de riesgo alto, medio y bajo, que en el primer caso advierte de la vinculación de los llamados franeleros con organizaciones delictivas asociadas con delitos como narcomenudeo, en tanto que según datos de la Dirección Ejecutiva de Justicia Cívica, representa una actividad económica no regulada con ingresos semanales de más de 2 millones de pesos. Antes de la sesión en la que se dio turno a la iniciativa, el PAN reclamó que la Comisión de Justicia Cívica y Defensoría Pública apareciera como codictaminadora y sea la de Administración y Procuración de Justicia como primera comisión la encargada de elaborar el proyecto de dictamen.
La presidenta de la mesa directiva, Martha Ávila, justificó la determinación por el alcance de proyecto que tiene como fin inhibir las infracciones que pudieran escalar a conductas delictivas.
La ruptura ocasionó una fuerte explosión que no dejó personas heridas
▲ La Secretaría de Gestión Integral del Agua estimó que mañana se repare la tubería dañada. Foto Víctor Camacho
sus inmuebles y se replegaron en áreas libres que indicaron bomberos y personal de protección civil. En otro caso, equipos de emergencia también se movilizaron para atender un cortocircuito en un establecimiento ubicado en la colonia 5 de Mayo, alcaldía Miguel Hidalgo, sin que se reportaran lesionados.
Mueren 3 en Azcapotzalco por intoxicación
En otros hechos, al menos tres personas murieron en un departamento de la avenida Azcapotzalco colonia San Álvaro, alcaldía Azcapotzalco, por intoxicación de gas. Los primeros reportes refieren que vecinos se percataron de un fuerte olor que provenía de uno de los departamentos, por lo que efectivos de la policía capitalina constataron la emergencia y solicitaron el arribo de bomberos y paramédicos, quienes diagnosticaron a dos mujeres de 50 y 30 años, y a un hombre de 55 años, sin signos vitales por intoxicación.
ÁNGEL BOLAÑOS SÁNCHEZ
La Secretaría de la Contraloría General no hizo observaciones a la revisión de los ingresos que tuvo la Ciudad de México durante el primer trimestre de este año, al señalar que se superaron los objetivos y metas previstos en el calendario de estimaciones de recaudación del periodo en 15.1 por ciento, con un total de 97 mil 764.8 millones de pesos, 12 mil 870.2 millones arriba de lo previsto. Este monto representa un incremento de 3.3 por ciento sobre lo obtenido en los primeros tres meses de 2024, que ascendió a 87 mil 765.2 millones de pesos, 9 mil 999.6 millones más.
El informe de control y evaluación de los ingresos que la dependencia remitió al Congreso local resalta que las percepciones tributarias superaron la estimación del
periodo enero-marzo en 18.9 por ciento, al registrar 41 mil 879.5 millones de pesos. Destaca el desempeño de los impuestos sobre el patrimonio, en particular el predial, que se estimó en 17 mil 145.7 millones e ingresaron 21 mil 784.6 millones, mientras por adquisición de inmuebles se calcularon mil 607.2 millones y entraron mil 808.7 millones.
El impuesto sobre nóminas aportó a la ciudad 13 mil 738.3 millones de pesos, 13.9 por ciento más de los 12 mil 64.7 millones previstos.
En el caso de los impuestos sobre la producción, el consumo y las transacciones, destacó el desempeño de los espectáculos públicos, con 258 millones de pesos, 125.7 por ciento más sobre la meta de 114.3 millones, y en el caso de los aprovechamientos, las multas de tránsito reportaron 479.9 millones, 83.2 por ciento arriba de los 262 millones estimados.
a los de guardias de seguridad, sin que esté capacitado para atender emergencias.
En negocios del Centro Histórico y en unidades habitacionales de la capital contratan empresas de seguridad que no cuentan con registros vigentes, lo cual genera un riesgo debido a que ahí laboran personas que no cuentan con capacitación.
Según datos de la Secretaría de Seguridad Ciudadana (SSC), existen mil 177 corporativos que ofrecen servicios que van desde vigilancia, protección de bienes y hasta traslados o custodia, así como de escoltas.
Sin embargo, el Consejo Nacional de Seguridad Privada (CNSP) refirió que en el primer cuadro de la ciudad, comerciantes y residentes contratan empresas patito, que ofrecen servicios integrales de videovigilancia, monitoreo, portería, plomería y limpieza en condominios, lo que las vuelve más atractivas.
Prestan dichos servicios y envían a personal con uniformes similares
Además, quienes realizan estos trabajos tampoco están registrados ante las autoridades correspondientes y únicamente reclutan a presuntos guardias a los que dan un tolete, el uniforme e incluso algunos les proporcionan un arma de fuego.
Según el consejo, los bajos costos de sus servicios también han sido factor para que las contraten los propietarios que buscan mejorar la imagen y la vigilancia en sus negocios y hasta en las unidades habitacionales, aunque no hay un registro en específico de estas empresas improvisadas. El CNSP detectó que las colonias donde contratan a estas empresas son variadas, pero que sectores comerciales como los del Centro Histórico, que es de los más vulnerables por la inseguridad, es donde más suelen operar.
Consultado al respecto, el presidente de Procentrhico AC, Gui-
Esas empresas ni siquiera ofrecen prestaciones básicas a sus empleados, como el servicio de salud. Foto Luis Castillo
llermo Gazal, comentó que en el primer cuadro sí se ha visto la proliferación de empresas de seguridad contratadas en plazas, locales y comercios que no están registrados ni cumplen con las regulaciones. “Al final ha sido decisión de cada empresario y comerciante contratar el servicio de seguridad que quiera. La SSC sí está dando cobertura en el Centro Histórico, pero hay empresas que por política tienen personal intramuros y las contratan, que vuelvo a repetir, sí sabemos que no todas están reguladas ni perfectamente registradas”. Un comerciante comentó que eso ocurre en el Centro, y quienes contratan más a estas empresas, incluso uniforman al personal, son los comerciantes de origen chino.
promiso político y social. La placa sustituirá la de “en este establecimiento no se discrimina”.
El gobierno y grupos empresariales de servicios pusieron en marcha una campaña contra la discriminación en establecimientos mercantiles, para lo cual se instalarán placas en casi medio millón de negocios. La primera fue develada en Parque Tepeyac, donde la jefa de Gobierno, Clara Brugada, explicó la alianza con la iniciativa privada para hacer una declaración colectiva de com-
Destacó que esto es resultado de una política pública para garantizar a los capitalinos su derecho a vivir con respeto, libertad y orgullo. La nueva placa dice: “En la Ciudad de México está prohibido negar , excluir o limitar el acceso o la prestación de servicios a cualquier persona por motivo de su color de piel, origen étnico o nacional, lengua, sexo, género, edad, discapacidad, condición
jurídica, social o económica, identidad indígena, identidad de género, apariencia física, condiciones de salud, religión, forma de pensar, orientación o preferencia sexual, por tener tatuajes, perforaciones o cualquier otra razón que tenga como propósito impedir el goce y ejercicio de sus derechos”.
La placa con la nueva frase estará en más de medio millón de negocios. Foto La Jornada


Setenta empresas ofrecen mil 200 vacantes en la Feria Nacional
ELBA MÓNICA BRAVO
La secretaria del Trabajo y Fomento al Empleo de la Ciudad de México, Inés González Nicolás, sostuvo que el principal desafío de la dependencia a su cargo es abatir la informalidad en la capital, al mencionar que 45 por ciento de la población económicamente activa está ocupada en ese sector.
Al ser entrevistada luego de encabezar la inauguración de la Feria Nacional de Empleo para la Equidad e Inclusión Laboral, comentó que el reto es remontar los logros en la creación de fuentes laborales obtenidas el año pasado en la capital; sin embargo, prefirió reservar las cifras que se tienen proyectadas para este 2025. Destacó que con la Feria Nacional de Empleo las personas podrán encontrar mil 200 vacantes que ofrecen alrededor de 70 empresas, las cuales corresponden al área de comercio, industria, servicios, seguridad y tecnología. El gobierno capitalino informó a finales del año pasado que de
enero al 12 de diciembre de 2024 se generaron 74 mil 614 nuevos empleos formales, con lo que el sector comercio habilitó 27 mil 182 trabajadores asegurados; el de servicios para empresas, personas y el hogar formalizó a 25 mil 287 personas, mientras el de servicios sociales y comunales fueron 4 mil 744 asegurados, por mencionar algunos.
A noviembre de 2024, la capital registró 3 millones 548 mil 439 personas trabajadoras afiliadas al Instituto Mexicano del Seguro Social (IMSS), con lo que la Ciudad de México lideró en esa fecha el número de empleos formales en el país. La funcionaria mencionó en su discurso que la orientación sexual, la identidad o expresión de género, el origen étnico, la edad, discapacidad o cualquier otra condición de ninguna manera deben impedir a que una persona goce de su derecho al trabajo.
González Nicolás agregó que esto “no es una concesión, no es un apoyo, es un derecho, y el trabajo debe desarrollarse en igualdad de condiciones, libre de discriminación y de violencia”, tras referir que “la feria es un espacio que también consideramos un espacio de lucha por más y mejores empleos para un grupo especial tan importante, que es el de la diversidad de las personas”.
EDICTO
Disposiciones del Juez Octavo Especializado en Materia Mercantil del Distrito Judicial de Puebla, de fechas veintinueve de septiembre de dos mil veintitrés y dos de Junio del año dos mil veinticinco, dictadas en el expediente 737/2023, Juicio Oral Mercantil, promovido por Wendy Guevara Barrientos en su carácter de apoderada legal de la moral Molino Harinero San Blas, Sociedad Anónima de Capital Variable, en contra de Francisco Gustavo Presas Sibaja. De conformidad se ordena emplazar a juicio a la parte demandada Francisco Gustavo Presas Sibaja mediante tres edictos que de forma consecutiva deberán publicarse en el periódico “LA JORNADA”, que es de cobertura nacional, y en el periódico “INTOLERANCIA”, que es de cobertura local, en términos de la resolución de veintinueve de septiembre del año dos mil veintitrés (fojas 33-35). Por lo tanto, se le concede el termino de TREINTA DÍAS, siguientes de la publicación del ultimo edicto, para que proceda a dar contestación a la demanda, con el apercibimiento que de no hacerlo, sin necesidad de acusar su rebeldía, el juicio seguirá su curso y se le tendrá por perdido el derecho que debió ejercer dentro del término corresincluyendo las personales se le harán por lista; corriéndole traslado con demanda que consta de 7 fojas; documentos fundatorios; Factura C 383790, de fecha catorce de agosto de dos mil diecinueve, constante de 1 foja, Factura C 393641, de fecha siete de octubre de dos mil diecinueve, constante de 1 foja; Constancia de Situación Fiscal a nombre de la moral acreedora, constante de 2 fojas; CURP y Credencial para votar a favor de Wendy Guevara Barrientos constantes cada uno de 1 foja; Instrumento Notarial Número 71,506, volumen 1,145, expedido a favor de la apoderada legal constante de 19 fojas, quedando a su disposición en la Secretaría de la adscripción.

Estados Unidos Mexicanos
Poder Judicial de la Federación
Cuarto Tribunal Laboral Federal de Asuntos
Individuales en el Estado de Campeche, con sede en Ciudad del Carmen EDICTO
Estados Unidos Mexicanos
Poder Judicial de la Federación
Consejo de la Judicatura Federal Quinto Tribunal Laboral Federal de Asuntos Individuales en el Estado de Campeche, con sede en Ciudad del Carmen EDICTO
García, se ordena emplazar a juicio por edictos a María Hayde Pérez, tercera inte resada en este procedimiento, en virtud de que se desconoce su domicilio, a quien se le hace saber que cuenta con el plazo de veinte días hábiles, contados a partir Quinto Tribunal Laboral Federal de Asuntos Individuales en el Estado de Campeche,
Lic. Santiago Gómez Moreno. Diligenciario Non Adscrito al Juzgado Octavo Especializado en Materia Mercantil, Puebla.



Para su publicación por 3 veces consecutivas, en el periódico “La Jornada” de cobertura nacional y en “Intolerancia” de publicación local.
En el procedimiento ordinario laboral 594/2024, promovido por Beatriz Ramírez Aguilar, se ordena emplazar a juicio por edictos a la parte demandada Osm Energía y Talento, sociedad anónima de capital variable, Offshore Marine Management de México, sociedad anónima de capital variable, Osn Energía Talento, sociedad anónima de capital variable, Hw High Wall, sociedad anónima de capital variable, Operadora de Transportes Marinos, sociedad anónima de capital variable, Seacor Marine Internacional LLC, Sindicato Industrial de Revolución y Offshore Marine Mantenimiento de México, sociedad anónima de capital variable, en virtud de que se desconoce su domicilio, a quien se hace saber que cuenta con el plazo de quince días hábiles, contados a partir del siguiente al de la última publicación del presente edicto, para que acuda a este Cuarto Tribunal Laboral Federal de Asuntos Individuales en el Estado de Campeche, con sede en Ciudad del Carmen, ubicado en calle Caballito de Mar, número 34 A, colonia Playa Norte, Ciudad del Carmen, Campeche, código postal 24115, a dar contestación a la demanda instaurada en su contra, ofrecer pruebas, oponer excepciones y, de ser el caso, reconvenir, bajo apercibimiento que, en caso de no desahogar el citado requerimiento en el plazo concedido, este Tribunal tendrá por admitidas las peticiones de la parte actora, salvo aquellas que sean contrarias a lo dispuesto por la ley, y perdido su derechos para ofrecer pruebas y formular reconvención; de igual manera, se le requiere para que proporcione domicilio dentro del lugar de residencia de este Tribunal, bajo apercibimiento que, de no hacerlo, las
Benito Flores Bello
Juez de Distrito adscrito al Cuarto Tribunal Laboral Federal de Asuntos Individuales en el Estado de Campeche, con sede en Ciudad del Carmen
JUZGADO DECIMOCUARTO DE DISTRITO EN MATERIA CIVIL EN LA CIUDAD DE MÉXICO PALACIO DE JUSTICIA FEDERAL SIDAR Y ROVIROSA ESQUINA EDUARDO MOLINA COLONIA DEL PARQUE, ALCALDÍA VENUSTIANO CARRANZA CÓDIGO POSTAL 15960 - CIUDAD DE MÉXICO ACCESO 5, PRIMER PISO, EDICTO: PARA EMPLAZAR A JUICIO A: GC GESTIÓN EN SEGURIDAD PRIVADA, SOCIEDAD DE RESPONSABILIDAD LIMITADA DE CAPITAL VARIABLE Y DANIELA ANDREA CERDA GALVÁN. En el expediente 6674/2024-P.C. relativo al JUICIO EJECUTIVO MERCANTIL, promovido por OPERADORA FALCON, SOCIEDAD ANÓNIMA PROMOTORA DE INVERSIÓN CAPITAL VARIABLE, FINANCIERA DE OBJETO MULTIPLE, ENTIDAD NO REGULADA, en contra de GC GESTIÓN EN SEGURIDAD LIMITADA DE CAPITAL VARIABLE Y DANIELA ANDREA CERDA GALVAN, del índice del Juzgado Decimocuarto de JUZGADO DÉCIMO CUARTO Distrito en Materia Civil en la Ciudad de México, y en cumplimiento a lo ordenado en auto de TREINTA DE MAYO DE DOS MIL VEINTICINCO con apoyo en lo dispuesto en el artículo 1070 del Código de Comercio, se emplaza por edictos a GC GESTIÓN EN SEGURIDAD PRIVADA, SOCIEDAD DE RESPONSABILIDAD LIMITADA DE CAPITAL VARIABLE Y DANIELA ANDREA CERDA GALVÁN, de forma que la actora reclama en su contra, las siguientes prestaciones: “I).- El pago de la cantidad de $454,997.33 (cuatrocientos cincuenta y cuatro mil novecientos noventa y siete pesos 33/100 moneda nacional), por concepto de Suerte Principal, la cual se desprende del Título de Crédito denominado Pagaré de fecha 23 de febrero de 2024, por la cantidad de $454,997.33 (cuatrocientos cincuenta y cuatro mil novecientos noventa y siete pesos 33/100 moneda nacional), suscrito por la persona moral GC GESTIÓN EN SEGURIDAD PRIVADA, S. DE R.L. DE C.V. en su carácter de Suscriptora, y la señora DANIELA ANDREA CERDA GALVÁN en su carácter de Aval, con fecha de vencimiento el día 23 de mayo de 2024. II).- El pago de los Intereses Ordinarios a una tasa de interés bruto anual igual a 33.48%, sobre el saldo de principal sentencia, tanto los que se hayan causado desde la fecha de suscripción del Título de Crédito base de la presente acción, así como los que se sigan generando hasta el día en que se dé total y cabal cumplimiento a la obligación de pago, señalando que los intereses ordinarios comenzaron a generarse a partir del día 23 de febrero de 2024.
III).- El pago de los Intereses Moratorios, a una tasa de interés bruto anual igual a la Tasa de Interés Ordinaria señalada en el Título de Crédito, multiplicada por 1.5, los tanto los que se hayan causado desde la fecha en que los hoy demandados se constituyeron en mora, como los que se sigan generando, señalando que los intereses moratorios comenzaron a generarse a partir del día 24 de mayo de 2024.
IV).- El pago de los gastos y costas que con motivo de Se le hace saber que dentro del término de TREINTA DÍAS contados a partir del día siguiente a siguiente a contestar la demanda instaurada en su contra u oponer excepciones y defensas de su parte; apercibido que de no hacerlo, precluirá su derecho para realizarlo y se le siguiéndolo en su rebeldía, para tal efecto queda a su el presente sumario, las copias del escrito inicial de demanda con anexos, con las cuales se le corre traslado, asimismo se previene al demandado para que señalecaciones aún las de carácter personal le surtirán por lista que se publique en los estrados de este Juzgado. Asimismo, dentro del término que se le ha concedido para contestar la demanda, deberá señalar bienes que desig-so, se practicarán las diligencias correspondientes ante este Juzgado de Distrito y en caso de no efectuar esa designación, el derecho pasará a la parte actora, acorde al artículo 1394 del Código de Comercio. MÉXICO, CIUDAD DE MÉXICO, A TRENTA DE MAYO
LIC. DAVID ALEJANDRO VALENCIA LEAL.
SECRETARIO DEL JUZGADO DECIMOCUARTO DE DISTRITO EN MATERIA CIVIL EN LA CIUDAD DE MÉXICO.
PARA SU PUBLICACION POR TRES VECES CONSECUTIVAS EN UN PERIÓDICO DE CIRCULACIÓN AM-
PLIA Y COBERTURA NACIONAL Y EN UN PERIÓDICO
LOCAL DE LA CIUDAD DE MÉXICO.
Estados Unidos Mexicanos Poder Judicial de la Federación Cuarto Tribunal Laboral Federal de Asuntos Individuales en el Estado de Campeche, con sede en Ciudad del Carmen EDICTO
En el procedimiento ordinario laboral 634/2024, promovido por Jesús Ernesto Sánchez Plazola, se ordena emplazar a juicio por edictos a la demandada Administradores Navieros del Golfo, sociedad anónima de capital variable, en virtud de que se desconoce su domicilio, a quien se hace saber que cuenta con el plazo de quince días hábiles, contados a partir del siguiente al de la última publicación del presente edicto, para que acuda a este Cuarto Tribunal Laboral Federal de Asuntos Individuales en el Estado de Campeche, con sede en Ciudad del Carmen, ubicado en calle Caballito de Mar, número 34 A, colonia Playa Norte, Ciudad del Carmen, Campeche, código postal 24115, a dar contestación a la demanda instaurada en su contra, ofrecer pruebas, oponer excepciones y, de ser el caso, reconvenir, bajo apercibimiento que, en caso de no desahogar el citado requerimiento en el plazo concedido, este Tribunal tendrá por admitidas las peticiones de la parte actora, salvo aquellas que sean contrarias a lo dispuesto por la ley, y perdido su derechos para ofrecer pruebas y formular reconvención; de igual manera, se le requiere para que proporcione domicilio dentro del lugar de residencia de este las de carácter personal, se harán por boletín. Ciudad del Carmen, Campeche, a 14 de mayo de 2025.
Benito Flores Bello
Juez de Distrito adscrito al Cuarto Tribunal Laboral Federal de Asuntos Individuales en el Estado de Campeche, con sede en Ciudad del Carmen
Estados Unidos Mexicanos
Poder Judicial de la Federación
Consejo de la Judicatura Federal Quinto Tribunal Laboral Federal de Asuntos Individuales en el Estado de Campeche, con sede en Ciudad del Carmen EDICTO
En el procedimiento ordinario laboral 219/2024, promovido por Armando López Olan, se ordena emplazar a juicio por edictos a las demandadas Impulso Humano RH, sociedad anónima de capital variable, e Impulso Humano, sociedad anónima de capital variable, en virtud de que se desconoce su domicilio, a quienes se les hace saber que cuentan con el plazo de veinte días hábiles, contados a partir del siguiente al de la última publicación del presente edicto, para que acudan a este Quinto Tribunal Laboral Federal de Asuntos Individuales en el Estado de Campeche, con sede en Ciudad del Carmen, ubicado en calle Caballito de Mar, número 34 A, colonia Playa Norte, Ciudad del Carmen, Campeche, código postal 24115, a dar contestación a la demanda instaurada en su contra, ofrecer pruebas, oponer excepciones y, de ser el caso, reconvenir, bajo apercibimiento que, en caso de no desahogar el citado requerimiento en el plazo concedido, este Tribunal tendrá por admitidas las peticiones de la parte actora, salvo aquellas que sean contrarias a lo dispuesto por la ley, y perdido su derecho para ofrecer pruebas y formular reconvención; de igual manera, se les requiere para que proporcionen domicilio dentro del lugar de residencia de este Tribunal, bajo apercibimiento que, de no hacerlo, las
Lorena Orquídea Cerino Moyer
Jueza de Distrito adscrita al Quinto Tribunal Laboral Federal de Asuntos Individuales en el Estado de Campeche, con sede en Ciudad del Carmen
festar lo que a su derecho estime pertinente, ofrecer pruebas, oponer excepciones en relación a la demanda de la parte actora, bajo apercibimiento que, en caso de
Lorena Orquídea Cerino Moyer
Jueza de Distrito adscrita al Quinto Tribunal Laboral Federal de Asuntos Individuales en el Estado de Campeche, con sede en Ciudad del Carmen
Estados Unidos Mexicanos
Poder Judicial de la Federación
Cuarto Tribunal Laboral Federal de Asuntos Individuales en el Estado de Campeche, con sede en Ciudad del Carmen EDICTO
En el procedimiento ordinario laboral 199/2024, promovido por Rosalio Guerrero Méndez, se ordena emplazar a juicio por edictos a la parte demandada Goimar, sociedad anónima de capital variable, y Arrendadora Cyberdrill, sociedad anónima de capital variable, en virtud de que se desconoce su domicilio, a quien se hace saber que cuenta con el plazo de quince días hábiles, contados a partir del siguiente al de la última publicación del presente edicto, para que acuda a este Cuarto Tribunal Laboral Federal de Asuntos Individuales en el Estado de Campeche, con sede en Ciudad del Carmen, ubicado en calle Caballito de Mar, número 34 A, colonia Playa Norte, Ciudad del Carmen, Campeche, código postal 24115, a dar contestación a la demanda instaurada en su contra, ofrecer pruebas, oponer excepciones y, de ser el caso, reconvenir, bajo apercibimiento que, en caso de no desahogar el citado requerimiento en el plazo concedido, este Tribunal tendrá por admitidas las peticiones de la parte actora, salvo aquellas que sean contrarias a lo dispuesto por la ley, y perdido su derechos para ofrecer pruebas y formular reconvención; de igual manera, se le requiere para que proporcione domicilio dentro del lugar de residencia de este Tribunal, bajo apercibimiento que, de no hacerlo,
Benito Flores Bello
Juez de Distrito adscrito al Cuarto Tribunal Laboral Federal de Asuntos
Individuales en el Estado de Campeche, con sede en Ciudad del Carmen
Estados Unidos Mexicanos Poder Judicial de la Federación Cuarto Tribunal Laboral Federal de Asuntos Individuales en el Estado de Campeche, con sede en Ciudad del Carmen
EDICTO
En el procedimiento ordinario laboral 18/2025, promovido por Carlos Augusto López García, se ordena emplazar a juicio por edictos a la demandada Shark Marine de México, sociedad anónima de capital variable, en virtud de que se desconoce su domicilio, a quien se hace saber que cuenta con el plazo de quince días hábiles, contados a partir del siguiente al de la última publicación del presente edicto, para que acuda a este Cuarto Tribunal Laboral Federal de Asuntos Individuales en el Estado de Campeche, con sede en Ciudad del Carmen, ubicado en calle Caballito de Mar, número 34 A, colonia Playa Norte, Ciudad del Carmen, Campeche, código postal 24115, a dar contestación a la demanda instaurada en su contra, ofrecer pruebas, oponer excepciones y, de ser el caso, reconvenir, bajo apercibimiento que, en caso de no desahogar el citado requerimiento en el plazo concedido, este Tribunal tendrá por admitidas las peticiones de la parte actora, salvo aquellas que sean contrarias a lo dispuesto por la ley, y perdido su derechos para ofrecer pruebas y formular reconvención; de igual manera, se le requiere para que proporcione domicilio dentro del lugar de residencia de este Tribunal, bajo apercibimiento que, de no hacerlo, las
Benito Flores Bello
Juez de Distrito adscrito al Cuarto Tribunal Laboral Federal de Asuntos Individuales en el Estado de Campeche, con sede en Ciudad del Carmen
LA JORNADA Jueves 26 de junio de 2025
EDICTO
DISPOSICIÓN JUEZ DE PRIMERA INSTANCIA ADSCRITO AL JUZGADO PRIMERO DE LO CIVIL DEL DISTRITO JUDICIAL DE TEHUACÁN PUEBLA, AUTOS DE FECHA VEINTIOCHO DE ABRIL Y VEINTIUNO DE MARZO AMBOS DEL AÑO DOS MIL VEINTICINCO Y VEINTIDÓS DE MARZO DEL AÑO DOS MIL VEINTICUATRO, EXPEDIENTE NUMERO 0159/2024, JUICIO EJECUTIVO MERCANTIL, PROMOVIDO POR FERNANDO SALAZAR MARTÍNEZ EN REPRESENTACIÓN DE BANCO MERCANTIL DEL NORTE, SOCIEDAD ANÓNIMA, INSTITUCIÓN DE BANCA MÚLTIPLE, GRUPO FINANCIERO BANORTE, EN CONTRA DE JESSICA LOZANO RODRÍGUEZ EN SU CARÁCTER DE ACREDITADA, ORDENA EMPLAZAR A LA PARTE DEMANDADA JESSICA LOZANO RODRÍGUEZ EN SU CARÁCTER DE ACREDITADA PARA QUE EN EL TÉRMINO DE OCHO DÍAS CONTADOS A PARTIR DE LA ÚLTIMA PUBLICACIÓN, DÉCONTESTACIÓN A LA DEMANDA, DEBIENDO HACER VALER SUS EXCEPCIONES Y DEFENSAS QUE ESTIME PERTINENTES CONFORME LO DISPONEN LOS PRECEPTOS LEGALES 1075 PÁRRAFO TERCERO DEL CÓDIGO DE COMERCIO, QUEDANDO A SU DISPOSICIÓN EN LA SECRETARÍA NON DEL JUZGADO COPIAS DE LA DEMANDA, DE LOS DOCUMENTOS FUNDATORIOS Y ANEXOS; SI NO DA CONTESTACIÓN A LA DEMANDA EN EL TÉRMINO CONCEDIDO PARA ELLO Y SIN QUE MEDIE PETICIÓN DE PARTE, SE/PROCEDERÁ EN LOS TÉRMINOS DEL ARTÍCULO 1390 BIS 20.
TEHUACÁN PUEBLA A VEINTIOCHO DE MAYO DEL AÑO DOS MIL VEINTICINCO. LIC. MARIBEL FERNANDEZ BECERRA
AVISO NOTARIAL SEGUNDA PUBLICACIÓN Ixtapaluca, Estado de México a 29 de mayo de 2025 En cumplimiento a lo dispuesto por el artículo setenta del Reglamento de la Ley del Notariado del Estado de México, HAGO CONSTAR: Que por escritura número TRECE MIL CIENTO CUARENTA Y OCHO, otorgada ante mí el día veintitrés de abril de dos mil veinticinco y a solicitud de los señores ROSARIO SANDOVAL ESTRADA, MARIA LUISA RAMÍREZ SANDOVAL, HILDA RAMÍREZ SANDOVAL, ANTONIO RAMÍREZ SANDOVAL, GUILLERMINA RAMÍREZ SANDOVAL, VALENTE RAMÍREZ SANDOVAL y FRANCISCO RAMÍREZ SANDOVAL, la primera de los mencionados en su carácter de cónyuge supérstite y los demás descendientes en primer grado (hijos) del autor de la citada sucesión, RADIQUE EN LA NOTARIA A MI CARGO, PARA SU TRAMITACION EXTRAJUDICIAL, LA SUCESIÓN INTESTAMENTARIA a bienes del señor VALENTE RAMÍREZ TREJO, declarando los solicitantes bajo protesta de decir verdad que no tienen conocimiento de que existan otras personas con derecho a heredar en la presente sucesión. De lo anterior para su publicación en dos ocasiones con un intervalo de siete días hábiles entre una y otra.
LIC. FRANCISCO MALDONADO RUIZ NOTARIO PÚBLICO 127 DEL ESTADO DE MEXICO.
Sedatu dará a 150 mil mujeres documentos de propiedad de tierra
En el país menos de tres de cada 10 personas titulares de derecho sobre la tierra y propiedad social son mujeres y una de cada cuatro que están a cargo de las parcelas poseen algún documento que acredite la tenencia, expuso Edna Vega Rangel, titular de la Secretaría de Desarrollo Agrario, Territorial y Urbano (Sedatu), quien destacó que las
mujeres que habitan localidades rurales son las responsables de 50 por ciento de la producción de alimentos. En la firma de un convenio de colaboración para garantizar a las mujeres del campo su derecho al acceso a las tierras, se indicó que en el gobierno de la presidenta Claudia Sheinbaum 150 mil serán reconocidas como propietarias. Al respecto, Vega Rangel dijo que existe la posibilidad de que incluso se supere ese número y se tengan en 2030 entre 200 o 250 mil.
Carolina Gómez Mena
Estados Unidos Mexicanos Poder Judicial de la Federación Cuarto Tribunal Laboral Federal de Asuntos Individuales en el Estado de Campeche, con sede en Ciudad del Carmen
En el procedimiento ordinario laboral 803/2024, promovido por Gabriel Iván Gómez Peralta, se ordena emplazar a juicio por edictos a la demandada Imssco Offshore Services, sociedad anónima de capital variable, e Impulsora Marítima de Soporte y Servicios Costa Afuera, sociedad anónima de capital variable, en virtud de que se desconoce su domicilio, a quien se hace saber que cuenta con el plazo de quince días hábiles, contados a partir del siguiente al de la última publicación del presente edicto, para que acuda a este Cuarto Tribunal Laboral Federal de Asuntos Individuales en el Estado de Campeche, con sede en Ciudad del Carmen, ubicado en calle Caballito de Mar, número 34 A, colonia Playa Norte, Ciudad del Carmen, Campeche, código postal 24115, a dar contestación a la demanda instaurada en su contra, ofrecer pruebas, oponer excepciones y, de ser el caso, reconvenir, bajo apercibimiento que, en caso de no desahogar el citado requerimiento en el plazo concedido, este Tribunal tendrá por admitidas las peticiones de la parte actora, salvo aquellas que sean contrarias a lo dispuesto por la ley, y perdido su derechos para ofrecer pruebas y formular reconvención; de igual manera, se le requiere para que proporcione domicilio dentro del lugar de residencia de este Tribunal, bajo apercibimiento que, de boletín. Ciudad del Carmen, Campeche, a 5 de junio de 2025.
Benito Flores Bello
Juez de Distrito adscrito al Cuarto Tribunal Laboral Federal de Asuntos Individuales en el Estado de Campeche, con sede en Ciudad del Carmen
Editorial
Sigue el incumplimiento constitucional de la Secretaría de Hacienda en dar a los
RICARDO GUZMÁN WOLFFER
INTEGRADA LA NUEVA
Suprema Corte de Justicia de la Nación luego de la votación judicial, será de poca utilidad señalar las inconsistencias del proceso electoral. A diferencia de otras candidaturas, los nuevos ministros no pasarán por el reclamo de otro candidato alegando mayor votación para ocupar esa plaza. La lealtad política a las fuerzas fácticas del partidismo oficial dio resultado. La politización de tales nombramientos y la necesidad de no cerrarse posibilidades políticas futuras puede advertirse como razón en algunos candidatos para aceptar su derrota.
COMO SUCEDE EN cargos legislativos, lo importante es llegar al puesto, no desempeñarse adecuadamente. Si para los diputados es fácil esconderse entre cientos de curules, lo mismo sucede con los nuevos ministros, cuyos planes de trabajo no se han hecho públicos, si es que los
juzgadores que renunciaron a ser candidatos judiciales el pago indemnizatorio ordenado
hay. Lo más relevante ha sido la indumentaria de los ministros, sin adelantar la prometida transparencia. Cobrarán más que casi todos los funcionarios judiciales, pero ni remotamente trabajarán lo mismo que un secretario de juzgado o que un notificador; esto a pesar de los miles de expedientes que les esperan. Las decenas de asesores que cada ministro tiene apenas serán el cono mayor del embudo que se cerrará en las decisiones de cada ministro. Previsiblemente, los juicios que sean de interés público tendrán escasas discusiones en las sesiones públicas, simplemente resolverán en favor de proyectos políticos, pero habrá miles de asuntos sin interés para el oficialismo y donde, ojalá, sea necesario revisar la ley para dictar sentencia.
SI HACIA AFUERA la próxima Corte apenas dará sorpresas, hacia adentro se hará eco de la división partidista que puede advertirse en las declaraciones de los líderes grupales. En breve se harán equipos para manejar los
Profepa frustra envíos ilegales de especies a países asiáticos
En el Día Internacional contra el Tráfico Ilegal de Fauna Silvestre, la Procuraduría Federal de Protección al Ambiente (Profepa) aseguró ayer que en meses recientes se frustraron envíos ilícitos de especies hacia Tailandia, Japón, China y Laos, entre otros países. En un video, Mariana Boy, titular de la Profepa, detalló que se han resca-
tado miles de ejemplares, como sitácidos y primates, que eran traficados en empresas de mensajería o en las carreteras nacionales. Resaltó que se han retirado miles de metros de redes de pesca ilegales en el Alto Golfo de California para frenar el tráfico de la totoaba, que también afecta a la vaquita marina. Asimismo, apuntó que la Profepa ha publicado campañas de sensibilización para pedir a la ciudadanía a no comprar, regalar ni tener animales de vida silvestre. De la Redacción
Estados Unidos Mexicanos Poder Judicial de la Federación
Cuarto Tribunal Laboral Federal de Asuntos Individuales en el Estado de Campeche, con sede en Ciudad del Carmen
EDICTO
En el procedimiento ordinario laboral 631/2024, promovido por Pedro José Chapa Escobedo, se ordena emplazar a juicio por edictos a la demandada Administradores Navieros del Golfo, sociedad anónima de capital variable, en virtud de que se desconoce su domicilio, a quien se hace saber que cuenta con el plazo de quince días hábiles, contados a partir del siguiente al de la última publicación del presente edicto, para que acuda a este Cuarto Tribunal Laboral Federal de Asuntos Individuales en el Estado de Campeche, con sede en Ciudad del Carmen, ubicado en calle Caballito de Mar, número 34 A, colonia Playa Norte, Ciudad del Carmen, Campeche, código postal 24115, a dar contestación a la demanda instaurada en su contra, ofrecer pruebas, oponer excepciones y, de ser el caso, reconvenir, bajo apercibimiento que, en caso de no desahogar el citado requerimiento en el plazo concedido, este Tribunal tendrá por admitidas las peticiones de la parte actora, salvo aquellas que sean contrarias a lo dispuesto por la ley, y perdido su derechos para ofrecer pruebas y formular reconvención; de igual manera, se le requiere para que proporcione domicilio dentro del lugar de residencia de este Tribunal, carácter personal, se harán por boletín. Ciudad del Carmen, Campeche, a 25 de abril de 2025.
Benito Flores Bello
Juez de Distrito adscrito al Cuarto Tribunal Laboral Federal de Asuntos Individuales en el Estado de Campeche, con sede en Ciudad del Carmen
en la Constitución Federal. Si la intención era incumplir, era innecesaria la promesa legal.
amplios recursos que para muchos de los nuevos funcionarios serán una agradable sorpresa, así como la posibilidad de disponer de las muchas plazas judiciales, donde puede anticiparse la preferencia partidista sobre la carrera judicial.
TODAS LAS RESOLUCIONES judiciales son públicas, tanto las sentencias como los acuerdos. Varios observatorios ciudadanos estarán pendientes del desempeño de la Corte. No es necesario haber sido parte de los votantes para tener derecho a conocer el desempeño judicial. Los ministros deberán responder a la ciudadanía, sin distinguir entre votantes o integrantes del abstencionismo.
“UNA REFORMA LABORAL con zapatos viejos” de Manuel Fuentes Muñiz (Arkhé ediciones, México 2024) es un compendio de ensayos hechos por un litigante laboralista de décadas. En parte un libro para conocer la historia
de la situación jurisdiccional laboral en México, los ensayos son propicios para conocer la realidad del servicio de administración de justicia laboral. Si en su momento el tema laboral parecía ser decisivo para la firma del acuerdo comercial entre México, Estados Unidos y Canadá, es claro que pronto será motivo de análisis para continuar con ese tratado comercial; máxime ante los malos resultados por parte de las juntas de conciliación y arbitraje, de los nuevos jueces orales laborales y del centro federal de conciliación. El abandono del tribunal federal de conciliación y arbitraje es significativo del desinterés estatal por los burócratas federales, como sigue hasta el momento.
FUENTES DOCUMENTA LAS reducciones presupuestales que desde hace años se dan en detrimento de la solución de conflictos laborales. Los trabajadores mexicanos parecen no ser importantes en la administración de justicia: se cierran juntas laborales, se abren juzgados orales laborales insuficientes, se
Sugerencias y colaboraciones: agendajudicial@jornada.com.mx. https://agendajudicialricardoguzmanwolffer.blogspot.com/


limitan salarios y encima se tilda de corruptos a todos los jueces laborales para cambiarlos, apenas completada la “curva de aprendizaje”. Los jueces electos llegarán a aprender la diferencia entre bailar en tik-tok y resolver cientos de acuerdos todos los días. Fuentes documenta el engaño. La reforma laboral no ha mejorado la impartición de justicia laboral.
ESCUCHE LOS PODCASTS “Voltaire vivo” y “Sociedad quebrada” en “Literatura y derecho” de Ricardo Guzmán Wolffer en Spotify y plataformas afines.
Rayuela
Todo lo que hay que hacer –posible o imposible– con tal de quedarse Estados Unidos con el negocio del narcotráfico en México. www.jornada.com.mx
OPINIÓN
Liliana García Sánchez 15
Mario Patrón 15
Tatiana Coll 16
Abraham Nuncio 16
John Saxe-Fernández 20
Vilma Fuentes Cultura
COLUMNAS

l En conjunto con la SRE, descalifica señalamientos de comité de la ONU
l Se combate el delito y se atiende a los familiares de víctimas, indican
l El organismo internacional pide a México informar sobre este asunto
l Gobierno federal ofrece cooperar con Naciones Unidas
línea A, pues en la calzada Zaragoza cientos de usuarios vivieron momentos de caos para abordar transporte alterno. Foto V. Camacho E. BRAVO / P 30 E. OLIVARES, A. SÁNCHEZ, J. XANTOMILA Y J. LAURELES / P 10
Zohran Mamdani vence en primarias demócratas a favorito ex gobernador
l Sorprende migrante musulmán y socialista a quien Trump llama “comunista lunático”
DAVID BROOKS Y JIM CASON, CORRESPONSALES / P 25
El atentado, a la medianoche del martes Ataque en Irapuato deja 11 muertos y 20 heridos
l Irrumpen sicarios en fiesta del Día de San Juan
CARLOS GARCÍA, CORRESPONSAL / P 27
Dinero
Enrique Galván Ochoa 6
Astillero
Julio Hernández López 8
México SA
Carlos Fernández-Vega 22
Chavos, asiduos a funciones del Inbal Resurge la ópera con salas llenas y boletos agotados
l Es más barata que ir al futbol o a un concierto
ÁNGEL VARGAS / CULTURA

▲ El descendiente de indios y nacido en Uganda hace 33 años sacudió no sólo a Nueva York, sino a todo Estados Unidos, con un triunfo sobre
la figura nacional demócrata financiada por multimillonarios y respaldada por la cúpula política y mediática de la ciudad más grande del país. Foto Afp